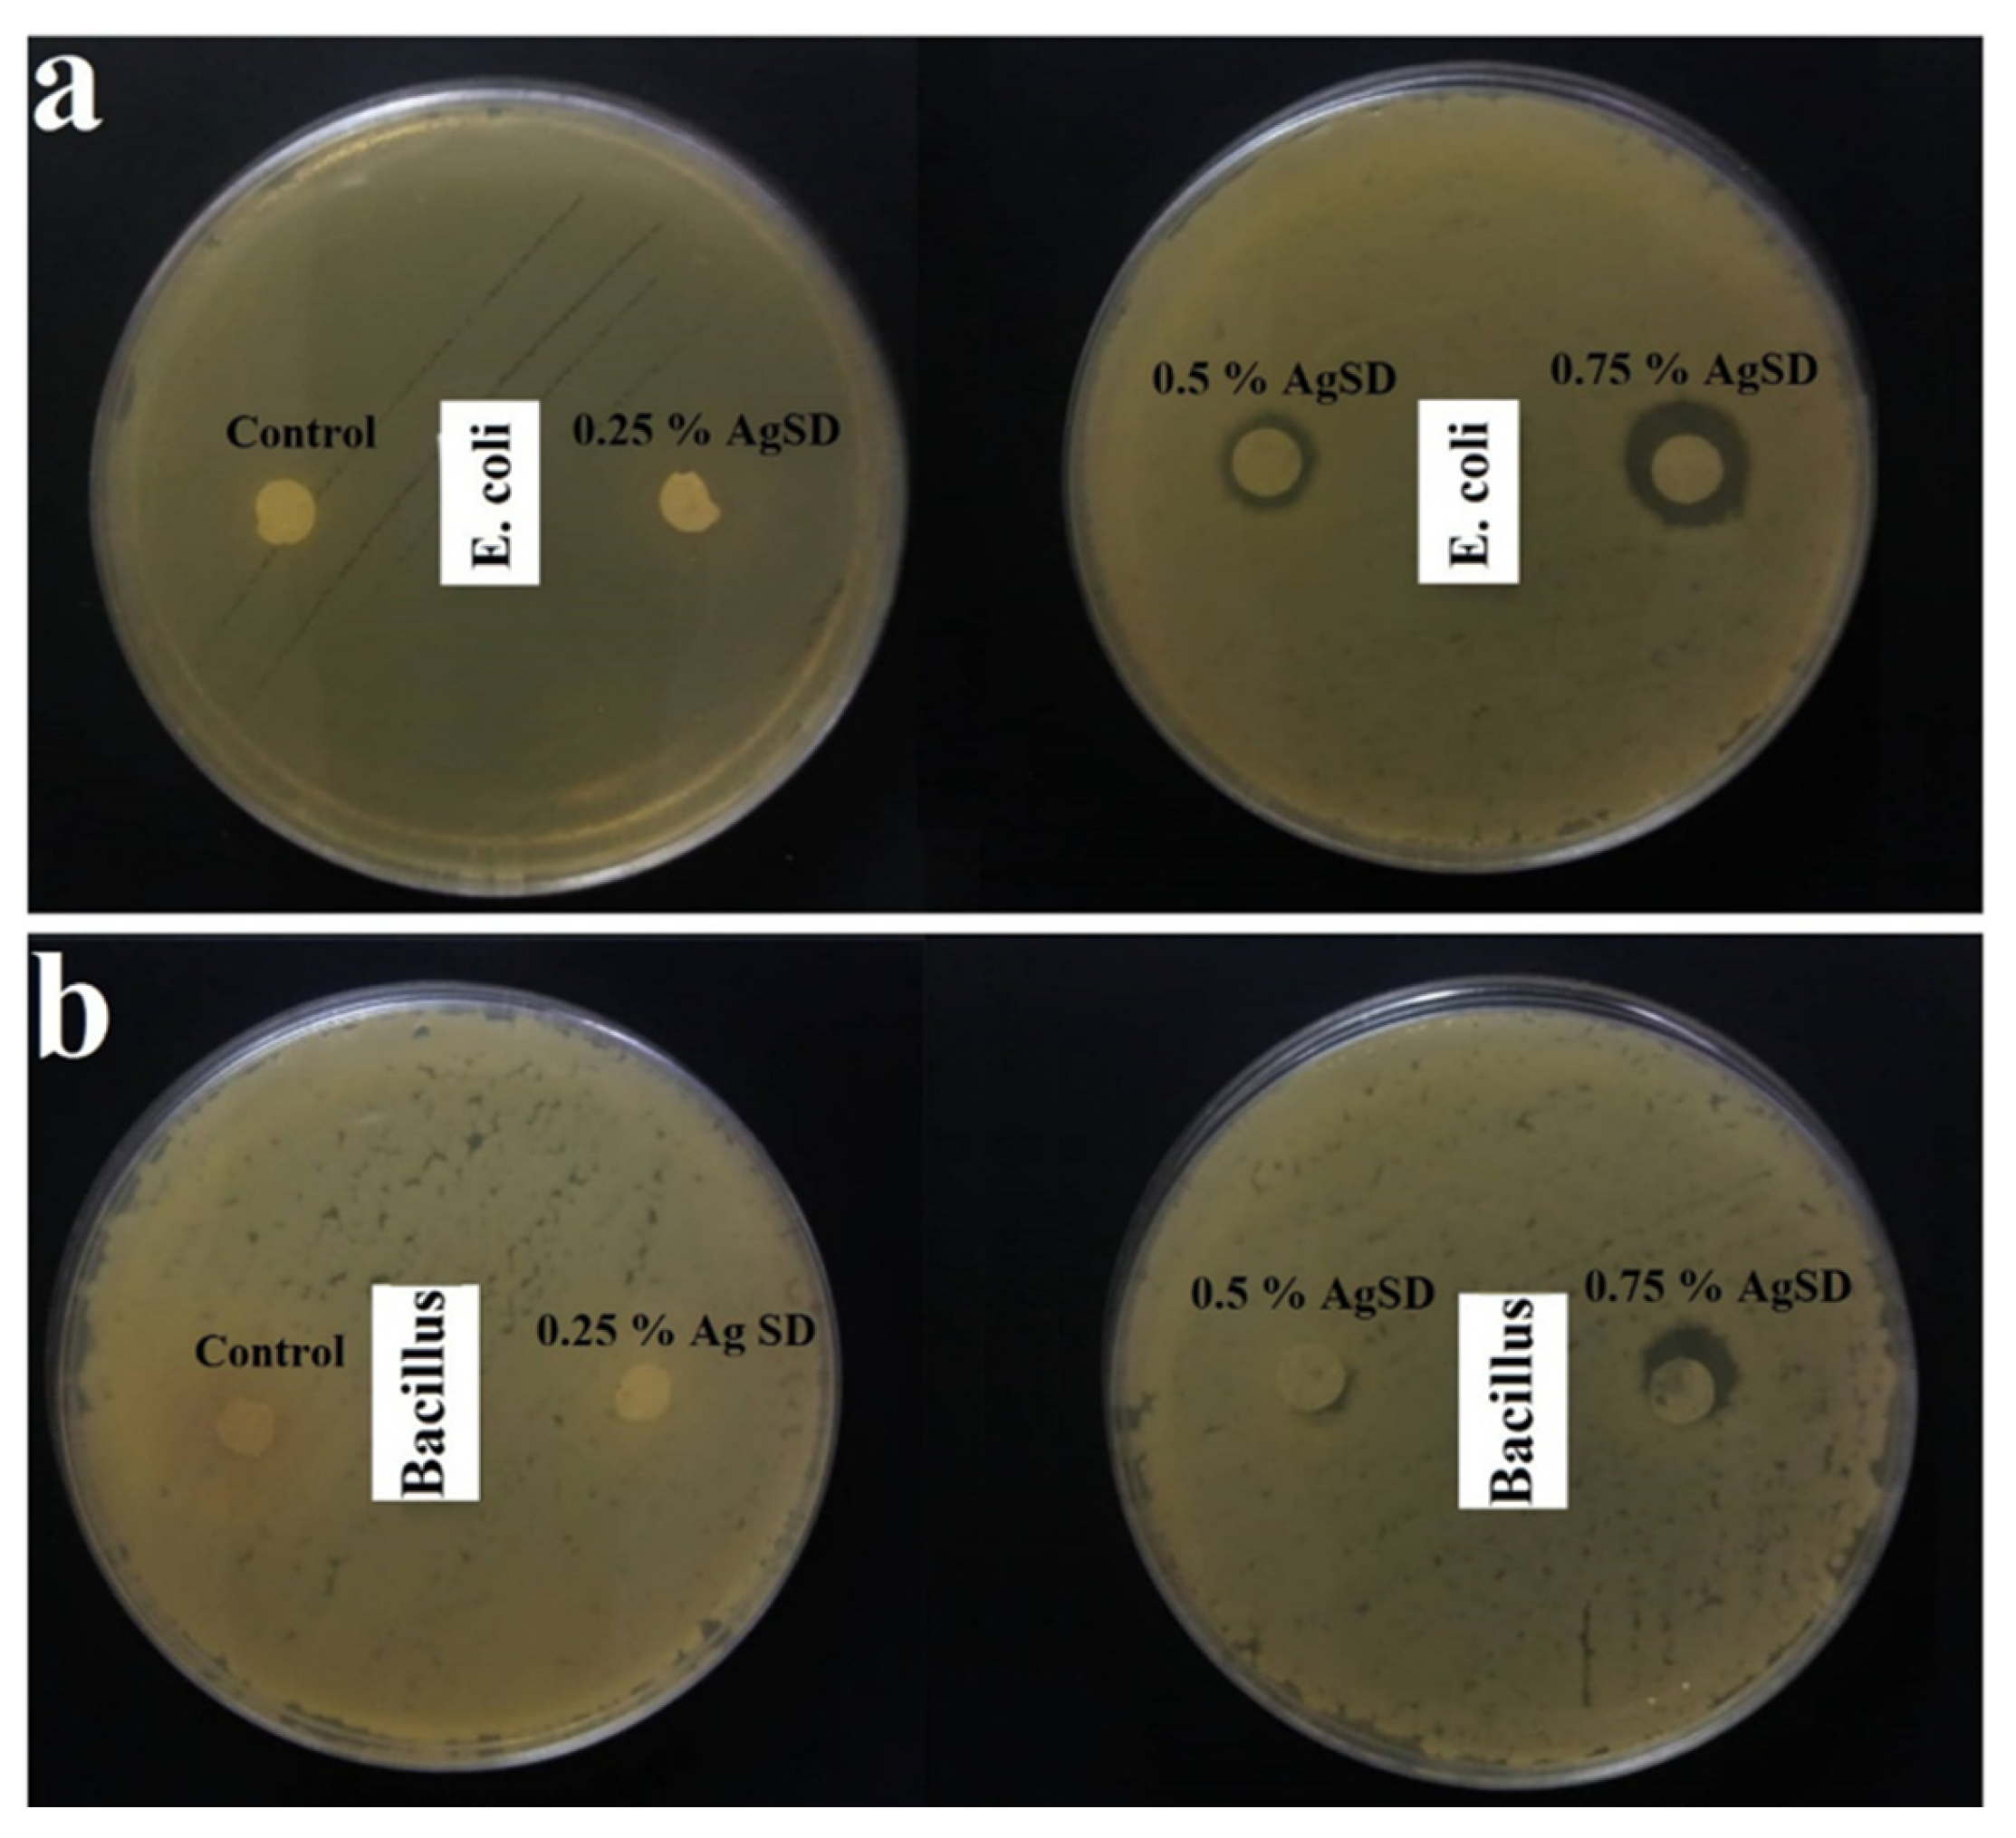
Fibers 13 00100 g016

Abstract
Wound dressings prevent complications such as infections and potentially severe outcomes, including death, if wounds are left untreated. Wound dressings have evolved from rudimentary coverings made from natural materials to sophisticated, functionalized dressings designed to enhance wound healing and support tissue repair more effectively. These materials are often referred to as scaffolds in the literature, with wound dressing scaffolds intended to interact with native skin tissue and support tissue regeneration, whereas conventional wound dressings are designed primarily to protect the wound without directly interacting with the underlying tissue. However, there is a functional overlap between these categories, and the boundary is often blurred due to the increasing multifunctionality of modern wound dressings. This review will focus on developing wound dressings (scaffolds or not) based on fibers, their properties, and applications. Advances in nanomedicine have highlighted significant improvements in wound care by applying electrospun nanofibers that mimic the natural extracellular matrix. Therefore, this review explores recent advances in wound healing physiology, highlights nanofiber-based wound dressing materials developed through electrospinning, and distinguishes conventional dressings from multifunctional wound dressing scaffolds.
1. Introduction
Electrospun fibers are gaining attention in the advancement of wound dressings. Their high surface area and surface-to-volume ratio make them outstanding platforms compared to conventional fibers. Electrospun fibers are created from polymer solutions or melts, often resulting in nanoscale fibers with appropriate mechanical and biological properties [1].
Synthetic biopolymers are materials used to build matrices for fiber fabrication due to their superior mechanical properties compared to natural biopolymers. However, these materials present limitations. For instance, synthetic polymers such as polyesters are often hydrophobic and lack adequate biocompatibility because they do not mimic extracellular matrix (ECM) components, such as polysaccharides, glycosaminoglycans, and proteoglycans [2].
On the other hand, natural biopolymers, such as proteins and polysaccharides, provide biocompatibility by mimicking the chemical composition of the extracellular matrix of tissues [3]. Nevertheless, they often fail to produce durable fibers due to their limited mechanical properties and water solubility. Therefore, a common strategy is to combine natural and synthetic biopolymers to form polymer blends [2]. Alternatively, synthetic polymers can be electrospun and subsequently functionalized with natural biopolymer coatings, or water-soluble biopolymers can be electrospun and then crosslinked to achieve stability and applicability [3,4,5,6,7].
The main challenge is modulating wound dressings’ biocompatibility and mechanical properties [8,9,10]. Another critical challenge is the development of wound dressings with antimicrobial activity. This property often requires incorporating additives, especially metallic compounds, drugs, or surfactants [5,6]. Electrospun fiber-based wound dressings must exhibit antimicrobial properties, as wounds are entry points for bacteria into the body and may lead to severe infections [11,12,13,14,15].
An effective electrospun wound dressing should meet several critical criteria: (1) possess antimicrobial activity, (2) have desirable mechanical properties, and (3) exhibit biocompatibility to support cell growth and tissue repair [16,17,18,19]. Therefore, this review highlights recent advancements in developing electrospun wound dressings to achieve these three required properties. Section 2 presents the fundamental aspects of wound healing and material requirements; Section 3 discusses the role and importance of wound dressings; Section 4 focuses on fiber production and explains why electrospun fibers are promising candidates for wound dressing applications; Section 5 highlights the main synthetic and natural polymers used to produce electrospun fibers with the necessary properties for wound healing; Section 6 provides a classification of nanofiber-based wound dressings; Section 7 explores the application of nanofiber dressings for different types of wounds; Section 8 reviews current clinical trials; Section 9 discusses limitations and critical challenges in the field; Section 10 presents the conclusions, and Section 11 outlines future trends and directions for research.
2. Fundamental Aspects
2.1. Skin Structure
The assessment of a wound’s severity can be achieved through an understanding of the skin’s structure, the epidermis, dermis, and hypodermis (Figure 1) [4,5]:
Figure 1.
Structure of human skin, composed of three main layers, including the epidermis (outermost layer), the dermis (middle layer), and the hypodermis (deepest layer). Reprinted from Ref. [4].
- Epidermis: It is the outermost layer of the skin, comprising keratinocytes, melanocytes, Merkel cells, and Langerhans cells. These cells play crucial roles in protection, pigmentation, sensation, and immune response.
- Dermis: It lies just beneath the epidermis and includes sweat glands, hair follicles, sebaceous glands, and an extensive network of lymphatic and blood vessels. These components support the skin’s flexibility and resilience, allowing it to withstand pressure and stress.
- Hypodermis: It is not technically part of the skin; the hypodermis, or subcutaneous tissue, occurs below the dermis. It consists of fibroblasts, adipocyte cells, macrophages, and nerves. This layer connects the dermis to essential muscles and bones, providing structural support and insulation.
Understanding these layers is essential for evaluating wound characteristics and guiding appropriate treatment strategies.
2.2. Skin Damage
Skin damage can arise from physical, thermal, electrical, or mechanical sources, resulting in wounds that disrupt the function and anatomical structure of the skin. These factors influence the classification of wounds, including healing time, depth, causative agents, and the mode of injury (Figure 2) [6,20,21,22,23]:
Figure 2.
Different classifications of wounds based on the healing duration, wound depth, complexity, cause, contamination, type of injury, and wound tissue.
I. Healing Time and Wound Types
- Acute Wounds: These often result from injury, burns, and surgery and are expected to heal within eight to twelve weeks, depending on the wound’s size and severity. Acute wounds are classified into traumatic and surgical.
- Chronic Wounds: These heal within twelve weeks or more. Chronic wounds are often associated with poor blood flow, diabetes, persistent local pressure, tumors, infections, or compromised blood circulation. Common types of chronic wounds include bedsores (pressure ulcers), diabetic ulcers, and foot ulcers.
II. Depth of Wounds: Wounds can also be classified based on their depth:
- Superficial Wounds: Affect only the epidermis.
- Deep Dermal Wounds: Extend into the dermis.
- Full-Thickness Wounds: Penetrate through the epidermis and dermis, reaching the hypodermis.
III. Causative Agents: Wounds are further categorized by their causative agents:
- Traumatic Wounds: Result from external force or injury.
- Iatrogenic Wounds: Arise from medical procedures or interventions.
- Burns: Caused by exposure to heat, chemicals, or electrical sources.
IV. Wound Classification by Cleanliness: Based on postoperative infection risk, wounds are classified into four categories [24,25,26]:
- Clean Wounds (Class 1): Incisions made under sterile conditions with minimal risk of infection.
- Clean/Contaminated Wounds (Class 2): Surgical wounds that involve organs or systems where contamination is controlled.
- Contaminated Wounds (Class 3): Wounds with a higher risk of infection due to exposure to contaminants.
- Dirty Wounds (Class 4): Wounds with established infection or significant contamination.
V. Mode of Injury: Wounds are also classified by the mode of injury:
- Abrasion: Superficial damage where the skin is scraped or rubbed off.
- Incision: Clean, straight cuts typically made by sharp objects.
- Laceration: Irregular, jagged tears in the skin.
- Degloving: Severe injury where the skin is peeled away from the underlying tissue.
VI. Color of Contaminated Tissue: The appearance of the wound can also be categorized by the color of the tissue present [4,5,6,7]:
- Black (Necrotic Tissue): Indicates dead tissue that must be removed for healing to progress.
- Green (Infected Tissue): Signifies the presence of infection.
- Yellow (Sloughy Tissue): Characterized by a moist, yellowish tissue often associated with inflammation or infection.
- Red (Granulating Tissue): Represents healthy new tissue forming in the healing process.
- Pink (Epithelial Tissue): Indicates newly formed skin tissue covering the wound.
Understanding these classifications aids in effectively assessing and managing wounds, guiding appropriate treatment strategies to optimize healing and recovery.
2.3. Wound Infection and Pain
Microorganisms, such as bacteria and fungi, can significantly impair the host’s natural immune system and induce infections in injured areas. Streptococcus pyogenes (S. pyogenes), Staphylococcus aureus (S. aureus), Pseudomonas aeruginosa (P. aeruginosa), and particularly Clostridium species are prominent bacterial pathogens that cause delayed wound healing. Additional factors contributing to wound infection include hypoxia, ischemia, and immune deficiencies, which may be induced by viral infections or chemotherapy [27].
Neglecting proper wound care can lead to severe consequences, including fatalities resulting from bacteremia and septicemia [28]. In healthy individuals, microorganisms may proliferate on the surface of a wound without eliciting an immune response or clinical symptoms. However, when the colonization of microorganisms penetrates the host’s living tissues, a series of local and systemic responses is triggered [29]. This invasion can result in purulent discharge, symptomatic cellulitis, and subsequent soft tissue injury [30].
It has been documented that the formation of bacterial biofilms is a critical factor in delayed wound healing, attributed to the high microbial load at the wound site [29]. Burn wounds, in particular, are highly susceptible to contamination, with approximately 75% of such wounds being prone to infection. This susceptibility is due to microorganisms already present in sebaceous glands and hair follicles, and the frequent presence of P. aeruginosa and S. aureus [31].
Chronic wounds are more vulnerable to infection compared to acute wounds. This increased susceptibility occurs due to leukocyte migration and reduced phagocytic activity in the presence of microbial biofilm [32]. The infections and biofilm in chronic wounds impart a challenging environment for effective healing, necessitating medical interventions and antibiotics to treat infections.
Effective pain management is essential for the patient’s recovery. Excessive pain can impede the healing process by causing the accumulation of stress hormones induced by anxiety, resulting in prolonged physical and mental burdens and extended hospital stays [33]. It is essential to address each patient’s expression of pain individually, as pain perception varies greatly and is subjective, rather than relying solely on clinical assessments.
There are two primary types of wound pain: nociceptive and neuropathic pain. Nociceptive pain is a natural physiological response to tissue damage. This type of pain typically resolves within a specific period; however, the inflammatory response may be prolonged if the healing process is delayed. In such cases, patients may experience primary hyperalgesia (heightened sensitivity at the wound site) and secondary hyperalgesia (increased sensitivity in the surrounding tissues) [34].
On the other hand, neuropathic pain is associated with nerve damage, which may occur due to a primary lesion. This pain is primarily linked with infections and cancer and can result in chronic pain over an extended period [35]. Skin transplants can also cause severe pain because of the exposure of nerve endings during skin harvesting, necessitating management at the wound sites [36].
Primary hyperalgesia, caused by prolonged inflammation or repeated stimuli to the wound and surrounding area, may be treated with a combination of nonsteroidal anti-inflammatory drugs (NSAIDs) and mild opioids [35]. NSAIDs reduce local inflammation, while opioids modulate pain at the spinal cord level. Wound dressings serve two fundamental functions: covering the wound to prevent infection and alleviating pain by reducing the bacterial contact and the inflammatory response [36].
Topical drug delivery to the wound site is preferred for pain alleviation, as oral medications can take several days to provide significant relief. Ibuprofen, in particular, has been extensively studied for its local pain reduction effects [37]. Arapoglou et al. (2011) designed a foam dressing loaded with ibuprofen and compared its effects with local best practices on various wound types [38]. Based on patient scores, their study reported significantly higher pain relief with ibuprofen-loaded foam dressings. They concluded that ibuprofen should be applied to acute and chronic wounds for pain reduction, indicating that pain relief with ibuprofen could be an alternative to pain treatments [38].
2.4. Wound Healing Stages
Wound healing progresses through four stages: hemostasis, inflammation, proliferation, and remodeling (Figure 3). Understanding these stages is important to identify factors that can prevent healing:
Figure 3.
Wound healing steps: (a) hemostasis step, (b) inflammation step, (c) proliferation step, (d) remodeling step. Reprinted from Ref. [39].
2.4.1. Hemostasis
This is the immediate response to injury, crucial for halting blood loss and maintaining the function of other organs. This phase involves the formation of a temporary scaffold plug (Figure 3a). The process begins with microvascular lesions, leading to vasoconstriction mediated by neuronal reflexes, which minimize blood loss from the arterioles. The initial response to skin injury involves the accumulation of thrombocytes (platelets) and inflammatory cells, which adhere to structural proteins such as collagen within the extracellular matrix [39]. Thrombocytes release a range of proteins, including thrombospondin, von Willebrand factor (vWF), sphingosine-1-phosphate, and fibronectin. These proteins enhance platelet activation and the subsequent release of growth factors such as insulin-like growth factors (IGF), platelet-derived growth factor (PDGF), interleukin 1 (IL-1), and transforming growth factors (TGF-α and TGF-β). These factors are essential for wound healing beyond the hemostatic phase. The secretion of clotting factors promotes the deposition of a fibrin matrix, stabilizing the temporary scaffold plug [40]. This scaffold provides an environment for the subsequent stages of healing by facilitating the recruitment of fibroblasts, leukocytes, keratinocytes, and endothelial cells. It serves as a reservoir of growth factors. Additionally, by releasing chemical signals, thrombocytes influence the migration of leukocytes from blood vessels to the injury site. Research by Zhang et al. explored the drug release properties of captopril-loaded poly (lactic-co-glycolic acid) (PLGA) biodegradable nanofibers. Captopril is known for its vasodilatory effects, which can further support the hemostatic and healing processes [41].
2.4.2. Inflammation
It plays a critical role in wound healing by recruiting leukocytes to the injury site by activating various mediators and chemotactic factors. This phase typically spans 24 to 48 h post-injury, with the complete resolution of inflammation generally occurring within three days. Critical signs of inflammation include the release of enzyme-filled fragments by mast cells, such as histamine. Histamine acts as a mediator by inducing vasodilation, facilitating the efficient migration of neutrophils to the wound site, as illustrated in Figure 3b. The increased blood flow and swelling observed at the wound site indicate inflammation resulting from the accumulation of interstitial fluid. Neutrophils, the primary responders in the inflammation phase, work to eliminate foreign bodies, pathogens, dead cells, and damaged matrix components through phagocytosis [42]. They also release proteinases and antimicrobial substances to cleanse the wound further. Thrombocytes release chemical signals that attract neutrophils to the injury site, promoting their adherence to endothelial cells and facilitating their migration via cell adhesion molecules. Following 48 h of injury, cytokines, growth factors, and chemokines stimulate the migration of monocytes and lymphocytes, which differentiate into macrophages. Macrophages are crucial in phagocytosing surviving pathogens, necrotic tissue, and debris, initiating granulation tissue formation. While macrophages and neutrophils are involved in clearing debris, macrophages are more effective in proteolytic degradation. Macrophages and inflammatory cytokines (e.g., TNF-α, transforming growth factor-beta (TGF-β), and platelet-derived growth factor (PDGF)) produce growth factors (e.g., vascular endothelial growth factor (VEGF), transforming growth factor-alpha (TGF-α), hepatocyte growth factor (HGF), and others) that are essential for the subsequent proliferation phase and growth of fibroblasts, endothelial cells, and other cell types after an inflammation response. The phagocytosis of neutrophils by macrophages and the subsequent reduction in inflammatory cells signal the transition to the proliferation stage [40]. Research by Merrell et al. demonstrated that curcumin-loaded polycaprolactone (PCL) nanofibers present potential for wound dressing applications [43]. Curcumin is noted for its antioxidant, antimicrobial, and anti-inflammatory properties, enhancing wound healing.
2.4.3. Proliferation
The proliferation phase of wound healing transforms the temporary scaffold plug into a more durable tissue plug, encompassing sub-stages such as angiogenesis, tissue formation, re-epithelialization, and wound contraction (Figure 3c).
- Angiogenesis: Involves the formation of new blood vessels. Endothelial cells bind to growth factors via their receptors, initiating the migration and proliferation of these tissues. The basal lamina must be dissolved by proteolytic enzymes released by the activated endothelial cells, a process known as sprouting. These sprouts form interconnected channels, which are stabilized by smooth muscle cells and pericytes [44]. Once blood flow is established, angiogenesis is considered complete. This process supplies the wound with oxygen and nutrients for the subsequent granulation tissue formation [45].
- Granulation Tissue Formation: Granulation tissue, composed of capillaries and fibroblast cells, supports new tissue growth. The newly established blood vessels supply essential nutrients and oxygen, which support the re-epithelialization process [46].
- Re-epithelialization: In this sub-stage, fibroblasts produce growth factors such as hepatocyte growth factor, keratinocyte growth factor, and epidermal growth factor, which stimulate keratinocytes to migrate and proliferate across the wound bed. This process leads to a new epithelial layer over the wound [47].
- Wound Contraction: Myofibroblasts, a combination of fibroblasts and smooth muscle cells, play a key role in wound contraction. These cells pull the edges of the wound together, facilitating closure. This contraction reduces the wound’s size [48].
Research by Xie et al. highlighted the use of chitosan nanofibers incorporated with vascular endothelial growth factor (VEGF) to enhance wound healing. VEGF is a crucial mediator of angiogenesis and granulation tissue formation [49].
2.4.4. Remodeling
This phase is the final stage of wound healing, commencing approximately two weeks post-injury and extending up to one year (Figure 3d). This phase consolidates the processes initiated during the inflammation and proliferation stages, completing the healing process [50].
- Resolution of Cellular Components: During remodeling, macrophages, endothelial cells, and myofibroblasts exit the wound site or undergo apoptosis. This phase is characterized by a decline in the metabolic activity associated with wound healing as smaller arterioles aggregate into larger blood vessels [51].
- Extracellular Matrix (ECM) Remodeling: The ECM undergoes significant changes as part of the remodeling process. Collagen type III, prevalent during the proliferation stage, is replaced by collagen type I. This transition is facilitated by lysyl oxidase and matrix metalloproteinases (MMPs) secreted by fibroblasts. These enzymes aid in the realignment of collagen fibers to enhance the tensile strength of the newly formed tissue. Despite this improvement, the tensile strength of the remodeled tissue typically reaches only about 80% of that of uninjured skin [52,53].
- Cellular Apoptosis and ECM Degradation: The final steps in wound repair involve the apoptosis of residual cells, migration away from the wound site, and the degradation of the ECM by MMPs [52,53].
- Scar Formation: Scar formation occurs due to the lack of proper anchoring of the subcutaneous tissue to the epidermis, precisely the absence of rete pegs, which are critical for the tight connection between the epidermis and dermis. Scar formation can be minimized by maintaining a proper balance between ECM synthesis and degradation, thus promoting optimal tissue repair and functional recovery [51,52,53].
Understanding these processes is essential for developing strategies to improve wound healing and minimize scar formation, ultimately enhancing patient outcomes and tissue regeneration.
2.5. Factors Affecting Wound Healing
Several critical factors influence the wound healing process, especially in aged patients, where delayed leukocyte migration to the wound site and reduced phagocytic capacity of macrophages correlate with prolonged wound healing [54]. Research has shown that stress significantly delays wound healing by regulating glucocorticoids and decreasing growth factors produced by macrophages and cytokines such as TNF-α and IL-6. Additionally, stress reduces the levels of chemoattractants like IL-1α and IL-8, which are essential for the inflammatory phase of wound healing [55,56,57,58].
In obese patients, there is a higher risk of surgical wound infections. The friction between skin folds often leads to ulceration. The primary caloric storage in adipose tissue influences wound healing, as adipose tissue secretes adipokines that affect the body’s inflammatory response [59,60,61,62].
Tobacco smoke, containing thousands of substances, significantly impacts wound healing. Key components such as nicotine, hydrogen cyanide, and carbon monoxide play significant roles [63,64,65,66]. Nicotine induces vasoconstriction, reducing blood flow to tissues; hydrogen cyanide decreases tissue oxygen consumption; and carbon monoxide leads to tissue hypoxia, suppressing wound healing [67].
2.5.1. Factors Impacting Wound Healing in Aged Patients
- Leukocyte Migration: The migration of these cells is slower in aged individuals, leading to a delayed inflammatory response.
- Macrophage Function: The phagocytic capacity of macrophages is reduced.
2.5.2. The Role of Stress in Wound Healing
- Glucocorticoid Regulation: Stress regulates glucocorticoids, decreasing the concentration of macrophage growth factors and cytokines such as TNF-α and IL-6.
- Reduction of Chemoattractants: Stress reduces levels of IL-1α and IL-8, crucial for the inflammatory phase, delaying healing.
2.5.3. Obesity and Wound Healing
- Increased Infection Risk: Obese patients have a higher risk of wound infections.
- Friction and Ulceration: Skin friction in obese individuals often leads to ulceration.
- Adipokines and Inflammation: Adipose tissue secretes adipokines that negatively impact the body’s inflammatory response.
2.5.4. Effects of Tobacco Smoke on Wound Healing
- Nicotine: Causes vasoconstriction, reducing blood flow in tissues.
- Hydrogen Cyanide: Decreases tissue oxygen consumption.
- Carbon Monoxide: Leads to tissue hypoxia.
Understanding these factors is important to improve wound healing, primarily in populations with vulnerabilities, such as the elderly, obese, and smokers [67].
3. Wound Dressing
3.1. The Role and Criteria of Wound Dressings in the Healing Process
Wound dressings can reduce pain and protect against infections, creating an optimal environment for healing. An ideal wound dressing should present the following properties [68,69]:
- Provide a Moist Environment: Maintaining moisture at the wound site promotes faster healing and prevents the wound from drying out, which can cause further damage.
- Allow Gas Exchange: The dressing should be permeable to gases, such as oxygen and carbon dioxide, to support cellular respiration and prevent anaerobic bacterial growth.
- Eliminate Excess Exudates: The dressing must absorb excess wound exudates while preventing them from saturating the outer surface and maceration of the surrounding skin.
- Protect Against Microorganisms: Create a barrier against bacteria and other microorganisms, preventing diseases.
- Provide Mechanical Protection: To protect the wound from physical damage and external trauma, supporting the healing process.
- Control Local pH and Temperature: To maintain optimal cellular activities and enzymatic processes involved in healing.
- Easily Replaceable and Removable: The dressing should be easy to apply and remove without causing additional pain or damage to the wound.
- Minimize Wound Pain: Alleviate pain associated with the wound, making the recovery comfortable.
- Non-Allergenic: Avoid allergic reactions.
- Economically Viable and Cosmetically Acceptable: The dressing should be cost-effective and aesthetically pleasing, ensuring it is accessible and acceptable to patients.
- Stimulate Growth Properties: Support cell proliferation and tissue regeneration.
- High Biocompatibility and Elasticity: It must be biocompatible to avoid adverse reactions and elastic enough to conform to the wound area without restricting movement [70].
3.2. Classification of Wound Dressing
Wound dressings are classified as passive, interactive, advanced, and smart (Figure 4).
Figure 4.
Classification of different functional fiber-based wound dressings.
Passive Dressings: The intricate network of fibers in passive dressings establishes an ideal environment for wound healing by enabling oxygen permeability through their porous structure. These dressings, which can be engineered from both natural and synthetic polymers, are highly regarded for wounds that demand an optimal healing milieu and robust protection against mechanical damage. In a pivotal study by Uppal et al., hyaluronic acid was electrospun to rigorously evaluate the impact of key electrospinning parameters, such as applied voltage, spin length, and flow rate, on the fiber diameter. The study conclusively demonstrated that the air permeability of electrospun hyaluronic acid significantly outperformed that of conventional gauze treated with Vaseline [70].
Interactive Dressings: Dressings that provide a suitable environment and assist in controlling bacterial growth are called interactive dressings. An interactive dressing combines non-biological polymer (synthetic polymer) and biological molecules owing to ease of processing, anti-bacterial characteristics, and wound site affinity. The possibility of immunogenic reactions and impurities moderates the scope of the dressing. Liu et al. investigated a polylactide–polyglycolide (PLGA)/collagen nanofiber with a 250 nm diameter. They postulated that their ternary nanofiber composites have an excellent affinity towards human fibroblasts, which is important for improving wound healing in the initial stage [71].
Advanced Dressings: Drug-loaded nanofibers represent a cutting-edge advancement in interactive dressings, offering a powerful approach to treating bacterial infections. There are three primary types of nanofibers into which drugs can be incorporated: drug-loaded uniaxial electrospun nanofibers, drug-loaded biaxial electrospun nanofibers, and drug-loaded triaxial electrospun nanofibers. Among these, drug-loaded nanofibers are most frequently fabricated using the coaxial electrospinning technique, which produces a core/shell structure. The core comprises the drug in this configuration, while the shell comprises the polymer matrix. The drug release profile of these core/shell nanofibers is influenced by several factors, including shell thickness, the wettability of the polymer and drug, the nature of the matrix (whether linear or crosslinked), biodegradability, and porosity.
He et al. successfully fabricated PLLA/tetracycline hydrochloride (TCH) nanofibers via coaxial electrospinning, where PLLA served as the shell, acting as a drug release carrier, and tetracycline hydrochloride functioned as the core, providing the antibiotic effect. Their study demonstrated sustained drug release over a period of 30 days [72]. Similarly, Soltanova et al. investigated coaxial nanofibers with a hydrophilic drug, ampicillin, as the core and polycaprolactone (PCL) as the sheath [73]. Their comparison of blend nanofibers with coaxial nanofibers revealed that the blend nanofibers released 85% of the drug within 4 h, while the coaxial nanofibers exhibited a significantly slower release of 7% over the same period. A zero-order kinetic mechanism supports this controlled release profile.
Smart Dressings: This dressing can perform the real-time monitoring of wound healing by sensors integrated within the dressing. These sensors provide continuous feedback on the wound’s healing status. Schueren et al. demonstrated that PCL/chitosan nanofibers functionalized with Nitrazine yellow have significant potential for application in wound healing [74]. Additionally, Tamayol et al. developed a thermoresponsive nanofiber mesh designed for on-demand drug delivery, where the release of the drug is triggered by biodegradable metallic heaters embedded within the nanofiber mesh. This innovative approach allows for precise, controlled drug administration directly at the wound site, enhancing the overall effectiveness of the treatment [75]. Table 1 summarizes the advantages and disadvantages of these wound dressings.
Table 1.
Some advantages and disadvantages of wound dressing [70,71,72,73,74,75].
4. Fiber Production Methods
Several advanced techniques are utilized in producing fibers, each distinguished by its unique mechanism and application. They include stretching, phase separation, template synthesis, self-assembly, force-spinning, and electrospinning. Each technique offers distinct advantages and is selected based on the desired properties and functionalities of the produced fibers.
4.1. Drawing
The drawing method is a meticulous and highly controlled technique for producing nanofibers, where a polymer solution is applied linearly to a designated surface or substrate. In this process, the polymer droplet is precisely drawn into a capillary tube at the critical juncture where the droplet meets the substrate. Subsequently, the capillary tube is methodically rotated, facilitating the gradual evaporation of the solvent as the tube is carefully withdrawn. This sequential action culminates in the formation of nanofibers with high precision [76].
While the drawing method can produce exceptional uniformity and quality fibers, it is inherently labor-intensive and time-consuming [77]. The method’s intricate nature limits its scalability, making it more suited for applications requiring small quantities of nanofibers or for research purposes rather than large-scale industrial production. Despite these limitations, the drawing method remains valuable when precision and control over fiber morphology are paramount [76,77].
4.2. Template Synthesis
The template synthesis method is a sophisticated technique for fabricating nanofibers, wherein a polymer solution is directed through a meticulously crafted mold or template. During this procedure, the solvent component of the solution either undergoes evaporation or diffuses into an alternative solvent medium. This transition culminates in the formation of nanofibers that precisely replicate the dimensions and morphological characteristics of the template’s pores [77].
While this method offers unparalleled control over the size and shape of the resulting nanofibers, it is encumbered by significant practical challenges [68]. Foremost among these is the intricate and labor-intensive template fabrication process, often requiring advanced materials and precise engineering. The complexity associated with creating such templates not only escalates production costs but also limits the scalability of the method. Consequently, despite its capability to produce nanofibers with high precision and uniformity, the template synthesis method remains primarily confined to specialized applications and research settings, where its benefits can outweigh the logistical and economic constraints [78].
4.3. Phase Separation
The phase separation method is a sophisticated approach for fabricating nanofibers, wherein gelation occurs within a specially prepared polymer solution under controlled temperature conditions. During this process, polymer chains are induced to form a specific arrangement within the solution, developing a structured network. Subsequently, a selective solvent is employed to extract the original solvent from the system, leaving behind a three-dimensional lattice composed of interconnected fibers [68].
This method is notable for its ability to create intricate fibrous structures with a high degree of control over the morphology and spatial arrangement of the fibers. The resulting three-dimensional network is characterized by its fused fibers, contributing to the structure’s overall mechanical stability and integrity. However, the phase separation method requires precise control over temperature and solvent conditions to achieve the desired fiber architecture. It is a technique best suited for specialized applications where such detailed control is essential [78].
4.4. Self-Assembly
The self-assembly method is predominantly employed in fabricating protein and peptide nanofibers, leveraging the inherent ability of these biological molecules to organize themselves into structured configurations. In this method, a solution of proteins and peptides is carefully prepared. Under specific temperature and concentration conditions, the polymers naturally arrange themselves into an organized and stable structure [78].
This self-organization process forms protein and peptide nanofibers, which retain their structural integrity and exhibit specific functional properties [78]. The method is particularly valued for producing nanofibers with precise molecular arrangements without external templating or mechanical intervention. However, achieving the optimal conditions for self-assembly requires meticulous control of environmental factors, as even slight variations can significantly impact the final structure of the nanofibers. Despite these challenges, the self-assembly method is a powerful tool in nanotechnology, especially in developing biomimetic materials and applications where the unique properties of protein and peptide nanofibers are desired [79].
4.5. Force-Spinning
The force-spinning method is innovative for producing nanofibers, utilizing centrifugal force to propel materials through a series of precisely engineered threaded holes. As the material is driven outward by centrifugal force, it is extruded through these apertures, forming nanofibers [79].
A significant advantage of the force-spinning method is its ability to produce nanofibers from a wide range of materials, including those with low dielectric constants, which are often challenging to process using other techniques. This versatility makes force-spinning a promising approach in various applications, mainly where traditional methods may fall short [79].
However, despite its potential, the force-spinning method still needs to be explored, with many aspects of the process still needing to be fully understood. Ongoing research is required to elucidate these unknown dimensions and optimize the technique for broader industrial applications. The method’s novel approach and capability to work with diverse materials make it a compelling study area within nanotechnology [75,76,77].
4.6. Electrospinning
In recent years, nanofibers have garnered significant attention in biomedical applications, including tissue engineering, drug delivery, and wound dressing, due to their unique properties, such as a high aspect ratio, extensive surface area, customizable features, and consistent diameter. Among the various methods of fabricating nanofibers, electrospinning has emerged as the most widely utilized technique, favored for its simplicity, reproducibility, and cost-effectiveness [78,79,80].
The electrospinning method involves the application of a high electric field between a polymeric solution and a collector plate. In this setup, the polymer solution acts as an electrode carrying a positive charge, while the metallic collector functions as a negatively charged counter-electrode. The substantial potential difference between these two electrodes generates electrostatic forces that draw the polymer solution into fine nano/microfibers [80,81,82,83].
The electrospinning apparatus consists of three fundamental components: a high-voltage power source to charge the electrodes, a syringe equipped with a metallic needle to deliver the polymer solution, and a metallic collector or counter-electrode where the spun nanofibers are deposited (Figure 5a) [80,84,85].
Several factors influence the characteristics of the resulting electrospun fibers. These include the following [86,87,88,89,90]:
- Solution properties: Viscoelasticity, surface tension, conductivity, dielectric properties, and solvent volatility.
- Processing variables: Applied voltage (kV), the distance between the needle tip and the collector (cm), and the flow rate of the polymer solution (µL/min).
- Environmental variables: Room temperature (°C) and humidity (%).
As the solvent evaporates, the nanofibers deposited on the metallic collector mimic the extracellular matrix (ECM) in size and geometry, making them particularly suitable for biomedical applications [91,92,93,94,95]. Detailed parameters for electrospinning various biopolymers are outlined in Table 2, providing a comprehensive guide for optimizing fiber production.
Table 2.
Parameters of electrospinning of different biopolymers.
Table 2.
Parameters of electrospinning of different biopolymers.
| Polymer | Solvent | Voltage (kV) | Flow Rate (mL/h) | Tip Collector Distance (cm) | Fiber Diameter (nm) | Ref. |
|---|---|---|---|---|---|---|
| PDDA | Ethanol | 17 | 0.8 | 16 | 93.5 | [26] |
| PLLA | Dichloromethane:Acetone (2:1) | 15 | 0.8 | 15 | 1153 ± 112 | [41] |
| PCL | Chloroform | 21 | 0.1 | 6 | 250–300 | [89] |
| Chitosan | Acetic acid | 40 | 20 µL/min | - | 130 | [90] |
| PVA | Deionized water | 22 | 1 | 10 | 240 | [91] |
| Cellulose Acetate | Acetone | 25 | 3 | 10 | 1000 | [92] |
Electrospinning offers the remarkable ability to produce fibers across a wide range of diameters, from micrometers (10–100 µm) to sub-micrometers or nanometers (10–100 nm) [93,94,95]. Research by Chew et al. and Wang et al. has demonstrated that aligned electrospun scaffolds can significantly influence cellular behavior, guiding cells to elongate and orient themselves along the central axis of the nanofibers [96,97,98]. However, uniaxial electrospinning, while effective for fiber alignment, may damage sensitive fillers or drugs.
To address this limitation, the uniaxial electrospinning process has advanced to coaxial electrospinning, also known as the core–sheath electrospinning technique (Figure 5b). In coaxial electrospinning, the sheath polymer solution primarily encases the core, and the conical shape of the sheath at the needle tip induces deformation of the core layer. This modification has gained popularity because the sheath layer helps maintain the structural integrity of the core materials, such as drugs or fillers [99].
Coaxial electrospinning has also been utilized to fabricate hollow nanofibers through two primary approaches: (1) spinning the sheath polymer solution alone, without a core solution, and (2) selecting a core polymer solution that can be subsequently dissolved in a solvent, leaving behind a hollow structure with the sheath layer remaining intact [100,101,102,103]. For example, Srivastava et al. successfully created core/shell nanofibers with an average diameter of 100 nm using a heavy mineral oil/PVP + TiO2 core/shell configuration. The core was removed by dissolving it in octane, leaving behind hollow fibers.
Despite their advantages, core/shell nanofibers are limited in providing sustained drug delivery due to having only a single breathable barrier layer of polymer matrix [104]. Consequently, multi-barrier-layer nanofibers are preferred for applications requiring prolonged and controlled drug release, offering enhanced performance in sustaining and extending drug delivery.
The tri-axial electrospinning method produces multilayer fibers with three distinct layers: an outer solution, a middle solution, and an inner solution (Figure 5c). This method facilitates complex functionalities such as sustained and dual drug delivery within a single fiber and allows for the incorporation of multiple properties by layering different materials [105].
However, Khalf et al. identified critical challenges associated with the tri-axial electrospinning technique [106]. The solvent choice for the sheath layers influences the fiber formation. The production rate of these fibers was also limited. These issues were overcome by introducing multi-needle and needleless electrospinning systems, significantly enhancing production efficiency. Needleless electrospinning, also known as tip-less electrospinning (Figure 5d), represents a significant innovation. Wu et al. demonstrated that this technique, which utilizes a circular cylindrical electrode, can achieve a yield of PEO nanofibers that is 260 times greater than that obtained with the traditional single-jet electrospinning method [107]. This substantial increase in yield underscores the effectiveness of needleless electrospinning in scaling up production while maintaining the high quality and consistency of the nanofibers.
Figure 5.
Various electrospinning fabrication methods: (a) uni-axial electrospinning technique, (b) coaxial electrospinning technique, (c) tri-axial electrospinning technique, (d) needleless electrospinning. Reprinted from Ref. [105].
Figure 5.
Various electrospinning fabrication methods: (a) uni-axial electrospinning technique, (b) coaxial electrospinning technique, (c) tri-axial electrospinning technique, (d) needleless electrospinning. Reprinted from Ref. [105].

4.7. Advantages of Nanofibers as Wound Dressing
4.7.1. Nanofibers and Hemostasis
Fibers produced through electrospinning often present small interstices and a high surface-area-to-volume ratio. Specifically, electrospun nanofibers’ increased surface area and fine porosity facilitate improved hemostasis at injury sites by providing a conducive environment for clot formation and wound healing [108].
The superior hemostatic capabilities of these nanofibers make them a promising alternative to traditional hemostatic agents, which may carry the risk of adverse effects when introduced into the body. Nanofibers support effective hemostatic outcomes because of their high surface area and interconnected pore structure. This approach offers an efficient solution for managing bleeding and promoting tissue repair in clinical settings [109].
4.7.2. Absorption of Exudates from the Wound
Nanofibers made of polymers absorb exudates and support wound healing. These nanofibers absorb significantly more water, swelling between 18% and 213%, compared to films made from the same polymers. This enhanced water absorption capacity manages exudate removal and prevents wound desiccation [109]. By maintaining a moisture balance, nanofibers facilitate a favorable environment for healing, reducing risks associated with dry or overly wet wounds. This makes nanofibers a practical choice for wound dressing materials [110].
4.7.3. Maintaining a Moist Environment and Permeability
Electrospun mats composed of nanofibers form a mesh-like structure that creates an environment for cellular activities, including respiration, proliferation, and viability. [109]. The gas permeation in electrospun mats ensures that oxygen can diffuse freely through the fibers. This prevents tissue dehydration and maintains a moist environment, which supports cellular function and accelerates tissue regeneration [110].
4.7.4. Drug-Controlled Release
Nanofibers can be associated with bioactive compounds to improve the healing process by delivering these to the wound site [109]:
- Antibiotics: To prevent and treat infections at the wound site.
- Growth Factors: To enhance cell proliferation and tissue regeneration.
- Vitamins: To support cellular repair and overall skin health [111].
4.7.5. Flexibility and Density in the Dressing Mat
Polymeric fibers are often flexible, supporting an effective healing process, offering some advantages [109], such as
Adaptability: The flexibility allows them to conform to the contours of various wound sites, providing consistent protection and support.
Comfort: Soft fibers minimize discomfort, and the porous structure reduces irritation, enhancing overall comfort during wear.
Compliance: Nanofiber dressings provide a comfortable and adaptable fit to the wound site. This adherence enhances the healing process and reduces the need for frequent dressing changes.
Nanofiber mat density: While the fibers’ size may affect the material’s overall functionality as a wound dressing, the density of fiber mats/meshes also plays a role in cell adhesion and proliferation and exudate removal. Lower fiber densities enhance fibroblast infiltration and exudate absorption, whereas higher densities improve mechanical support but limit cellular penetration [112].
4.7.6. Scar-Reduction Strategies
While complete scar-free healing is impossible in significant or deep wounds, minimizing scar formation is the objective in advanced wound care. Achieving minimal scarring with wound dressings remains a challenge. Fibers are engineered to support skin regeneration by providing a biodegradable fiber matrix as a tissue repair scaffold. The fibers mimic the skin’s natural structure, enhancing biocompatibility with surrounding tissues for wound healing and tissue regeneration. By mimicking the ECM architecture, fibers can be integrated into the wound site, promoting more efficient healing and reducing the risk of excessive scar formation. Such advanced nanofiber-based dressings offer a promising strategy for improving wound healing outcomes, potentially resulting in smoother, less prominent scars and more effective tissue repair [110,111,112].
Figure 6 illustrates different stages of wound healing following the application of nanofiber-based dressings. In general, the scaffolds facilitate the recruitment of fibroblasts and macrophages that contribute to synthesizing ECM components and resolving inflammation, helping to reestablish the dermal tissue and contract the wound, respectively [110]. Fibers are materials that support cellular infiltration and integration, enhancing healing and reducing scar formation (Figure 6).
Figure 6.
Schematic representation of the different stages of wound healing following the application of nanofiber-based dressings.
5. Polymers to Produce Electrospun Nanofibers
Polymers can be classified into natural and synthetic types. The selection of the appropriate polymer system is critical, as these nanofiber-based patches are intended for direct contact with wound tissue. For optimal wound healing outcomes, these patches must possess properties that closely mimic the ECM and support the healing process effectively.
Natural polymers, including proteins and polysaccharides, have gained considerable attention due to their inherent similarity to the macromolecules recognized by the human body. These natural polymers are advantageous because they offer a high degree of ECM biomimicry, which enhances biocompatibility and promotes better integration with the wound site. Moreover, many natural polymers possess additional beneficial properties such as antimicrobial, anti-inflammatory, and hemostatic effects, which can further contribute to wound healing and protection [111,112].
On the other hand, synthetic polymers can be engineered to provide specific mechanical properties, controlled degradation rates, and tailor-made functionalities. However, balancing mechanical performance and biological compatibility often requires careful design and modification [112].
5.1. Electrospinning of Natural Polymers for Wound Healing
Natural polymers are essential to impart biocompatibility in wound dressings. Some natural polymers also often exhibit antiadhesive and anti-inflammatory properties, which enhance tissue repair. However, there are challenges associated with using natural polymers for electrospinning. These include higher costs, more complex processing requirements, and inferior mechanical properties compared to synthetic polymers [112,113,114,115]. Researchers often combine natural and synthetic polymers to address these limitations. By blending these polymers in solution or co-electrospinning them from different solutions, it is possible to enhance the physical and chemical properties of the resulting nanofibers to meet specific requirements for wound healing applications [116,117,118].
Some of the main natural polymers used to promote wound healing include [115,119,120]
- Collagen: Supports cell adhesion and tissue regeneration, mimicking the ECM composition that comprises proteins and proteoglycans.
- Gelatin: Is derived from collagen, offering similar benefits for tissue repair.
- Chitosan: Presents antimicrobial activity and enhances wound healing.
- Fibrinogen: Supports blood clotting, assisting in hemostasis and tissue repair.
- Fibronectin: Supports cell adhesion and migration, supporting wound repair.
- Silk Fibroin: Provides mechanical performance and biocompatibility.
- Elastin: Contributes to the elasticity and flexibility of tissues.
- Hyaluronic Acid: Supports hydration and tissue repair and has anti-inflammatory properties.
- Cellulose: Offers high mechanical strength and biocompatibility.
- Alginate: Provides gel-forming properties and aids in moisture control [120].
5.1.1. Collagen
Collagen, the most abundant animal protein, is a critical structural component in connective tissues such as the dermis, tendons, and bones. It is pivotal in the extracellular matrix (ECM), providing tissue structural stability and tensile strength. Collagen type I, in particular, supports a wide range of cell types, including hepatocytes, spinal ganglion cells, fibroblasts, nerve cells, Schwann cells, epithelial cells, and embryonic lung cells [121]. It is fundamental in studies of tissue morphogenesis, as well as cell growth, differentiation, and migration.
Given its essential role in tissue repair and regeneration, collagen has been extensively researched for its applications in wound healing. A notable study developed a novel scaffold using collagen-based biocompatible electrospun nanofibers (NFs), demonstrating effectiveness against key wound pathogens like Pseudomonas aeruginosa and S. aureus. The scaffold, comprising PHB–Gel–OSA–Col, was highly effective for wound healing and reconstruction, exhibiting high infection tolerance in both in vitro and in vivo evaluations [122].
Electrospun collagen fibers have proven superior to traditional wound dressings in the biomedical field. The crosslinking of collagen electrospun fibrous membranes under aqueous conditions has increased Young’s modulus, enhancing their mechanical properties and mimicking the native ECM more effectively. This results in improved wound healing and tissue regeneration compared to conventional gauze and industrial collagen dressings, such as those used for bone and cartilage [123].
Combined with topical agents or enzymes, hybrid collagen-based fiber dressings can further accelerate healing and improve recovery. One study investigated incorporating silver nanoparticles (NPs) into collagen nanofiber mats through electrospinning. Silver NPs, synthesized by chemical reduction, were evaluated for their minimum inhibitory concentration (MIC) against S. aureus and P. aeruginosa, revealing significant antibacterial activity [121].
Another study developed a novel antimicrobial nanofiber mat incorporating SSD into ethyl cellulose (EC)/PLA/collagen, demonstrating inhibition against Bacillus and Escherichia coli (E. coli) bacteria [124]. Similarly, electrospun nanofiber membranes composed of collagen and zein in an aqueous acetic acid solution showed controlled release and antibacterial action, making them suitable for wound healing applications [125,126].
Further advancements include the creation of zein/PCL/collagen nanofibers incorporating zinc oxide (ZnO) nanoparticles and aloe vera, which displayed inhibition activity against S. aureus and E. coli. These findings suggest that collagen-based nanofibers with added antimicrobial agents can be effective wound dressings [127].
In a different approach, Yuan et al. employed a layer-by-layer (LBL) self-assembly deposition method to integrate lysozyme (LY) and collagen onto silk fibroin/nylon 6 (SF/N6) nanofiber mats [128]. The LBL-structured mats exhibited superior antibacterial and biocompatibility properties compared to the SF/N6 nanofibers alone. The successful assembly of lysozyme significantly enhanced the antibacterial performance, contrasting with SF/N6 mats that promoted the proliferation of E. coli (11.4%) and S. aureus (69.6%) (Figure 7) [128].
Figure 7.
(A) Representation of fabrication method of SF/N6- and LBL nanofiber composites and (B) antibacterial properties of SF/N6 and LBL nanofiber composites against E. coli and S. aureus: (a) SF/N6, (b) (lysozyme/collagen), (c) (lysozyme/collagen), (d) (lysozyme/collagen), (e) (lysozyme /collagen), (f) (lysozyme/collagen), and (g) (lysozyme/collagen). Reprinted from Ref. [128].
Liu et al. developed composite nanofibers incorporating polylactide-polyglycolide (PLGA) with collagen, achieving an average fiber diameter of 250 nm [129]. These as-spun nanofibers exhibited no cytotoxic effects and effectively promoted cell adhesion and proliferation in normal human fibroblasts. In vivo studies using full-thickness wounds in Sprague Dawley rats demonstrated that the PLGA-collagen nanofibers facilitated a faster healing process than conventional proprietary dressings, such as DuoDERM and gauze sponges. Specifically, the PLGA-collagen nanofibers resulted in a more rapid reduction in wound area, supported the formation of new fibrous tissue, exhibited minimal inflammatory cell infiltration, and achieved complete re-epithelialization [129].
Rath et al. prepared collagen nanofibers loaded with silver nanoparticles, with fiber diameters ranging from 300 to 700 nm [130]. These nanofibers were crosslinked through exposure to glutaraldehyde-saturated vapor for 24 h at room temperature. This effectively delayed the release of the encapsulated silver nanoparticles by reducing water influx into the fibers. The silver-loaded nanofibers demonstrated significant antibacterial activity in vitro against S. aureus and P. aeruginosa. Unloaded collagen nanofibers showed improved wound healing compared to control groups, but the silver-nanoparticle-loaded nanofibers exhibited even greater healing rates due to their antimicrobial properties. This resulted in accelerated wound healing and minimized scar formation. Histological analysis of the wound areas indicated that the silver-nanoparticle–collagen nanofibers significantly enhanced collagen production, wound contraction, and re-epithelialization compared to the unloaded collagen nanofibers [130].
5.1.2. Gelatin
Gelatin, a polymer derived from collagen, is widely abundant and shares the composition and properties of collagen [131]. Depending on the hydrolysis method employed, gelatin can be classified into two types: Type A gelatin, produced via acidic hydrolysis, which carries a positive charge at physiological pH, and Type B gelatin, obtained through alkaline hydrolysis, which is negatively charged under the same conditions [132]. This biodegradable polymer is extensively utilized across various industries, including food, cosmetics, and medicine [133]. Gelatin products can take the form of films, nanoparticles, or porous hydrogels, each serving distinct functions.
In particular, gelatin has been widely employed as a drug delivery system for growth factors, with crosslinking techniques being utilized to modulate the degradation and release rates of encapsulated substances [134]. Given its broad molecular weight distribution, gelatin can adopt various conformations, such as hydrogels, microspheres, or microparticles, under appropriate temperature, solvent, or pH conditions. Gelatin nanofilms, for instance, can be produced through electrospinning [134,135]. However, due to its nature as a polyelectrolyte polymer with ionizable groups, gelatin forms strong hydrogen bonds that result in a three-dimensional macromolecular network, thereby restricting the mobility of gelatin chains [135]. Consequently, electrospinning pure gelatin is challenging. To overcome this, solvents such as 2,2,2-trifluoroethanol, formic acid, and acetic acid are employed during the electrospinning process [136]. Additionally, the stability of electrospun gelatin fibers can be enhanced through crosslinking with various chemicals, such as glutaraldehyde vapor [137,138] or hexamethylene diisocyanate [139].
The potential of gelatin nanofibers, particularly those formed through electrospinning, for wound healing applications has been previously documented. For instance, Dubský et al. reported the successful electrospinning of gelatin nanofibers using a 10 wt% gelatin solution in acetic acid [140]. The resulting fibers, with an average diameter of 110 μm, were crosslinked post-electrospinning by exposure to glutaraldehyde vapors for three hours in a sealed environment. The study demonstrated that human dermal fibroblasts, keratinocytes, and mesenchymal stem cells adhered to and proliferated on the crosslinked gelatin nanofibers, indicating the fibers’ non-cytotoxic nature and potential applicability in tissue engineering. In vivo studies involving full-thickness wounds in Wistar rats revealed that crosslinked gelatin nanofibers promoted more rapid wound closure than polycaprolactone (PCL) nanofibers or a control gauze treatment. Furthermore, these nanofibers facilitated greater epithelialization, granulation tissue formation, and myofibroblast presence in the wound area [140].
Incorporating biomolecules as therapeutic agents into gelatin nanofibers has also been explored to enhance wound healing. Adeli-Sardou et al. encapsulated lawsone—a compound derived from Lawsonia inermis, known for its antimicrobial activity against Gram-positive, Gram-negative, and biofilm-producing bacteria—into gelatin–PCL nanofibers through coaxial electrospinning [141]. The diameter of the resulting nanofibers varied, with measurements of 238 ± 8, 259 ± 13, 246 ± 10, and 297 ± 5 nm for PCL–gelatin-lawsone nanofibers containing lawsone concentrations of 0, 0.5, 1, and 1.5% w/v, respectively. The lawsone-loaded nanofibers exhibited a sustained release of the compound over 20 days. They demonstrated antibacterial activity against S. aureus, though they were ineffective against P. aeruginosa, as the latter species is known to degrade lawsone [141,142]. These nanofibers also promoted the adhesion and proliferation of gingival fibroblast cells, accompanied by increased gene expression of transforming growth factor β (TGF-B1) and collagen (COL1). In vivo wound healing studies on Wistar rats indicated that lawsone-loaded nanofibers significantly accelerated wound closure, with near-complete closure observed for PCL-gelatin-lawsone 1% w/v and 1.5% w/v, outperforming both lawsone-free fibers and untreated controls [141]. Histological evaluations further revealed that wounds treated with lawsone-loaded nanofibers displayed enhanced granulation tissue formation, increased fibroblast and collagen activity, and better-organized connective tissue, with angiogenesis completed by Day 14 post-treatment [141].
Lu et al. aimed to scale up the production of gelatin nanofibers by employing spiral electrospinning instead of the conventional single-needle electrospinning method, producing finer nanofibers in larger quantities [143]. Two crosslinking methods were investigated: vapor-phase and liquid-phase glutaraldehyde. The fabricated nanofibers were characterized using scanning electron microscopy (SEM), transmission electron microscopy (TEM), and mechanical testing, revealing differences in their structures. The nanofibers crosslinked via the liquid-phase glutaraldehyde method exhibited superior uniformity, higher tensile strength, and improved morphology compared to those crosslinked using the vapor-phase method.
5.1.3. Chitosan
Chitosan (CS) is widely utilized as a wound dressing material and for its inherent therapeutic efficacy. Its beneficial properties, including biocompatibility, nontoxicity, biodegradability, hemostatic, bacteriostatic, and fungistatic characteristics make CS effective in promoting wound healing [144]. In wound dressings, CS has been employed in various forms, such as membranes, nanofibers (NFs), and sponges. Owing to its unique biocompatibility, robust biodegradability, and remarkable antimicrobial properties, CS, a naturally occurring polysaccharide with abundant availability, has been extensively used in numerous medical applications, particularly in wound care.
Electrospinning techniques have been effectively employed to fabricate composite nanofiber membranes of CS and silk fibroin (SF). The antibacterial efficacy of these composite nanofibers against Gram-negative E. coli and Gram-positive S. aureus was assessed using the turbidity measurement method. The results indicated that the antimicrobial activity of the composite depended on the bacterium type [145].
In one study, Huang et al. developed biomimetic nanofibrous matrices coated with positively charged CS and negatively charged Type I collagen using the layer-by-layer (LBL) assembly method [146]. The LBL-architected nanofibrous membranes demonstrated enhanced cell migration in vitro and facilitated skin re-epithelialization and vascularization in vivo. These findings suggest that LBL-structured nanofiber matrices can restore the structural and functional properties of the skin [146].
Another study explored the development of biocompatible antimicrobial nanofiber wound dressings by loading two natural extracts—Cleome droserifolia (CE) and Allium sativum aqueous extract (AE)—onto honey, polyvinyl alcohol (PVA), and hydroxypropyl chitosan (HPCS) matrices. In vitro antibacterial evaluations were conducted against S. aureus, E. coli, methicillin-resistant S. aureus (MRSA), and multidrug-resistant P. aeruginosa compared with the commercial dressing Aquacel Ag. The results revealed that HPCS–AE and HPCS–AE/CE nanofiber mats completely inhibited S. aureus, while the HPCS–AE/CE mats exhibited moderate antibacterial activity [147].
Polysaccharides such as pectin, alginate, and CS have been processed into micrometer-scale architectures (microfibers or particles) for clinical wound care. A comparative study described electrospun nanofiber dressings made from these polysaccharides, with results showing that the pectinate nanofiber mat demonstrated superior antibacterial efficacy. Consequently, the pectinate nanofiber mat may be considered equivalent to alginate and CS nanofiber mats as a wound dressing option [148].
Additionally, a green synthesis method was reported for creating antibacterial nanofiber mats embedded with CS and loaded with silver nanoparticles (Ag-NPs, 25 nm in diameter) following reduction with glucose [149]. In another research endeavor, a 30/70 blend of CS-ethylenediaminetetraacetic acid (CS 2 wt%–EDTA) and PVA solution (10 wt%) was electrospun to produce fibrous mats incorporating lysozyme at concentrations of 10, 20, and 30 wt% [150]. These mats were investigated for their wound healing potential, with results indicating that this biomaterial nanofiber has a promising ability to facilitate wound repair [151].
Ahmed et al. reported the successful fabrication of chitosan-polyvinyl alcohol (PVA) nanofibers encapsulating zinc oxide (ZnO) nanoparticles [151]. These nanofibers exhibited an average diameter of 279.34 ± 7.23 nm and demonstrated significant antimicrobial activity against a spectrum of bacterial strains, including E. coli, P. aeruginosa, Bacillus subtilis (B. subtilis), and S. aureus. In vivo wound healing studies conducted on diabetic rabbits revealed that the chitosan-PVA-ZnO nanofibers substantially enhanced the wound closure rate compared to the control group. Histological analysis of the treated wounds further indicated that the chitosan-PVA-ZnO nanofibers facilitated superior re-epithelialization and accelerated scar tissue maturation, characterized by the absence of inflammatory infiltrates and increased collagen content [151].
In a separate study, Khan et al. developed chitosan-polycaprolactone (PCL) nanofibers loaded with tinidazole [152], an antibiotic commonly employed in the treatment of periodontitis due to its effectiveness against anaerobic bacteria such as Provotella species, Fusobacterium nucleatum, and Veillonella species [153], which are often implicated in the disease. These chitosan-PCL-tinidazole nanofibers were evaluated in a clinical trial involving patients with periodontitis. The study compared three treatment approaches for each infected site: (1) scaling and root planing (SRP), the conventional therapy for periodontitis; (2) SRP combined with chitosan-PCL nanofibers; and (3) SRP combined with chitosan-PCL-tinidazole nanofibers [153].
The results demonstrated that the drug-loaded nanofibers significantly improved recovery from periodontitis. Patients treated with the chitosan-PCL-tinidazole nanofibers exhibited reduced irritation at the injection site compared to the other treatment groups. This was evidenced by reduced periodontal pocket depth, gingival index, bleeding upon probing, and increased gingival tissue attachment to the tooth, indicating enhanced clinical outcomes [153].
Naseri et al. developed an innovative wound dressing mat using chitosan combined with another polymer, polyethylene oxide (PEO) [154]. The electrospun mat characteristics were evaluated, including its structural morphology, mechanical and thermal properties, water vapor permeability, and cytocompatibility. To enhance the mechanical properties of the mat while reducing cytotoxicity, the researchers opted to replace the commonly used crosslinking agent, glutaraldehyde—widely employed in various applications for strengthening organic materials—with genipin, a reagent known for its lower cytotoxicity [154].
The wound dressing mat retained moisture and supported high tensile strength, contributing to its durability and effectiveness in wound care. Furthermore, cytocompatibility tests indicated that the fibers supported the high cell viability of adipose-derived stem cells for seven days. This combination of enhanced mechanical properties, biocompatibility, and prolonged stability positions the chitosan-PEO electrospun mat as a promising material for future wound care solutions [154].
5.1.4. Fibrinogen
Fibrinogen, a soluble 340 kDa globular protein, is an inactive precursor to fibrin and circulates within the bloodstream. Upon disruption of the skin, fibrinogen plays a crucial role in hemostasis by forming insoluble fibrin fibers essential for clot formation [155]. Beyond its role in clotting, fibrinogen is actively involved in wound repair processes, where it interacts with various enzymes, clotting factors, and different cell types such as endothelial cells, smooth muscle cells, fibroblasts, keratinocytes, and leukocytes. Fibrinogen contributes to inflammation, angiogenesis, and tissue remodeling [155].
However, research focused on fibrinogen nanofibers for wound healing applications remains limited compared to studies on other natural compounds. Wnek et al. carried out one of the pioneering efforts to produce electrospun fibrinogen nanofibers [156]. Their study prepared Type I bovine fibrinogen solutions in a hexafluoroisopropanol (HFP) solvent mixture and minimum essential medium (MEM). The fibrinogen concentrations used were 8.3%, 12.5%, and 16.7% w/v, resulting in nanofibers with average diameters of 80 ± 20 nm, 310 ± 70 nm, and 700 ± 110 nm, respectively [156].
Subsequent research explored the effects of fibrinogen nanofiber orientation on human umbilical vein endothelial cells (HUVECs) [157]. In this study, a supernatant derived from a centrifuged bovine fibrinogen solution in HFP/DMEM was electrospun to produce randomly oriented and aligned nanofibers. Randomly oriented fibers were obtained by electrospinning onto a stationary collector, whereas aligned fibers were created using a rotating drum. The results demonstrated that endothelial cells recognized and adhered to the fibrinogen nanofibers more rapidly than to surfaces with adsorbed fibrinogen. Furthermore, cell orientation and migration were significantly enhanced on the aligned nanofibers, whereas the randomly oriented nanofibers induced a stellate-like morphology in the cells, with locally restricted migration [157].
Yuan et al. further expanded the potential applications of fibrinogen nanofibers by investigating the encapsulation of therapeutic agents to enhance wound healing [158]. In their study, chitosan-PEO and fibrinogen solutions were independently and simultaneously electrospun onto the same metal mandrel. Platelet-derived growth factor (PDGF) was incorporated into both solutions before electrospinning, resulting in PDGF-loaded chitosan-PEO-fibrinogen nanofibers. Exudates collected from drug-loaded and drug-free nanofibers were tested for their ability to promote human dermal fibroblast migration. The results revealed that the drug-loaded nanofibers significantly enhanced fibroblast migration compared to the drug-free scaffolds, demonstrating the potential of fibrinogen-based nanofibers as advanced wound healing materials [158].
5.1.5. Fibronectin
Fibronectin is a multifunctional glycoprotein composed of two nearly identical monomers, each with a molecular weight of approximately 250 kDa [159]. Its primary role within the ECM is to provide structural support. Following tissue injury, a provisional ECM predominantly composed of fibrin and fibronectin is established, which is subsequently replaced by a mature ECM with a higher fibronectin content [160]. Beyond its structural role, fibronectin is critically involved in several essential biological processes, including cell attachment, contractility, migration, differentiation, gene expression, and angiogenesis [161,162]. These functions underline the indispensable role of fibronectin in ECM formation, re-epithelialization, and tissue repair, making fibronectin-based nanofibers highly promising for incorporation into wound healing devices [160,163].
Despite its potential, the fabrication of fibronectin nanofibers through electrospinning has yet to be explored. This is mainly due to the challenge of replicating the natural pattern of fibronectin fibrillogenesis, which relies on an integrin activation mechanism requiring mechanical tension, an aspect not easily replicated by conventional electrospinning methods. Consequently, researchers have shifted their focus to coating electrospun polymer-based nanofibers with fibronectin rather than directly producing fibronectin nanofibers [164].
For instance, Ji et al. developed electrospun hyaluronic acid nanofibers that were subsequently coated with human plasma fibronectin [165]. These fibronectin-coated hyaluronic acid nanofibers demonstrated enhanced migration of NIH 3T3 fibroblasts, indicating their potential application in wound healing and tissue regeneration. In another study, fibronectin was grafted onto poly(L-lactide-co-caprolactone) (PLCL) electrospun nanofibers via a two-step chemical reaction [166]. In vitro experiments with porcine esophageal epithelial cells showed that this scaffold could effectively promote epithelial regeneration [167].
Moreover, fibronectin has improved the biocompatibility of silver sulfadiazine (SSD)-loaded polycaprolactone-polyvinyl alcohol (PCL-PVA) nanofibers. Coating these nanofibers with fibronectin reduced the cytotoxic effects of SSD and enhanced the initial attachment of human fibroblasts, further highlighting the utility of fibronectin in wound healing applications [168].
In an innovative approach, Chantre et al. fabricated nanofiber-based scaffolds composed of pure fibrillar fibronectin using a rotary jet spinner. These as-spun fibers were designed to better mimic the conformation of fibronectin found in fetal skin, which is associated with scarless wound healing. In vivo studies on full-thickness wounds in C57BL/6 mice demonstrated that the fibronectin nanofibers significantly accelerated wound closure, achieving complete wound contraction 11 days post-injury, compared to 14 days for the control group. Additionally, the fibronectin nanofibers facilitated the restoration of typical epidermal and dermal structures within 20 days, whereas control wounds exhibited a thicker epidermis characteristic of scarred tissues [168].
5.1.6. Hyaluronic Acid
Hyaluronic acid (HA) is a linear glycosaminoglycan composed of repeating disaccharide units of N-acetyl-D-glucosamine and glucuronic acid [169,170]. It is a highly hydrophilic, polyanionic biomolecule with a molecular weight ranging from 100 kDa to as much as 107 MDa [169,170]. HA is ubiquitously present in the extracellular matrix (ECM) of various tissues in the human body, particularly in the synovial fluid and the ECM of soft connective tissues like skin. HA is degraded into lower-molecular-weight fragments within the ECM during inflammatory responses [169,170].
The molecular weight of HA plays a crucial role in its biological activity. Specifically, low-molecular-weight HA (approximately 50 kDa) and medium-molecular-weight HA (approximately 1000 kDa) have been reported to induce proinflammatory responses by regulating the Toll-like receptor-4 (TLR-4) and activating the nuclear factor kappa B (NF-κB) pathway [171]. HA’s presence in the skin supports dermal structure and regulates dermal volume through its hydrating ability [171,172]. Furthermore, HA supports cell proliferation, differentiation, and wound healing [169]. Additionally, HA has been found to protect skin cells from ultraviolet-induced damage and mitigate wound impairment caused by oxygen-free radicals [173,174].
Due to its high biodegradability, HA is rapidly broken down by hyaluronidases, with tissue half-lives typically extending up to two days [170,175]. The unique properties of HA have led researchers to explore its use in producing nanofibers for wound healing applications. For instance, Huan-Ju et al. developed HA-collagen nanofibers encapsulating angiogenic growth factors using dual electrospinning techniques [176]. In this approach, HA was dissolved in NaOH/DMF, and collagen was dissolved in acetic acid. Growth factors such as fibroblast growth factor (FGF), epidermal growth factor (EGF), vascular endothelial growth factor (VEGF), and platelet-derived growth factor (PDGF) were incorporated into the nanofibrous scaffold through two different methods: (1) direct incorporation of the growth factors into the polymer blend before electrospinning, or (2) encapsulation of the growth factors into gelatin nanoparticles, followed by incorporation into the polymer blend before electrospinning [176].
In vitro studies conducted on human umbilical vein endothelial cells (HUVECs) revealed a significant increase in cell growth rate, capillary tube formation, and branching for groups treated with HA-collagen nanofibers loaded with growth factors compared to those treated with nanofibers without growth factors and the control group. Additionally, in vivo experiments involving full-thickness wounds in streptozotocin-induced diabetic Sprague Dawley rats demonstrated a faster healing rate in wounds treated with growth-factor-loaded nanofibers. This treatment also resulted in increased neovascularization and re-epithelialization rates [176].
Further evaluation of mRNA levels in treated wounds indicated that the application of these as-spun nanofibers led to (1) a progressive increase in the gene expression of Type I collagen over six weeks, coupled with a progressive decrease in the gene expression of Type III collagen, aligning with the normal healing process, and (2) a decrease in Ki-67 expression over a four-week period, which is indicative of a reduction in cell proliferation. This decrease in Ki-67 suggests that the regenerating tissue was transitioning from the proliferative phase to the remodeling phase, marking the progression of wound healing [176].
5.1.7. Cellulose
Cellulose, the most abundant biopolymer on Earth, is a polysaccharide derived from glucose, composed of 1000 to 1500 β-D-glucopyranose units linked by 1,4-β-glucosidic bonds [177,178,179,180]. This biopolymer is synthesized by plants and specific bacterial species, with the bacterial form particularly favored in industrial applications [180,181]. The preference for bacterial cellulose is mainly due to its extraordinary purity, as it is devoid of the by-products commonly found in plant-derived cellulose, such as hemicelluloses, lignin, pectin, and wax [178,182]. These characteristics and their non-toxic and biocompatible nature make cellulose invaluable in various biomedical applications [182].
Cellulose’s advantageous properties extend beyond its biocompatibility. It is also cost-effective, exhibits high porosity, and possesses many hydroxyl groups, which enhances its capacity to absorb water and exudate. Moreover, cellulose provides mechanical strength in wet conditions, maintaining the structural integrity of wound dressings. It can also accelerate granulation at wound sites. Researchers have extensively harnessed these intrinsic properties to develop nanofibers for wound healing [182].
A notable example of cellulose’s application in wound care is demonstrated by Liu et al., who successfully electrospun nanofibers composed of cellulose, polyurethane (PU), and poly(hexamethylene biguanide) (PHMB) [183]. PHMB, a polymer approved by the U.S. Food and Drug Administration (FDA), is widely utilized as an antimicrobial agent in gauze dressings, owing to its proven efficacy against a broad spectrum of pathogens, including Gram-negative bacteria, fungi, and yeast [184]. The effectiveness of the cellulose-PU-PHMB nanofibers was rigorously evaluated using an in vivo model of skin burns. Wounds treated with these fibers exhibited an accelerated recovery within seven days post-injury. The treated wounds were free of edema and exudate, showing evidence of hair regrowth. The histopathological analysis further corroborated these findings, showing that the wounds treated with the nanofibers experienced more advanced healing, characterized by superior re-epithelialization, expedited neovascularization, and enhanced regeneration of dermal structures, including sebaceous glands and hair follicles [184].
In a separate study, Huang et al. explored the potential of cellulose in combination with polycaprolactone (PCL) for wound healing applications. They fabricated PCL-cellulose nanofibers coated with alternating chitosan and Type I collagen layers, creating varying numbers of chitosan-collagen bilayers. The coating process increased the average fiber diameter from 358 ± 118 nm for uncoated PCL-cellulose nanofibers to 526 ± 165 nm for those with the bilayer coatings. These fibers were then incubated in Dulbecco’s Modified Eagle Medium (DMEM) to assess their ability to support the growth of normal human dermal fibroblasts (NHDFs). The results demonstrated a significant increase in cell density, which correlated with the number of bilayers, with a notable enhancement observed when chitosan was used as the outermost layer instead of collagen. The coated and uncoated fibers sustain NHDF attachment and proliferation [146].
The in vivo efficacy of these scaffolds was further validated using full-thickness wound models in Sprague Dawley rats. The study observed that the number of bilayers on the nanofibers significantly influenced the rate of wound closure, re-epithelialization, and neovascularization. Scaffolds with 20 bilayers achieved complete wound closure by the second week, whereas those with 15 reached closures by the third week, and scaffolds with 5 and 10 bilayers by the fourth week. In addition to promoting faster wound healing, the scaffolds with 20 bilayers were also found to be the most effective in stimulating cell motility, as evidenced by elevated levels of α-tubulin detected through immunofluorescent staining following complete wound closure [184].
5.1.8. Cellulose Acetate (CA)
Cellulose acetate (CA) is an outstanding polymer precursor for fiber production, with its recyclability, cost-effectiveness, and the simplicity of its mass production process. CA’s high solubility in organic solvents makes it particularly well-suited for electrospinning, allowing for the efficient production of nanofibers with desirable properties. As a biodegradable, non-irritating, and non-toxic material, CA has been extensively researched and employed in various biomedical applications, including wound dressings, dermal substitutes, and engineered skin tissues [185]. Its use in these applications is primarily attributed to its excellent mechanical properties, high chemical affinity with other compounds, and inherent regenerative capabilities [185].
The potential of CA in wound care is further enhanced when combined with antimicrobial agents to combat wound infections. Notably, in the study conducted by Son et al., CA NFs were electrospun from solutions containing 0.5 wt% silver nitrate (AgNO3) [186]. Upon exposure to UV light at 245 nm, silver nanoparticles (Ag NPs) formed predominantly on the surface of the CA NFs. The size and volume of these Ag NPs increased progressively over 240 min as Ag+ ions and silver clusters diffused and aggregated on the nanofibers’ surface following UV irradiation. The resultant Ag NPs, with an average size of 21 nm, exhibited remarkable antibacterial activity, highlighting their potential in preventing wound infections [186].
In a related study, CA NFs containing Ag NPs were produced through the slow photoreduction of Ag+ ions within the CA NFs over 20 days under standard laboratory conditions [187]. These nanofibers demonstrated significant antibacterial properties and were successfully utilized as separation filters for submicrometer particles, further underscoring their versatility. Another study explored the fabrication of nanofiber membranes composed of CA and polyester urethane (PEU) through co-electrospinning or blend electrospinning techniques. These NF membranes were evaluated for their drug release profiles, in vitro antibacterial behavior, and in vivo wound healing efficacy, specifically for wound dressing applications. The incorporation of CA into the NF membranes was found to enhance their hydrophilicity, as well as their air and moisture permeability [183]. Upon exposure to liquid, CA fibers exhibited slight swelling, which improved moisture absorption and created a humid environment conducive to faster wound healing [187].
Moreover, CA has been utilized to develop composite nanofibers with additional functional properties. For instance, CA-Manuka honey composite nanofiber mats have been employed to create biocompatible and antibacterial wound dressings, leveraging the antimicrobial properties of Manuka honey [188]. In another study, propolis-impregnated CA/polycaprolactone (PCL) nanofiber mats were developed for antimicrobial and antioxidant applications [189]. The resulting propolis-CA/PCL NFs demonstrated potent antioxidant activity. They were effective against Gram-negative (GNB) and Gram-positive bacteria (GPB), making them highly suitable for use in wound care [188].
5.1.9. Alginate
Alginate is an anionic and linear unbranched polysaccharide extracted from brown seaweed. It is composed of (1,4)-linked β-D-mannuronate (M) and α-L-guluronate (G) residues. These residues arrange themselves into distinct blocks of consecutive G residues, blocks of consecutive M residues, and blocks of alternating M and G residues [190,191,192]. Alginates are non-toxic and biocompatible; they are also non-immunogenic and cost-effective and possess water absorption capacity and hemostatic properties. These characteristics have rendered alginate a highly sought-after material in various biomedical applications, particularly in drug delivery systems and tissue engineering [193].
One of the most notable properties of alginate is its ability to absorb up to 20 times its weight in fluids. When alginate comes into contact with a wound, the sodium and calcium ions within sodium and calcium alginates interact with the serum to form a gel. This gel-based system is highly advantageous in wound care, providing a moist environment that promotes healing while simultaneously acting as a barrier against microbial infections [194]. Consequently, alginate has become a foundational component in many commercial wound dressings, such as Kaltostat® and Sorbsan®.
Moreover, alginate’s non-immunogenic nature is complemented by its non-enzymatic degradability in mammals, making it an ideal material for medical applications where biocompatibility is paramount. However, mammalian cells do not naturally adhere to alginate unless the polymer is modified with bioactive molecules such as fibronectin, collagen, or specific short amino acid sequences that facilitate cell adhesion, such as the peptide sequence arginine-glycine-aspartic acid (RGD) [192]. This non-adhesive property of alginate is advantageous in conventional wound dressings, allowing dressing to be replaced at the wound site with minimal trauma [194].
Various factors can significantly influence the therapeutic efficacy of alginate-based wound dressings. These include the concentration of different polymers used with alginate, the types of crosslinkers, the crosslinking process, and the presence of excipients. Additionally, incorporating nanoparticles (NPs) and antibacterial agents can further enhance the functionality of these wound dressings. Each of these variables plays a critical role in determining the final properties of the wound dressing, such as its mechanical strength, biodegradability, and ability to promote wound healing [195].
Electrospinning has been utilized in various studies to develop advanced wound dressing materials by combining sodium alginate (SA) with polyvinyl alcohol (PVA) to create fibrous mats with enhanced properties. In one such study, SA/PVA nanofibrous mats were embedded with zinc oxide nanoparticles (ZnO NPs) with an average size of 160 nm. The antimicrobial efficacy of these SA/PVA/ZnO mats was rigorously evaluated against. S. aureus and E. coli bacteria. The results demonstrated that the presence of ZnO nanoparticles in the composite mats imparted significant antimicrobial properties, effectively inhibiting the growth of both Gram-positive and Gram-negative bacteria [196].
In another investigation, honey was incorporated into an alginate/PVA-based electrospun nanofiber membrane to create an innovative wound dressing material with enhanced antimicrobial capabilities. The antimicrobial activity of these honey-loaded nanofibers was assessed against S. aureus and E. coli using disc diffusion and dynamic contact assays. The results confirmed that the honey-infused nanofibers exhibited substantial antimicrobial effects, making them a promising candidate for wound care applications [197].
Further research explored the development of a nanocomposite web composed of various proportions of calcium alginate and PVA, focusing on its potential for wound healing applications [198]. Moreover, the synthesis of chitosan–alginate (CS–Alg) nanofiber dressings incorporated with varying concentrations of gentamicin (Gn; 0–10 wt%) as a drug delivery system was reported in another study. The antimicrobial performance of the Gn-loaded nanofibers was evaluated, revealing that these dressings exhibited potent antimicrobial activity, as evidenced by the inhibition of bacterial growth. The study further demonstrated that higher concentrations of gentamicin within the CS–Alg nanofibers resulted in enhanced antibacterial efficacy compared to lower concentrations, highlighting the potential of these nanofibers as an effective antimicrobial wound dressing [199].
Figure 8a illustrates a polymeric antibacterial dressing designed to act as a protective barrier over a wound, preventing microbial invasion while simultaneously promoting the migration and differentiation of fibroblasts [200]. The depiction emphasizes that an open wound is highly vulnerable to bacterial infections, which can prolong the inflammatory phase and lead to increased expression of metalloproteinases. These metalloproteinases are known to degrade extracellular matrix (ECM) components and inhibit granulation tissue formation, thereby impeding the healing process. Applying an antibacterial dressing over the wound bed is a physical barrier that blocks pathogenic infiltration and an active agent that eradicates invading microorganisms. Additionally, the antimicrobial properties of the dressing stimulate the immune system and facilitate the migration of fibroblasts and keratinocytes, thereby accelerating wound healing [200].
Figure 8.
(a) Illustration of the healing method in a wound rat model, reprinted from Ref. [201]; (b) SEM images of different polysaccharide nanofibers; and (c) SEM and fluorescent images of bacteria on/across multiple nanofiber mats on plates. Reprinted from Ref. [148].
In a comparative study, Chen et al. characterized and evaluated the properties of electrospun nanofiber (NF) mats composed of pectinate, alginate, and chitosan (CS) as potential dressing materials [148]. The scanning electron microscopy (SEM) images in Figure 8b demonstrate that all three polysaccharides could be successfully transformed into highly porous, bead-free nanofiber mats through electrospinning [148]. The average diameters of the pectinate and alginate nanofibers were similar, measuring 196.4 nm and 178.0 nm, respectively. In contrast, the CS nanofibers exhibited a smaller average diameter of 135.9 nm [148].
Further examination using SEM and fluorescence imaging, as depicted in Figure 8c, revealed the interaction of E. coli bacteria with the various NF mats [148]. The results indicated that E. coli exhibited similar behavior in interacting with NF mats on plates as in solution. Specifically, numerous E. coli bacteria were observed penetrating the interfiber pores and adhering to the pectinate NF mat. In contrast, only a limited number of E. coli were trapped or adhered to the alginate NF mat, while many bacteria attached to the surface of the CS NF mat. These findings underscore the differential bacterial interaction with the various polysaccharide-based NF mats, which could have important implications for their application in wound healing and infection control [201,202,203,204,205,206].
In a study by Coşkun et al., poly(vinyl alcohol) (PVA) and sodium alginate nanofibers were successfully electrospun, yielding fibers with an average diameter of 100.35 ± 12.79 nm [207]. Post-electrospinning, the nanofibers were crosslinked through exposure to a solution containing 0.15 M glutaraldehyde and 0.05 M hydrochloric acid (HCl) in acetone for 24 h. Using a New Zealand white rabbit model, the in vivo wound healing efficacy of these nanofibers was compared to three commercially available dressings—Tulle Grass, Bactigras, and Suprasorb-A. Results at 15 and 21 days post-surgery indicated that the wound healing performance of the electrospun nanofibers was significantly superior to that of the commercial dressings. This was evidenced by enhanced re-epithelialization, angiogenesis, and the formation of hair follicles at the wound site, suggesting the nanofibers’ potential as an advanced wound healing material [207].
Further exploration into the encapsulation of antimicrobial agents within electrospun nanofibers was reported by Fu et al., who developed PVA-alginate nanofibers embedded with moxifloxacin hydrochloride (MH), an antimicrobial agent [208]. Adding MH to the PVA-alginate blend before electrospinning increased the average fiber diameter from 148 ± 41 nm for PVA-alginate nanofibers to 175 ± 75 nm for MH-loaded fibers. Crosslinking further stabilized these fibers through exposure to glutaraldehyde vapor for one hour.
The release profile of MH from the MH-PVA-alginate nanofibers exhibited an initial burst release within the first 8 h, followed by a sustained release over the subsequent 16 h. These nanofibers demonstrated significant antibacterial activity against P. aeruginosa and S. aureus, with higher concentrations of MH correlating with an increased zone of inhibition, thereby confirming the antimicrobial efficacy of the scaffolds [208].
In addition to their antimicrobial properties, the MH-PVA-alginate nanofibers were shown to be non-cytotoxic when incubated with L929 fibroblast cells, indicating their biocompatibility. In vivo studies conducted on Sprague Dawley rats revealed that the MH-PVA-alginate nanofibers accelerated wound closure rates during the initial three to eight days post-surgery in comparison with control and commercial treatments. However, by Day 14 post-surgery, all treatment groups, including the controls and commercial dressings, achieved similar wound closure. The MH-PVA-alginate and commercial dressing-treated groups exhibited complete re-epithelialization and successful formation of hair follicles and sebaceous glands by Day 14. Additionally, neither the PVA-alginate nor the MH-PVA-alginate nanofibers caused any irritation to normal skin, further supporting their biocompatibility and suitability for in vivo wound dressing applications [208].
5.1.10. Silk Fibroin (SF)
Silk is a natural material extracted from insects, spiders, and silkworms. It primarily consists of two proteins: fibroin and sericin. Among these, silk fibroin (SF) is hydrophobic and presents appropriate mechanical properties for fiber production. Recent research has highlighted the potential of SF in the textile industry and medical and clinical fields, where its favorable physiological properties are highly valued [209].
According to Schneider et al., a silk nanofiber (NF) electrospun scaffold incorporating epidermal growth factor demonstrated a remarkable 90% improvement in wound closure in an in vivo mouse model. This study highlights the potential of silk fibroin-based scaffolds for enhancing wound healing processes [210].
Further research investigated the impact of fibroin morphology on silver ion (Ag+) release and the corresponding antibacterial activity against S. aureus, Staphylococcus epidermidis (S. epidermidis), and P. aeruginosa. Ag/fibroin composite nanofibers were produced using glutaraldehyde vapor and methanol post-treatment. The fibroin was processed into two distinct morphologies: random coil (Silk I) and β-sheet (Silk II) [211]. The study demonstrated how these structural variations influenced the release of Ag+ ions and their antibacterial efficacy.
Another investigation focused on the electrospinning of silk fibroin (SF) blended with graphene oxide to create a nanofiber scaffold with a single bioinspired nanostructure. The study comprehensively evaluated the blended nanofibers’ morphology, chemical structure, antibacterial activity, and biocompatibility. The findings indicated that these SF/graphene oxide blended nanofibers exhibit considerable promise for wound dressing applications, owing to their favorable properties [212].
Additionally, a study utilized EDC/N-hydroxysuccinimide (NHS) and thiol-maleimide click chemistry to stabilize an antimicrobial peptide molecule, Cys-KR12, derived from the human cathelicidin peptide LL37, onto electrospun SF nanofibers. This modification imparted various bioactivities of LL37 to the membranes, resulting in notable antimicrobial properties against four pathogenic bacterial strains: S. aureus, S. epidermidis, E. coli, and P. aeruginosa [213].
In another research effort, cold plasma treatment incorporated thyme essential oil (TO) into silk fibroin nanofibers to inhibit Salmonella Typhimurium bacteria [214]. Furthermore, a study investigated the incorporation of silver sulfadiazine (SSD) into silk fibroin nanofibers, which induced cytotoxic effects. Therefore, silver-based additives must be carefully considered when developing silver-release dressings. While SSD demonstrates antibacterial solid activity, its cytotoxicity highlights the challenge of balancing antimicrobial efficacy with cellular safety in wound dressing design [215].
Developing wound dressings that optimize antimicrobial properties by reducing cellular toxicity remains a significant challenge. Ongoing research aims to address this challenge by refining the formulation and incorporation techniques to produce effective, biocompatible wound care solutions [215].
Hadisi et al. developed an electrospun nanobiocomposite scaffold incorporating silk fibroin (SF), hardystonite (HT), and gentamicin (GEN), as illustrated in Figure 9 [216]. Their study focused on evaluating the antibacterial properties of these scaffolds, particularly against E. coli and S. aureus [216]. The antibacterial inhibition zone measurements demonstrated that incorporating gentamicin at concentrations ranging from 3 to 6 wt% significantly enhanced the scaffolds’ antibacterial efficacy [216].

Figure 9.
(a) Illustration of the electrospinning process of antimicrobial SF–HT–xGEN nanofibers and subcutaneous implantation in a rat model; (b) inhibition zone properties of nanofibers against E. coli and S. aureus after 24 h (S1 = SF, S2 = SF-HT, S3 = SF-HT-1GEN, S4 = SF-HT-3GEN, and S5 = SF-HT-6GEN); (c) inhibition properties of nanofibers against E. coli and S. aureus at different durations; and (d) illustration of the antibacterial mechanism of SF–HT–xGEN nanofibers. Reprinted from Ref. [216].
The observed increase in antibacterial activity was attributed to the effective diffusion of gentamicin from the scaffolds into the surrounding agar plate, which impeded bacterial growth. Gentamicin exerts its antibacterial effects by interfering with bacterial DNA and protein synthesis. Specifically, it inhibits nucleic acid replication and the synthesis of essential metabolites, disrupting bacterial cell function and leading to cell death [216].
The findings suggest that combining SF, HT, and gentamicin in electrospun scaffolds offers a promising approach to developing advanced wound dressings with enhanced antimicrobial properties. This approach could benefit applications requiring robust infection control and accelerated wound healing [216].
Shahverdi et al. investigated electrospun silk fibroin (SF) fibers and explored the potential to enhance their properties by incorporating an additional polymer, poly (lactide-co-glycolic acid) (PLGA) [217]. The study focused on various SF/PLGA blend ratios and evaluated their effects on wound healing rates. Among the tested blends, the SF/PLGA composite with a 1:2 ratio exhibited superior mechanical properties compared to pure SF and SF/PLGA blends with a 1:1 ratio. Specifically, SF/PLGA (1:2) demonstrated enhanced tensile strength and mechanical stability [217].
In vivo studies using an excision wound model in diabetic rats revealed that the SF/PLGA (1:2) scaffolds significantly improved fibroblast attachment and proliferation and markedly reduced the wound area. These results indicated a pronounced wound healing effect compared to other blend ratios and control materials [217].
Additionally, another study explored the integration of silk fibroin with polyethylenimine (PEI) to develop antibacterial bionanotextiles [218]. Bionanotextiles represent a new class of advanced wound dressing materials characterized by their high surface-area-to-volume ratio, which offers controlled release of therapeutic agents and enhanced cell adherence and proliferation. Compared to traditional wound dressings, such as hydrocolloids and hydrogels, bionanotextiles exhibit superior efficiency in promoting wound healing [218].
The SF/PEI bionanotextiles demonstrated robust antibacterial activity against S. aureus and P. aeruginosa. They effectively prevented bacterial adhesion over extended periods, highlighting their potential as an advanced wound dressing material with significant antimicrobial properties [218].
5.1.11. Elastin
Elastin, a polymeric extracellular matrix (ECM) protein prevalent in tissues such as the skin, lungs, and arteries, is increasingly utilized in wound treatment due to its exceptional elasticity, biological activity, and long-term flexibility. This material is gaining traction in tissue engineering applications. Structural proteins derived from elastin, such as hydrolyzed elastin, elastin fibers, and recombinant tropoelastin, are being explored for their potential in biomaterials. Since native elastin’s insolubility limits its direct application, soluble elastin forms have been developed to enable diverse physical forms. For instance, soluble elastin has been utilized to create hydrogels that can be electrospun into fine fibers, harnessing their elasticity and mechanical flexibility [219].
In one study, a composite scaffold incorporating triple-collagen, elastin, and polycaprolactone (PCL) was fabricated to enhance the scaffold’s mechanical properties while maintaining its biological functions, including cell adhesion, proliferation, and tissue regeneration. Including elastin in the scaffold was found to reduce stiffness, minimize hysteresis, and improve elasticity. This study suggested electrospun collagen–elastin–PCL scaffolds could significantly enhance skin cell proliferation and facilitate tissue regeneration, particularly following severe burn injuries [219].
Electrospun collagen and elastin blends have been successfully employed to produce various scaffolds. The addition of elastin to non-electrospun collagen scaffolds has been demonstrated to increase flexibility, modulate collagen contraction and degradation, and promote angiogenesis and elastic fiber formation. The combination of collagen and elastin thus improves the physical and biological properties of dermal substitutes [220].
Furthermore, the electrospinning of collagen and elastin meshes from aqueous solutions has been effectively utilized in tissue engineering applications [221]. A notable study reported the creation of an electrospun synthetic human elastin–collagen composite scaffold for dermal tissue engineering. The study examined blends of electrospun human tropoelastin and ovine type I collagen in varying ratios (80/20, 60/40, and 50/50 wt%) [222].
Additionally, Cao et al. developed composites of chitosan (CS) and elastin with small intestinal submucosa (SIS) using electrospun CS/elastin nanofibers (Figure 10I) [223]. The resulting CS/ES-SIS composites were characterized by a pristine white and smooth appearance, in contrast to the uneven texture of SIS (Figure 10II) [223]. The top surface of the CS/ES-SIS composites exhibited high porosity, interconnectivity, and microscale interstitial spaces (Figure 10III) [223]. Antibacterial testing revealed that SIS alone lacked significant antibacterial activity, whereas CS-SIS and CS/ES-SIS composites demonstrated distinct inhibitory zones against E. coli and S. aureus (Figure 10IV) [223]. The CS-SIS composites showed slightly superior antibacterial activity to the CS/ES-SIS composites, likely due to the higher chitosan concentration. The composites exhibited enhanced antibacterial efficacy against E. coli compared to S. aureus [223].
Figure 10.
(I) Demonstration of the fabrication of CS/ES–SIS composites; (II) macroimages of SIS and CS/ES–SIS composites, scale bar: 1 cm; (III) SEM image of the composite; and (IV) antibacterial properties of (a) SIS, (b) CS–SIS, and (c) CS/ES–SIS composites against E. coli and S. aureus. Reprinted from Ref. [223].
5.2. Electrospinning of Synthetic Polymers for Wound Healing
5.2.1. Poly (Vinyl Alcohol) (PVA)
PVA is a synthetic polymer noted for its biocompatibility, biodegradability, water solubility, and nontoxicity, making it a versatile material for various biomedical applications. PVA fibers, commercially available since the 1950s, exhibit excellent fiber shape and hydrophilicity. Recent advancements have focused on fabricating and synthesizing PVA-based nanofibers (NFs) through blending or composite methods to enhance their functionality for specific applications [224].
One notable approach involves coating PVA electrospun fibers with chitosan (CS) to impart additional properties. This is achieved by immersing the electrospun PVA mat in a solution containing 1.0 wt% CS at 30 °C for 1 h [225]. This coating method simplifies the process and provides a CS layer that more closely resembles glycosaminoglycans in the extracellular matrix (ECM) compared to pure PVA or PVA–CS blend fibers [225].
Another strategy involves using PVA as a reducing and stabilizing agent in synthesizing silver nanoparticles (AgNPs). AgNPs in PVA fibers, subjected to heat treatment, effectively led the nanoparticles to the fiber surface, enhancing the antibacterial activity [226].
The design of drug delivery systems using PVA is also a significant area of research. Jannesari and colleagues developed PVA/poly (vinyl acetate) (PVAc) composite NF mats loaded with ciprofloxacin HCl [227]. By increasing the drug loading from 5 to 10 wt%, they achieved a burst release rate. The presence of PVAc, a hydrophobic polymer, influenced the migration of the hydrophilic drug to the fiber surface, preventing the burst release [227].
Taepaiboon et al. investigated how the molecular weight of model drugs affects the release rate and overall amount of drugs from PVA mats [228]. He et al. explored the drug-loading capacity of polyvinylidene fluoride (PVDF) fibrous membranes incorporating enrofloxacin for wound dressing applications [229]. Their findings highlighted the effectiveness of core–shell and core–multi–sheet nanofibers in encapsulating therapeutic agents.
Natural NFs have also been explored for drug delivery systems. Recent research on electrospun natural NFs revealed that these mats exhibited excellent cell compatibility and minimal cytotoxicity when loaded with essential oils. Furthermore, even small amounts of essential oils effectively inhibited the growth of E. coli, underscoring their potential for promoting skin wound healing (Figure 11) [230].
Figure 11.
(a) Multiaxial electrospinning setup for DDSs and (b) illustration of an antibacterial mechanism for skin wound healing, Reprinted from Ref. [230].
In a study by Lan et al., coaxial electrospinning was used to fabricate PVA/polycaprolactone (PCL) NFs with dual-release capabilities for tea polyphenols and ε-poly(L-lysine) (ε-PL) [231]. Antibacterial tests against E. coli and S. aureus demonstrated significant antibacterial activity due to ε-PL’s ability to lyse bacterial cell walls and membranes (Figure 12a,b) [231].

Figure 12.
(a) Illustration of producing coaxial NFs. (I) Coaxial electrospinning is used to fabricate tea polyphenols-infused PVA/PCL coaxial NFs and -ε-PL. (II) Antioxidant and antibacterial properties of coaxial NFs and (b) antibacterial activity of coaxial NFs against (b1) E. coli and (b2) S. aureus. Reprinted from Ref. [231].
Another study examined the antibacterial effects of PVA–berberine (Ber) NFs and PVA–berberine–hydroxypropyl–cyclodextrin inclusion complex (Ber–IC) NFs. Results showed that both PVA–Ber–NF and PVA–Ber–IC–NF exhibited significant antibacterial activity against E. coli and S. aureus. Notably, PVA–Ber–IC–NF demonstrated enhanced antifungal effects compared to PVA–Ber–NF, attributed to the higher affinity of 2-hydroxypropyl-β-cyclodextrin (HP-β-CD) for cells, facilitating the release and diffusion of Ber (Figure 13) [232].
Figure 13.
Antibacterial properties of (a) PVA, (b) PVA–Ber–NF 0.5%, (c) PVA–Ber–NF 1%, (d) PVA–Ber–NF 1.5%, (e) PVA–Ber–IC–NF 0.5%, (f) PVA–Ber–IC–NF 1%, and (g) PVA–Ber–IC–NF 1.5%. Reprinted from Ref. [232].
PVA/Gum Tragacanth
Gum tragacanth (GT), a natural gum derived from plant exudates, is an acidic biopolymer composed of two main polysaccharides: tragacanthin, which is highly water-soluble with a high molecular weight, and a complex of methoxylated acids that is water-insoluble but capable of swelling and forming gels [233,234].
Ranjbar-Mohammadi et al. investigated the potential of GT in wound dressing applications by preparing polyvinyl alcohol (PVA)/GT nanofibers through electrospinning [235]. The study focused on optimizing the concentration of GT in the PVA solution to achieve uniform, bead-free nanofibers. To enhance the water resistance of these fibers, the prepared nanofibers were exposed to saturated glutaraldehyde vapors [236].
The evaluation of PVA/GT nanofibers included antibacterial and cell proliferation assays. The results demonstrated that PVA/GT nanofibers exhibit notable antibacterial activity against Pseudomonas aeruginosa, a Gram-negative bacterium known for its severe infections and multidrug resistance. However, these nanofibers did not show antibacterial activity against Gram-positive bacteria. Additionally, MTT assays confirmed that the PVA/GT nanofibers are biocompatible, exhibiting good cell viability, suggesting their potential suitability for wound dressings [235].
Overall, integrating GT with PVA in electrospun nanofibers shows promise for developing advanced wound dressings, particularly for managing infections caused by resistant Gram-negative bacteria, while maintaining favorable biocompatibility for effective wound healing.
PVA/Keratin
Keratin is a natural protein characterized by its disulfide bonds and high cysteine content. It occurs in various forms: α-keratin (present in animal hair, wool, and hooves), β-keratin (in claws, feathers, and beaks), and γ-keratin (in human hair). Despite its biocompatibility, biodegradability, and natural abundance, pure keratin exhibits suboptimal mechanical properties. Keratin is often combined with other polymers to enhance these properties and improve processability [237].
In a recent study, Park et al. explored the combination of keratin with polyvinyl alcohol (PVA) to improve the functional properties of keratin-based nanofibers [238]. They utilized keratin extracted from human hair and blended it with PVA to create nanofibers through electrospinning. The process involved varying the concentration of keratin in the PVA solution, with PVA maintained at 10 wt% under controlled acidic pH conditions. To enhance the water resistance of the hydrophilic PVA nanofibers, they were crosslinked using glyoxal at different concentrations [238].
Figure 14 presents SEM images of the electrospun human keratin/PVA nanofibers, illustrating the impact of glyoxal concentration on fiber morphology. The electrospinning parameters were set at 18 kV with a 16 cm working distance, resulting in nanofibers with diameters ranging from 100 to 300 nm. The study found that increasing the concentration of glyoxal improved the uniformity of the nanofibers, yielding bead-free structures and enhancing thermal stability [238].
Figure 14.
SEM images for PVA and human-based keratin nanofibers. Images show (A) keratin nanofibers mixed with PVA, (B) produced nanofibers after dipping in 3 wt% glyoxal, (C) produced nanofibers after dipping in 6 wt% glyoxal, and (D) produced nanofibers after dipping in 12 wt% glyoxal. Reprinted from Ref. [238].
The glyoxal concentration influenced the antibacterial properties of the keratin/PVA nanofibers. Nanofibers with lower to intermediate glyoxal content demonstrated antibacterial activity against S. aureus, a Gram-positive bacterium. However, nanofibers with the highest glyoxal concentration showed no antibacterial effect, likely due to the strong interactions between PVA, keratin, and glyoxal. This interaction may have interfered with the antibacterial mechanisms. The nanofibers did not exhibit antibacterial activity against E. coli, a Gram-negative bacterium, potentially due to inherent cellular content and structural differences between Gram-positive and Gram-negative bacteria [238].
Overall, blending keratin with PVA and optimizing the crosslinking process with glyoxal significantly impacts the physical and biological properties of the resulting nanofibers, offering potential applications in fields requiring enhanced material performance and specific antibacterial properties.
5.2.2. Poly (Vinyl Pyrrolidone) (PVP)
Poly (vinyl pyrrolidone) (PVP K-30) is renowned for its film-forming and viscosity-enhancing properties, making it an essential polymer in various commercial and biomedical applications. Its low chemical toxicity and biocompatibility make it suitable for hair sprays, shampoos, eye makeup, lotions, and sunscreens [239,240]. Additionally, PVP K-30 reacts with iodine to form a PVP-iodine (PVP-I) complex, which acts as an iodophor, releasing active iodine and serving as an effective antimicrobial agent [241].
Gökmeşe et al. explored the synthesis of nanofibers from a blend of poly (vinyl alcohol) (PVA) and PVP K-30, creating three types of nanofiber mats: PVA/PVP with 5% chitosan, PVA/PVP with 10% chitosan, and PVA/PVP-iodine fibers [241]. The addition of chitosan to the polymer blend increased the solution’s viscosity and conductivity, leading to the formation of finer and more uniform nanofibers. This modification improved the electrospinning process, resulting in bead-free fibers. In contrast, introducing iodine influenced the nanofiber morphology, causing bead formation due to the reduced conductivity of the iodine-containing solution compared to the chitosan-enriched blends [241].
Aytimur et al. investigated the PVA/PVP-I blend with additional polymers, specifically Poloxamer 188 (P188) and chitosan [242]. Poloxamer 188, a triblock copolymer with a central hydrophobic poly(oxypropylene) chain and flanking hydrophilic poly(oxyethylene) chains, is used to modify viscosity in various formulations and has shown potential in aiding cellular membrane repair [243]. The study found that chitosan addition resulted in a more compact and fibrous nanofiber structure with a diameter of 374 nm, enhancing fiber formation. Conversely, the presence of P188 led to a more porous and beaded nanofiber structure with a diameter of 489 nm, influenced by P188′s effects on the solution properties and electrospinning process [243].
These studies highlight the substantial impact of various additives on the properties of PVA/PVP-based nanofibers. Chitosan improves fiber compactness and reduces diameter, while Poloxamer 188 induces bead formation and increases diameter.
5.2.3. Poly (Acrylic Acid) (PAA)
Poly (acrylic acid) (PAA) is a water-soluble, biocompatible polymer that has been extensively utilized as a carrier for proteins, enzymes, and various biologically active substances [244,245]. Its superabsorbent properties also make it suitable for water-soluble drug applications [245].
In 2014, Aytimur and Uslu successfully fabricated a polyvinyl alcohol (PVA)/PAA nanofiber mat, utilizing the blend as a primer solution to create three additional nanofiber mats: PVA/PAA/polyvinylpyrrolidone (PVP), PVA/PAA/PVP-iodine (PVP-I), and PVA/PAA/chitosan [241]. Their study revealed that incorporating PVP and PVP-I enhanced the thermal stability of the resulting nanofibers. The morphology of the PVA/PAA nanofibers exhibited linear, beadless fibers with diameters averaging 485 nm. However, introducing PVP, PVP-I, and chitosan into the blend reduced fiber diameter to 237 nm, 139 nm, and 279 nm, respectively, albeit with the formation of beads [241].
In a subsequent study, Aytimur et al. explored the preparation and characterization of two additional polymer blends, PVA/polyethylene glycol (PEG) and PVA/polypropylene glycol (PPG), focusing on their biological properties. PEG and PPG are water-soluble, exhibiting low toxicity and antigenicity [246]. The significance of these additions lies in PPG’s ability to function as a plasticizer and PEG’s role as an anti-crosslinking agent, particularly relevant in sterilizing wound dressing materials via ionic radiation, which typically induces covalent bonding of polymeric chains.
The study demonstrated that PVA/PEG nanofibers, produced at varying concentrations, showed agglomeration of very porous fibers with irregular shapes. A similar outcome was observed for PVA/PPG nanofibers, except in the case of PVA blended with 50% PPG, which resulted in beadless fibers ranging from ribbon-like to uniform, with a mean diameter of 1.082 μm [246].
5.2.4. Polycaprolactone (PCL)
Polycaprolactone (PCL) is utilized in tissue regeneration due to its mechanical properties, biocompatibility, and cost-effectiveness. However, PCL has inherent limitations as a synthetic biomaterial, such as a hydrophobic surface and the absence of functional groups, which reduce its effectiveness as a cell adhesion substrate. Various strategies have been employed to address these limitations to enhance PCL nanofiber scaffolds’ hydrophilicity and biological characteristics, including incorporating antimicrobial properties [247].
The development of electrospun mats with optimized properties for biomedical applications, such as tissue regeneration, has been extensively investigated. These mats exhibit porosity with average pore sizes that resemble those found in human tissues. The fabrication process typically involves the generation of bioactive particles through electrospinning, followed by their integration into a biocompatible polymer matrix like PCL. Despite its benefits, PCL’s low stiffness, hydrophobicity, and limited bioactivity pose challenges for its use in advanced biomedical applications [247].
Nonetheless, combining PCL with bioactive materials in electrospinning has garnered significant interest in creating new membranes with enhanced cell proliferation and wound healing capabilities [248,249]. For instance, Miguel et al. investigated aloe-vera-derived nanofiber materials, which were processed through electrospinning for applications in skin regeneration and wound healing [250]. These electrospun membranes have been shown to promote rapid cell proliferation and migration, which are crucial for effective wound healing. Additionally, the antimicrobial properties of these mats are essential for their function as wound dressings [250].
In medical applications, PCL fibers must be free of beads, as the fiber diameter must closely mimic the natural extracellular matrix to support optimal cell growth. During the electrospinning of PCL, various solvents such as chloroform, methanol, dimethylformamide, dichloromethane, or combinations thereof have been employed [251,252,253]. Introducing functional groups to the polymer can further improve its adhesive, hydrophilic, and biocompatible properties, enhancing cellular responses. Consequently, PCL is used in various medical devices, including sutures, wound dressings, and dental applications, where these modified properties are crucial for performance [253,254,255].
5.2.5. Poly (Lactic Acid-Co-Glycolic Acid) (PLGA)
Poly (lactic-co-glycolic acid) (PLGA) is a biodegradable synthetic polymer with excellent biocompatibility, making it highly suitable for various biomedical applications. Compared to natural polymers, PLGA offers several advantages, including a lower cost, a well-defined structure with predictable degradation kinetics, greater mechanical properties that facilitate electrospinning, and the presence of lactate as a degradation byproduct, which has been shown to promote wound healing [256,257].
Fusidic acid, a protein derived from fungi, has been incorporated into PLGA fibers to promote antimicrobial properties. These fibers were designed to release the drug in response to the severity of the wound, targeting infected wounds [258]. Studies have demonstrated that when these fibers were incubated with overnight cultures of wound bacteria (107 CFU mL−1), significant bacterial colonization and dense biofilm formation occurred on the fiber mats [259]. This was linked to a marked increase in the initial release of fusidic acid, which effectively eliminated planktonic bacteria and significantly reduced biofilm formation. This interaction between the dressing material and the wound environment may have important therapeutic implications, as the pristine fibrous mats could inhibit the spread of infection by sequestering bacteria. However, there is a potential risk of reinfection if the wound is not adequately managed [259].
The structural integrity and drug release capabilities of biomaterials like PLGA can be compromised by enzymes and toxins generated by colonizing bacteria [259]. To address these challenges, a study developed a wound dressing based on PLGA and aloe vera, incorporating nanostructured lipid carriers (NLCs) [257]. These included NLCs aimed at preventing the dressing from adhering to the wound and improving its handling properties [259].
Several other studies have explored the antimicrobial and cytocompatibility properties of PLGA-based nanofiber (NF) scaffolds. For example, PLGA/CuO hybrid NF scaffolds have been tested for their antimicrobial effects against various bacterial strains and their interactions with fibroblasts, demonstrating potential as internal and external wound dressings [260]. The electrospinning technique has also been employed to fabricate and characterize biodegradable scaffolds composed of a PLGA NF matrix reinforced with silver nanoparticles (Ag NPs) without foreign-reducing agents. These scaffolds exhibited favorable morphological and thermal properties, suggesting their potential application as antimicrobial agents in biomaterials or water purification systems [261,262].
Further research has shown that PLGA–HACC fibrous membranes possess good cytocompatibility, significantly enhancing the adhesion, spreading, and proliferation of human dermal fibroblasts (HDFs) and HaCaT cells. The wound-healing efficacy of PLGA–HACC was validated in a full-thickness excision wound model using S. aureus-infected mice, indicating that PLGA–HACC could be a promising therapeutic biomaterial for treating infected wounds [262].
In another study, electrospun PLGA nanofibers containing the antibiotic chloramphenicol were evaluated for their ability to control bacterial growth. These fibers inhibited the growth of E. coli, B. cereus, and S. typhimurium by over 93% in liquid culture. However, P. aeruginosa and S. aureus inhibition was less pronounced at 42% and 56%, respectively, highlighting the varying efficacy of PLGA-based antibiotic delivery systems against different bacterial strains [263].
The analysis of PLGA–HACC membranes revealed a significantly lower presence of living bacteria (indicated by green fluorescence) compared to PLGA and PLGA–chitosan (CS) membranes. This suggests that the PLGA–HACC membranes were much more effective in preventing bacterial adhesion and survival. A high density of dead bacteria (shown by red fluorescence) on the PLGA–HACC membranes further indicated that the bacteria present were largely non-viable, implying effective antibacterial activity (Figure 15a) [262].
Figure 15.
(a) Confocal laser scanning microscopy (CLSM) images of S. aureus and P. aeruginosa bacteria grown on PLGA, PLGA–CS, and PLGA–HACC nanofiber surfaces after 24 h. (b) SEM images of S. aureus and P. aeruginosa bacteria grown on PLGA, PLGA–CS, and PLGA–HACC nanofiber surfaces after 24 h. (c) Photos of S. aureus and P. aeruginosa bacteria formed after 24 h incubation on PLGA, PLGA–CS, and PLGA–HACC nanofibers. (d) Quantity evaluation of adhered bacteria on nanofiber samples after 24 h of incubation; ## denotes p < 0.01, and ** in the figure denotes p < 0.05. Reprinted from Ref. [262].
Scanning electron microscopy (SEM) micrographs provided additional insight into the bacterial morphology of the different membrane types (Figure 15b). S. aureus and P. aeruginosa exhibited greater adhesion to the PLGA membranes than the PLGA–CS and PLGA–HACC membranes. Bacterial adhesion was also reduced on the PLGA–CS membranes relative to the PLGA membranes. On the PLGA–HACC membranes, S. aureus and P. aeruginosa were sparsely distributed across the surface, indicating a significant reduction in bacterial colonization [262].
Quantitative assessments confirmed that S. aureus and P. aeruginosa were substantially less abundant on the PLGA–HACC membrane surfaces than on the PLGA and PLGA–CS membrane surfaces (Figure 16a,b). This data underscores the enhanced antibacterial properties of PLGA–HACC membranes, making them a promising material for applications where infection prevention is critical [263].
Figure 16.
The antibacterial property of optimal scaffold with different concentrations of AgSD (0.25%, 0.5%, and 0.75%) against (a) E. coli and (b) Bacillus bacteria. Optimal mat: EC/PLA (70:30)—collagen (10 wt%), AgSD: silver sulfadiazine. Reprinted from Ref. [124].
5.2.6. Poly (Lactic Acid) (PLA)
Polylactic acid (PLA) is a biocompatible synthetic polymer composed of lactic acid, renowned for its remarkable biodegradability and high bioresorbability, which allows it to be absorbed by the body while providing space for tissue expansion [264,265]. PLA’s potential in biomedical applications is further highlighted by numerous reports demonstrating its ability to assist in antimicrobial activities and support other therapeutic uses. Its selection as a core material for coaxial electrospinning is driven by its non-toxicity, superior mechanical properties, and excellent fiber-forming capability [266].
In a study by Spasova et al., PLA and PLA/polyethylene glycol (PEG) wound healing mats were electrospun and coated with chitosan (CS) to induce immediate hemostatic activity [267]. Similarly, Nguyen et al. used coaxial electrospinning to reinforce the CS shell with PLA as the core, resulting in a material that exhibited strong antimicrobial activity against E. coli, indicating its potential for use in both biomedical and filtration applications [268].
The large porosity and specific surface area of biocompatible PLA nanofibers (NFs) make them ideal carriers for bioactive compounds like curcumin, which possesses antioxidation, anticancer, anti-inflammatory, and wound healing properties. One study showed that curcumin-loaded PLA NFs were nontoxic and effective as wound healing patches [268]. In another research effort, coaxial electrospinning was used to create NFs with a poly (γ-glutamic acid) (γ-PGA) core and a PLA shell, a configuration proposed for tissue engineering and wound healing applications [269].
Further research demonstrated the versatility of PLA in encapsulating therapeutic substances. For example, composite NFs made from polyvinylpyrrolidone (PVP)/PLA–polyethylene oxide (PEO) encapsulating collagen and cefazolin were fabricated using coaxial electrospinning. The antibacterial efficacy of these scaffolds was confirmed against E. coli, S. aureus, and P. aeruginosa using the disk diffusion method, showing significant antimicrobial properties [270].
Karami et al. developed thymol-loaded hybrid PLA/polycaprolactone (PCL) NFs and evaluated their antibacterial properties against S. aureus and E. coli in vitro and in vivo [271]. The hybrid NFs enhanced wound healing and histological efficiency, outperforming traditional wound care products.
In another study, herbal extracts from plants indigenous to Türkiye were incorporated into electrospun polymeric NFs for medical applications. Extracts of Satureja hortensis (SH), Agrimonia eupatoria (AE), and Hypericum perforatum (HP) were loaded into NFs made from thermoplastic polyurethane (TPU), PLA, and PCL polymers. The resulting composite NFs exhibited strong structural integrity and morphology, with TPU/SH composite NFs showing the greatest polymer–extract compatibility due to their antibacterial behavior and NF morphology. This research underscores the potential for developing rapid prototyping strategies for wound dressings with customizable antimicrobial and morphological properties based on the choice of polymer and herbal extract [272].
Moreover, PLA has been utilized as a host matrix for hydrotalcite ((Mg–Al) LDH) to achieve an antibacterial structure capable of delivering silver sulfadiazine (SSD) from electrospun scaffolds designed for wound healing. The combination of PLA and SSD, embedded within the (Mg–Al) LDH matrix, demonstrated inhibitory activity against E. coli and S. aureus in vitro, while maintaining excellent biocompatibility with human cells. The multifunctionality of PLA/SSD-(Mg–Al) LDH scaffolds makes them highly suitable for various transdermal applications [273].
In conclusion, PLA is a versatile, bioabsorbable, and biodegradable polymer with outstanding biocompatibility. Its ability to integrate a wide range of active agents, including antimicrobial substances, positions it as a promising material for preventing bacterial infections in external wounds and other biomedical applications.
5.2.7. Poly (L-Lactic Acid) (PLLA)
Poly (L-lactic acid) (PLLA) is a significant polymer material highly valued for its biodegradability and biocompatibility. Under normal physiological conditions, PLLA undergoes hydrolysis within the body, breaking down into its constituent monomers, lactic acid and glycolic acid, which are naturally occurring byproducts of various metabolic pathways. Due to these properties, PLLA-based materials have found extensive application in the biomedical and biological fields [274].
For instance, Leo’s research group developed ibuprofen-loaded PLLA microspheres and investigated their drug release characteristics, resulting in a controlled therapeutic delivery system [274]. The results demonstrated the effectiveness of PLLA as a wound dressing substrate material. In another study, biodegradable PLLA scaffolds with a well-connected macroporous and nanofiber architecture effectively prevented bacterial growth, further supporting their use in wound care applications [275].
Zeng et al. conducted research in which electrospun PLLA fiber mats were used to encapsulate two chemotherapeutic agents with different solubilities: paclitaxel, a lipophilic drug, and doxorubicin HCl, a hydrophilic drug. The study found that the compatibility of the drug with the polymer matrix and the polymer degradation rate were critical factors influencing the drug release profile [276]. Paclitaxel was encapsulated within the PLLA nanofiber mats, while doxorubicin HCl was located on or near the fiber surface. As anticipated, a burst release of doxorubicin HCl was observed, whereas paclitaxel exhibited a zero-order release profile, indicating a sustained and controlled drug delivery system [276].
Further advancing the versatility of PLLA, another study employed electrospinning to create nitrofurazone (NFZ)-loaded PLLA/sericin dual-layer fiber mats. The incorporation of sericin enhanced the hydrophilic properties of the mats. At the same time, the addition of the antibiotic NFZ significantly increased the antibacterial activity against both E. coli (a Gram-negative bacterium) and B. subtilis (a Gram-positive bacterium), compared to fibers lacking the drug [274,276].
In another innovative approach, PLLA–PEG–NH2 and PLLA emulsions were electrospun into core-sheath nanofibers. Following two functionalization reactions, these fibers retained their antimicrobial properties, demonstrating the potential to develop multifunctional nanofibers for use in wound dressings, periodontal membranes, or more complex tissue systems requiring multiple growth factors and anti-infection measures to ensure optimal tissue implantation and regeneration [277].
A biocompatible zinc prolinate catalyst was developed to produce high-molecular-weight PLLA (>100,000) and PLLA-ciprofloxacin composites. Ciprofloxacin, an antibiotic, was covalently bonded to the functional domains of PLA through the ester linkage with the piperazine ring. The ciprofloxacin-loaded PLLA nonwoven nanofibers exhibited structural integrity and potent antimicrobial activity against S. aureus and E. coli in both static (agar) and dynamic (liquid) environments [278]. These findings highlight the potential of PLLA nanofibers as practical wound coverings with inherent antimicrobial properties [278].
Ahmadian et al. demonstrated the potent inhibitory activity of electrospun ethyl cellulose (EC)/poly (lactic acid) (PLA)/collagen nanofibers (NFs) loaded with silver sulfadiazine (AgSD) against B. coli and E. coli bacteria using the disc diffusion method, as illustrated in Figure 16 [124]. The figure highlights that the NFs without AgSD (control group) exhibited no antibacterial effect against the bacteria after 24 h of incubation. However, upon loading AgSD into the nanofiber mats, a significant antibacterial effect was observed, particularly in mats containing 0.75% AgSD, which showed substantially larger inhibitory zones than mats with lower AgSD concentrations for both bacterial strains.
The antibacterial activity is attributed to the release of Ag+ ions from AgSD, which increases the permeability of the mats, allowing the ions to penetrate the bacterial cell walls. All Ag-coated electrospun NFs demonstrated significant antibacterial activity against E. coli and S. aureus, as evidenced by the clear inhibitory zones surrounding the Ag-coated patches shown in Figure 17 [279]. In contrast, as expected, the uncoated mats did not display any antibacterial effect.
Figure 17.
(a) Illustration of optical images of agar cultural experiments with E. coli and S. aureus bacteria were tested on uncoated reference (the left patches) and coated electrospun nanofibers (right patch) and (b) inhibition zones after 24 h of incubation with E. coli and S. aureus (* p < 0.05) (duration of deposition was 40 min for Ag–U and Ag–PA samples while it was 20 min for Ag–PLLA). Reprinted from Ref. [279].
Notably, the study found that the antibacterial efficacy against S. aureus was higher than against E. coli. Additionally, among the tested materials, Ag-aliphatic polyamide (PA 6.6) exhibited superior antibacterial activity against E. coli compared to Ag-polyurethane (PEU) and Ag–PLL. However, all coated mats showed similar antibacterial effectiveness against S. aureus [279].
Furthermore, an inhibition halo around the Ag-coated patches indicated that the antibacterial activity was not limited to direct contact with the bacterial membrane. Instead, it also involved a diffusion-driven process where silver ions were dispersed into the surrounding area of the patch. This diffusion mechanism suggests that Ag-coated NFs have the potential to provide a broad-spectrum antibacterial barrier, making them highly effective in wound care and other biomedical applications [279].
5.2.8. Poly (Ethylene Oxide) (PEO)
Poly (ethylene oxide) (PEO) is renowned for its efficacy as a hydrophilic carrier for active ingredients at the nanoscale [280,281,282]. Its minimal interference with plates and plasma proteins, attributed to water interaction and steric exclusion, provides an advantageous environment for healing diabetic foot ulcers (DFUs) [283,284]. This characteristic makes PEO particularly valuable in biomedical applications.
Integrating PEO into other materials, such as cyclodextrin and chitosan, which inherently possess poor electrospinning properties, has significantly improved the fabrication of long, bead-free nanofibers [285]. This supports the structural integrity and functionality of the nanofibers. Additionally, incorporating aqueous PEO solutions stabilizes brittle biomaterials within the core–shell configuration of coaxial nanofibers [286].
Further investigation reveals that increasing the ratio of PEO leads to an improved morphology of nanofibers, as seen in the SEM images [287]. This enhancement is linked to PEO’s molecular chain orientation and crystallinity. Moreover, factors such as constrained annealing and solvent properties also contribute to the PEO-based fiber production [288].
6. Classification of Nanofiber-Based Wound Dressing
The classification of nanofibers is primarily based on their cladding structure, with the main categories being uniaxial, coaxial, and tri-axial nanofibers. Among these, uniaxial nanofibers are commonly fabricated using a straightforward electrospinning technique. This method is favored due to its simplicity in geometry and reduced complexity in processing parameters compared to more advanced electrospinning modifications.
Uniaxial nanofibers can be further categorized into five distinct types:
- Polymer Nanofibers: Comprising either pristine natural or synthetic polymers.
- Polymer Blend Nanofibers: Formed from a mixture of two or more polymers.
- Biological Molecule-Embedded Polymer Nanofibers: Incorporating biological molecules such as growth factors or cells into the polymer matrix.
- Drug-Embedded Polymer Nanofibers: Featuring drugs embedded within a polymer matrix, which may include materials like chitosan, polyvinyl alcohol (PVA), polycaprolactone (PCL), polylactic acid (PLA), among others.
- Hybrid Nanofibers: Comprising a combination of drugs or a mixture of drugs and biological molecules embedded within the nanofiber structure.
This classification framework offers a comprehensive understanding of the diverse structures and functionalities that nanofibers can possess [286,287,288].
6.1. Uni-Axial Nanofibers
6.1.1. Polymer Nanofibers
Polymer nanofibers fabricated through the facile electrospinning technique, particularly biopolymers, offer notable advantages such as ease of processing, excellent biocompatibility, and non-toxicity. Additionally, specific polymers, like cellulose acetate, inherently possess antibacterial properties without requiring the addition of antibacterial agents. For instance, Yoshioka et al. reported that after methanol treatment, Bombyx mori silk nanofibers, with 180 to 260 nm diameters, exhibited enhanced mechanical properties. Specifically, the yield strength increased from 33.6 MPa to 96.1 MPa, and Young’s modulus improved from 1.4 GPa to 3.2 GPa. However, the fracture strain decreased from 8.7% to 3.7%, indicating a trade-off between strength and flexibility [289].
In another study, Uppal et al. investigated the influence of electrospinning parameters on the diameter of HA fibers. They showed that a lower flow rate (0.1 mL/h) and shorter spin length (2.5 cm) produced thin nanofibers with diameters as small as 58 nm. Furthermore, they observed that the air permeability of hyaluronic acid nanofibers (1642.5 m3/h/m2) significantly exceeded that of gauze with Vaseline (334.7 m3/h/m2), a characteristic that promotes wound healing by facilitating oxygen exchange [70].
Kim et al. successfully replicated the pattern of human skin using a conductive mold, creating a more conducive environment for wound healing. Their 14-day in vitro tests demonstrated that the nanofiber mats supported cell proliferation for up to 7 days, resulting in effective wound healing with minimal scar formation [89].
Augustine et al. fabricated a poly(ε-caprolactone) (PCL) scaffold via electrospinning to investigate wound healing and the mechanisms of cell proliferation [290]. Tensile tests indicated that a 15 wt% PCL solution exhibited a higher modulus (3.84 ± 0.25 MPa) than a 5 wt% PCL solution (2.46 ± 0.26 MPa). Wettability studies further revealed that PCL had a water contact angle of 122 ± 5°, which decreased to 72 ± 5° after 30 days of immersion in simulated body fluid. PCL also demonstrated excellent cell attachment, migration, and proliferation of fibroblast cells, facilitating faster wound healing by guiding cells to the wound center [290].
Ishii et al. examined the effectiveness of stereocomplexed PLA nanofibers, composed of poly(L-lactide) and poly(D-lactide), compared to poly(L-lactide) (PLLA) nanofibers [291]. Post-in vivo analysis revealed that the numerical average molecular weight (Mn) of stereocomplexed PLA remained nearly unchanged, whereas the Mn of PLLA decreased significantly from 3.8 × 105 to 1.8 × 105. Additionally, the swelling of stereocomplexed PLA was lower than that of PLLA, indicating slower degradation in vitro [291].
Cellulose acetate, long used for filtration purposes, was also studied by Rieger et al. for its ability to transport microorganisms [92]. They spun cellulose acetate nanofibers and compared their performance with commercial products such as Fisherbrand fabric and Sartorius membranes. The adsorption coefficient (Keq) of microorganisms (E. coli K12) was significantly higher in nanofiber mats (420) compared to Fisherbrand fabric (9.24) and Sartorius membranes (0.67). This suggests that polymer nanofibers can enhance bacterial resistance by blending polymers with higher antibacterial resistance, making them effective in environments with high bacterial counts [291].
6.1.2. Nanofibers of Polymer Blends
Polymer blend nanofibers are a strategy for designing formulations tailored to specific applications. By adjusting the polymer content and selecting particular polymers, these blends can achieve unique properties, making them highly customizable for various uses. For example, Yeo et al. successfully fabricated collagen and silk fibroin blend nanofibers, where crosslinking with glutaraldehyde vapor stabilized the collagen, and crystallization into a β-sheet structure stabilized the silk fibroin using water vapor. Their findings revealed that hybrid nanofibers exhibited superior cellular behavior and cytocompatibility compared to blend nanofibers when seeded with fibroblasts and normal human epidermal keratinocytes [292].
Datta et al. developed nanofiber mats composed of gelatin and oleoyl chitosan (chitosan grafted with a C18 oleoyl chain) that demonstrated excellent in vitro cytocompatibility, mainly when used with human amniotic membrane-derived stem cells, showing improved cell proliferation and adhesion. Their wettability studies revealed that increasing the concentration of oleoyl chitosan raised the contact angle from 36° to 80° and reduced the swelling of the nanofiber mats compared to pure gelatin nanofibers, which showed a swelling range of 420% to 380% [293].
Dongargaonkar et al. created a blend of gelatin and gelatin-dendrimer conjugates (highly branched polyamidoamine) and incorporated silver acetate. They treated the nanofibers with photoreactive PEG diacrylate to form semi-interpenetrating networks. These nanofibers degraded entirely within 24 h, but only 8–13% of the silver was released over 48 h. This slow release, attributed to the electrostatic interaction between silver and dendrimer conjugates, provided resistance against S. aureus and P. aeruginosa [294].
Pakravan et al. investigated chitosan/polyethylene oxide (PEO) blend nanofibers, finding that the chain stiffness of chitosan affected processability. They blended chitosan with 10 wt% PEO to address this, where strong hydrogen bonding facilitated electrospinning. Higher chitosan content promoted the formation of ultrathin nanofibers, with diameters ranging from 123 nm to 63 nm [295].
Zhang et al. also fabricated electrospun chitosan/PVA nanofibers that demonstrated improved wound healing with enhanced cell adhesion and proliferation, confirming the scaffold’s biocompatibility. The accelerated wound healing was attributed to the nanofibers’ higher blood absorption capacity, which supported homeostasis and tissue regeneration [296].
Zhou et al. studied chitosan/PVA nanofibers crosslinked with aqueous glutaraldehyde solution. These crosslinked nanofibers were non-toxic to L929 cells and exhibited good in vitro biocompatibility. An equal content of chitosan and PVA in the blend was optimal for cell adhesion after 48 h of cell culture [297].
Further research by Ignatova et al. explored the blend of poly[(L-lactide)-co- (D, L-lactide)] (PLA) with chitosan (Ch) and quaternized chitosan (QCh). They verified that the QCh/PLA nanofiber mat and film exhibited antibacterial activity against S. aureus and E. coli cells. The equilibrium swelling degree in water for QCh/PLA and Ch/PLA was 160% and 170%, respectively [298].
Ashraf et al. developed a blend of PVA and polyhydroxybutyrate (PHB) nanofibers (50:50) and investigated the effects of varying polymer ratios. By tuning the PVA concentration in the blend, specific cell proliferation was promoted; for example, the 50:50 PVA/PHB blend promoted human keratinocyte cell growth and inhibited dermal fibroblast cells, while the 5:95 blend promoted fibroblast growth and inhibited keratinocyte proliferation [299].
Aytimur et al. created PVA/PEG and PVA/PPG blends as novel matrices for wound dressing applications. SEM micrographs showed that PVA/PPG (75:25) and PVA/PEG (75:25) supported higher colonization against E. coli than 50:50 blends. Additionally, PVA/PPG (50:50) exhibited a bead-free and uniform diameter (1.082 μm), making it well-suited for wound dressing applications [300].
Park et al. developed a biomimetic poly (glycolic acid) (PGA)/chitin blend nanofiber scaffold. However, due to the significant difference in solubility parameters between PGA (34.0 J1/2/cm3/2) and chitin (17.8 J 1/2/cm 3/2), the blend showed immiscibility. The degradation study indicated that the entire PGA content degraded within 45 days, and the degradation rate decreased as the chitin content increased (25–75%), with values ranging from 30 to 13 days. Bovine serum albumin-coated PGA/chitin (25:75) proved an effective candidate for cell attachment and the proliferation of normal human fibroblasts [301].
6.1.3. Biological-Molecule-Loaded Uni-Axial Nanofibers
Biological-molecule-embedded nanofibers exhibit a remarkable affinity for the human body, promoting cell adhesion and proliferation. However, the inherent processing constraints of biological molecules are often mitigated by blending them with synthetic polymers. For example, Fan et al. developed the novel L-ascorbic acid 2-phosphate (VC-2-p)-loaded silk fibroin (SF) nanofiber mats. After treatment with ethanol vapor, the unstable silk I became a more stable silk II, enhancing the nanofibers’ properties. These VC-2-p-loaded SF nanofibers significantly improved the adhesion and proliferation of L929 cells, although they also exhibited a burst release of VC-2-p (60–70% within 20 min) [302].
Selvaraj et al. explored the use of fenugreek-loaded silk fibroin nanofibers for accelerated wound healing. Fenugreek, known for its antioxidant properties, drastically increased the nanofibers’ antioxidant activity from 5.6% in pristine silk fibers to 49.3% in fenugreek-loaded silk fibroin nanofibers. The biocompatibility of these fibers was confirmed through the proliferation of fibroblast cells within 72 h of incubation. The release profile of fenugreek varied depending on its concentration; for instance, a silk fibroin–fenugreek blend (1:1) released 73 ± 0.9% of fenugreek within 24 h, while a 1:0.1 blend released only 21.5 ± 0.9% in the same period. The burst release was attributed to fenugreek trapped in surface pores, while the slower release in the second case was due to both the lower concentration of fenugreek and the hydrophobic nature of silk fibroin [303].
Li et al. reported successfully incorporating stable vitamin E (TPGS) and vitamin A palmitate into gelatin nanofibers. Interestingly, as the vitamin content increased, the nanofiber diameter decreased. The release study of vitamin A indicated an initial burst release of 20% within 8 h, followed by sustained release reaching 64% over 60 h. Similarly, vitamin E exhibited a burst release of 30% in 10 h, with sustained release reaching 72% over 60 h. Vitamin E-loaded fibers effectively inhibited the growth of S. aureus and E. coli, and the vitamin-loaded gelatin nanofibers demonstrated superior wound healing capabilities compared to commercially available disinfectant gauze and cast film [304].
Chhabra et al. attempted to enhance the stability of gelatin/poly-methyl vinyl ether-alt-maleic anhydride (PMVE/MA) nanofibers by doping them with zinc oxide and crosslinking them with glutaraldehyde vapor. The antibacterial studies showed that the zinc oxide nanoparticles in the PMVE/MA nanofibers significantly reduced the adherence of E. coli cells compared to raw PMVE/MA fibers [305].
Xi et al. investigated the direction-dependent properties of nanomaterials on wound healing and cell adhesion, finding that polyurethane nanofibers effectively tuned and guided cell growth along the nanofiber direction. The alignment of the nanofibers played a critical role, with anisotropic random nanofiber mats (5236 ± 2313 cells) supporting the highest level of cell proliferation, compared to random nanofiber mats (2252 ± 683 cells) and planar random nanofiber mats (1143 ± 521 cells) [306].
6.1.4. Drug-Loaded Uni-Axial Nanofibers
Drugs with antimicrobial and anti-inflammatory properties are incorporated into nanofibers. Moreover, certain drugs in these nanofibers can stimulate healing events, such as vasodilation, while enhancing resistance against bacterial infections [307]. For instance, Sadri et al. explored using an environmentally friendly green tea extract in chitosan/polyethylene oxide (PEO) nanofiber mats for wound dressing applications. To improve the hydrophilic properties of the nanofiber mats, they were treated with glutaraldehyde vapor. Adding green tea extract (GT) imparted significant antibacterial activity to the chitosan/PEO nanofibers, demonstrating inhibition zones of 6 mm and 4 mm against Gram-positive and Gram-negative bacteria, respectively [307].
Annur et al. investigated the incorporation of silver nanoparticles into chitosan/PEO nanofiber scaffolds, capitalizing on the well-known antibacterial properties of silver. SEM analysis of 1 wt% AgNO3-incorporated chitosan/PEO nanofibers revealed a 30% reduction in fiber diameter following 1.5 min of post-plasma treatment. Antibacterial studies further showed that nanofibers containing 2 wt% AgNO3 exhibited a significantly larger zone of inhibition (0.38 mm) compared to pristine chitosan/PEO nanofibers (0.01 mm), highlighting the enhanced antibacterial efficacy of the silver-loaded nanofibers [308]. Charernsriwilaiwat et al. examined the effects of Garcinia mangostana (GM) extracts, specifically α-mangostin, when loaded into chitosan-ethylenediaminetetraacetic acid/poly(vinyl alcohol) (CS-EDTA/PVA) electrospun nanofibers for wound healing. They found that increasing the α-mangostin content from 1% to 3% reduced the swelling of the nanofibers from 111.96% to 96.67%. This reduction in swelling contributed to a burst release of α-mangostin, with 80% of the drug being released within 60 min. The α-mangostin-loaded CS-EDTA/PVA nanofibers also demonstrated effective bacterial inhibition against E. coli and S. aureus [309]. Chitosan-based nanofibers can exhibit suitable swelling rates and support burst drug release. This can be prevented by grafting and blending chitosan with other polymers [309].
Shoba et al. investigated the potential of papain (P)- and urea (U)-loaded polyvinyl alcohol (PVA) nanofiber scaffolds for wound debridement applications. Their study revealed that pristine PVA nanofibers exhibited a bactericidal activity of 50%, including papain and urea, enhancing the system’s antibacterial efficacy, particularly against Gram-negative E. coli bacteria, ensuring longer-lasting stability. Both the P-U/PVA and P/PVA nanofibers displayed an initial burst release followed by sustained drug release over 24 h. This release behavior was attributed to the hydrophilic matrix’s high surface area and porosity [310].
In another study, Kataria et al. developed ciprofloxacin-loaded PVA/sodium alginate (NaAlg) nanofibers for transdermal patch applications. Their findings showed that the degree of swelling was higher in PVA/NaAlg nanofibers (190 ± 5.3% over 12 h) compared to ciprofloxacin-loaded PVA/NaAlg nanofibers (170 ± 4.3% over 12 h). In vitro drug release studies demonstrated that PVA nanofibers had a faster ciprofloxacin release rate, with 28.4% released in the first 30 min and 98.6% within 5 h. In contrast, the PVA/NaAlg composite nanofibers exhibited a slower release, with 20% in the first 30 min and 80% within 5 h, although both formulations released 99% of the drug within 24 h [311].
Lu et al. explored the incorporation of graphene into PVA/chitosan nanofibers for wound healing applications. Their antibacterial studies revealed that PVA/chitosan nanofibers containing graphene effectively inhibited the growth of E. coli and Agrobacterium, both prokaryotic cells, but not eukaryotic yeast cells. This unique phenomenon was attributed to the interaction between the graphene and the prokaryotic cells, where graphene facilitated electron transfer, ultimately breaking down the cells. However, a nuclear membrane in eukaryotic cells, like yeast, prevented this electron transfer, making it difficult to disrupt these cells. Consequently, graphene’s ability to control microbial proliferation was particularly effective against microbes with prokaryotic cells [312].
Ahmed et al. focused on electrospun zinc oxide (ZnO)-embedded chitosan/PVA nanofibers for diabetic wound healing. Their findings showed that these nanofibers exhibited a higher zone of inhibition against E. coli, P. aeruginosa, B. subtilis, and S. aureus compared to pristine chitosan/PVA nanofibers. Additionally, wound contraction with chitosan/PVA/ZnO nanofibers (90%) was significantly greater than with pristine chitosan/PVA nanofibers (80%) over 12 days [151].
Shalumon et al. explored sodium alginate/polyvinyl alcohol (PVA)/ZnO composite nanofibrous mats as a wound dressing material. These nanofibers were stabilized through crosslinking with 2% glutaraldehyde vapor. The antibacterial studies indicated that increasing the ZnO content (0.5% to 5%) led to enhanced inhibition zone diameters for S. aureus (15–16 mm) and E. coli (14–15 mm). Furthermore, nanofibers containing up to 1% ZnO successfully adhered to and proliferated L929 cells within 96 h, indicating their potential effectiveness in wound healing applications [313].
Pal et al. developed carbon nanodot (CND)-incorporated polycaprolactone (PCL) fluorescent nanofibers for monitoring in vivo wound healing in full-thickness wound dressing applications. The nanofibers were stabilized using an N-hydroxysuccinimide (NHS) and 1-ethyl-3-(3-dimethylaminopropyl) carbodiimide (EDC) solution. Their study showed that CND-incorporated PCL nanofibers significantly enhanced wound recovery (82.75 ± 1.5%) compared to pristine PCL nanofibers (51.75 ± 3.2%) and open wounds (13.8 ± 5.1%). Furthermore, a controlled release of CNDs was observed, making these nanofibers effective for wound healing and real-time monitoring of the healing process [314].
Augustine et al. explored the use of europium hydroxide nanorods (EHNs) in PCL electrospun scaffolds to improve mechanical properties and cell proliferation. They found that the elongation at break for 0.25% EHN-loaded PCL nanofibers (235 ± 16 MPa) was superior to that of pristine PCL nanofibers (316 ± 14 MPa). Additionally, cell culture tests indicated that the proliferation of human umbilical vein endothelial cells (HUVECs) increased significantly when using 0.5 wt% EHN-loaded PCL scaffolds, with cell density rising from 158 ± 16 cells/mm2 at 24 h to 284 ± 17 cells/mm2 at 120 h. This enhanced proliferation demonstrates the potential of EHN-loaded PCL nanofibers for tissue engineering applications [315].
In another study, Augustine et al. reported on developing ZnO nanoparticle-loaded PCL membranes for accelerated fibroblast proliferation and wound healing. Their research showed that cell density in pure PCL membranes increased from 20 ± 6 cells/mm2 after 5 days of implantation to 212 ± 12 cells/mm2 after 20 days. In contrast, cell density with 1% ZnO-loaded PCL membranes increased from 38 ± 8 cells/mm2 after 5 days to 316 ± 6 cells/mm2 after 20 days. Furthermore, the percentage of wound healing with ZnO-loaded PCL membranes (100%) was significantly higher than with pure PCL membranes (85%) after 25 days of implantation, highlighting the effectiveness of ZnO in promoting wound healing [316].
Zhang et al. investigated Captopril (CPL)-impregnated Poly (lactic-co-caprolactone) (PLCL) nanofibers for controlled drug release applications. Their study on swelling behavior revealed that PLCL nanofibers exhibited a lower swelling percentage (165% in 50 min under pH 7.4) compared to poly (L-lactic acid) (PLLA) nanofibers (480% in 50 min under pH 7.4) and poly (lactic-co-glycolic acid) (PLGA) nanofibers (290% in 50 min under pH 7.4). Regarding drug release, PLCL nanofibers demonstrated a more controlled release, with an initial burst release of 66% in 2 h, compared to the higher burst release rates of PLLA and PLGA nanofibers (90% in 2 h). Additionally, PLCL nanofibers showed a higher drug release rate under pH 7.4 (90% in 250 h) than under pH 6.8 (50% in 250 h), indicating the pH-dependent release profile of CPL from PLCL nanofibers [41].
Loiola et al. studied the release of Acetaminophen (AC) and Celecoxib (CL) embedded in PLLA–PEO–PPO block copolymer electrospun nanofibers for wound healing. They observed that nanofibers containing 5 wt% of Celecoxib (CL) exhibited a slower drug release (20% in 12 h) compared to those containing 5 wt% of Acetaminophen (AC), which released 40% of the drug within the same time frame. This difference in release profiles suggests that the type of drug and the composition of the polymer matrix significantly affect the drug release kinetics, making these nanofibers promising candidates for wound healing applications with controlled drug delivery [317].
Wang et al. investigated the wound healing potential of keratin (K) and silver nanoparticles (AgNPs) incorporated into polyurethane (PU) nanofibers. Their study demonstrated that adding keratin and AgNPs significantly improved cell growth, as evidenced by SEM images showing superior NIH 3T3 cell proliferation on PU/K and PU/K/AgNP nanofibers compared to plain PU mats. In bactericidal tests, the nanofibers exhibited enhanced antibacterial activity, with a zone of inhibition diameter of 3.1 mm against E. coli and 1.9 mm against S. aureus. The exudate absorption capability of the nanofibers, crucial for effective wound dressing, was assessed through water absorption in PBS. PU/K nanofibers showed the highest absorption (195.2 ± 7.8%), outperforming both plain PU (44.4 ± 4.2%) and PU/K/AgNPs (101.5 ± 5.1%) [318].
Ahmed et al. explored the drug delivery capabilities of Amphotericin B (AMB) and Itraconazole (ITZ) loaded into polyvinylidene fluoride, poly(methylmethacrylate), poly(N-isopropylacrylamide), and polyvinylpyridine (PVP) nanofibers. These fibers were fabricated using electrospinning and pressure gyration techniques. Morphological studies revealed that electrospun drug-loaded PVP fibers had a finer diameter than those produced by pressure gyration. Additionally, drug dissolution profiles indicated that electrospun PVP fibers significantly enhanced the dissolution of both Amphotericin B and Itraconazole. In terms of drug release, electrospun PVP fibers exhibited a rapid release during the first 15 min, followed by accelerated release from gyrospun fibers after this initial period [319].
Despite the extensive research on drug-loaded uniaxial electrospun nanofibers for wound healing, these materials are often more effective for bactericidal dressings than broader wound healing applications. Researchers have explored various parameters, such as drug concentration, hydrophilic and hydrophobic drug compatibility, and electrospinning conditions like flow rate and tip-to-electrode distance, to optimize these wound-care nanofibers. However, the primary utility of these nanofibers remains focused on antibacterial purposes.
6.1.5. Hybrid Uni-Axial Nanofibers
Various drugs and active biomolecules can be incorporated into hybrid nanofibers to improve antimicrobial and wound healing properties. Mohammadi et al. added curcumin into a PCL/ghm tragacanth (GT) (PCL/GT/Cur) nanofiber mat and evaluated the wound healing applications. Their assessments revealed 99.99% and 85.14% antibacterial activity against methicillin-resistant S. aureus (MRSA) and extended-spectrum β-lactamase (ESBL). Accordingly, PCL/GT/Cur nanofibers showed improvement in the wound healing properties in comparison with control samples [320]. Zhao et al. developed nitrofurazone (NFZ)-loaded poly(L-lactide) (PLLA)/sericin nanofibers for drug delivery applications. According to their study, the hydrophobicity of their composite system was tailored by sericin [274].
Peh et al. investigated a multi-drug-loaded nanofiber scaffold for skin wound healing, combining vitamin C, hydrocortisone, insulin, triiodothyronine (T3), epidermal growth factor (EGF), and 1,25-dihydroxy vitamin D3 (VD3) in a Poly (DL-lactide-co-glycolide) (PLGA)/bovine atelocollagen matrix. The aim was to leverage these bioactive compounds to promote various aspects of wound healing, such as fibroblast proliferation (stimulated by EGF) and collagen production (aided by vitamin C). The drug release profile showed a sustained release of the bioactive molecules: hydrocortisone and EGF were released at 97% in 8 h, T3 and insulin at 80% in 8 h, and vitamin C initially released 55% in 4 h, followed by 30% in the next 4 h, and VD3 at 30% in 12 h. This formulation demonstrated the ability to provide multiple therapeutic benefits simultaneously through controlled release of various agents [321].
Mira et al. focused on the incorporation of 5-aminolevulinic acid (5-ALA) into poly (methyl vinyl ether-alt-maleic acid) (PMVEMA-Ac) and poly (methyl vinyl ether-alt-maleic ethyl monoester) (PMVEMA-Es) nanofibers for healing wounds. High-performance liquid chromatography results revealed 97 ± 1% encapsulation efficiency for 5-ALA. The drug release profile indicated that PMVEMA-Es nanofibers released 55% of 5-ALA in 50 min, showing a rapid release compared to PMVEMA-Ac nanofibers, which released only 15% in the same timeframe. This study highlighted the challenges of managing burst release with traditional uniaxial nanofibers [322].
To address the issue, researchers are exploring coaxial electrospinning. Coaxial electrospinning allows for the creation of core–shell structures where the core can be loaded with high concentrations of drugs while the shell can control the release rate. This method aims to combine the advantages of rapid drug release from the core with a controlled, sustained release from the shell, potentially overcoming the limitations observed with traditional uniaxial nanofibers.
6.2. Coaxial Nanofibers
Coaxial electrospinning produces advanced nanofibers with a core–shell structure, enhancing drug delivery and protecting sensitive substances. The main types are as follows.
6.2.1. Polymer Nanofibers with Distinct Core and Sheath Polymers
Zhao et al. developed gelatin-coated poly(ε-caprolactone) (PCL) nanofibers, leveraging gelatin for cell adhesion and proliferation while PCL provides mechanical stability. The gelatin layer stabilized with glutaraldehyde, resulting in nanofibers with reduced porosity compared to the uncoated version [323]. Ojha et al. explored chitosan/polyethylene oxide (PEO) nanofibers for wound healing and dressing. Pristine PEO nanofibers exhibited higher tensile strength (10.0 ± 0.2 MPa) than chitosan-PEO nanofibers (4.0 ± 0.3 MPa). The core diameter of the nanofibers was 100 nm, with a shell diameter of 250 nm and a porosity of 84%, facilitating exudate absorption [324]. Nguyen et al. investigated poly (lactic acid) (PLA)-chitosan (CS) nanofibers for wound dressing. Increasing the core feed rate from 1.0 to 4.0 μL/min increased the water contact angle (24.1–52.9°) but decreased bacterial inhibition (52–22%). PLA nanofibers had a higher tensile strength (3.3 MPa) compared to CS nanofibers (0.5 MPa) [325]. Pakravan et al. studied PEO-chitosan nanofibers for wound dressing, noting that the theoretical specific surface area (16.7 m2/g) was comparable to the experimental value (15 ± 1.5 m2/g) [326]. Zhang et al. also examined PEO/chitosan scaffolds for wound care. Transmission electron microscopy (TEM) images showed distinct interfaces between core and shell layers, with higher chitosan content expanding the shell layer. These nanofibers maintained stability only up to 70 °C [327].
6.2.2. Biological-Molecule-Loaded Coaxial Nanofibers
Rubert et al. developed PEO/PCL core/shell electrospun nanofibers embedded with FGF2 and bovine serum albumin (BSA)-Evans blue. The contact angle of pristine PEO was 20°, while pristine PCL had a contact angle of 118°. Their drug release study showed an initial burst release of FGF2 (10.6% in 1 h), followed by a sustained release (52.9% from day 1 to day 9) [328]. Zhang et al. fabricated fluorescein isothiocyanate-conjugated bovine serum albumin (FITC-BSA)-loaded PEG/PCL core/shell nanofibers for sustained drug release. Increasing the inner flow rate from 0.2 to 0.6 mL/h resulted in larger fiber diameters (270–380 nm). In vitro release studies indicated that PCL/fitcBSA/PEG nanofibers had a burst release of 35.7% in 3 h, compared to 31.2% in 4 h for PCL-r-fitcBSA/PEG core/shell nanofibers [329]. Jiang et al. prepared PEG/PCL core/shell nanofibers incorporating lysozyme and BSA to achieve controlled release. Nanofibers with 1.96% BSA and an inner feed rate of 0.6 mL/h exhibited a sustained release of 50% within 24 days, whereas those with 5.56% BSA and an inner feed rate of 2 mL/h released 95% within 24 days [330]. Gao et al. addressed delayed wound healing in hyperglycemic conditions by incorporating Dimethyloxalylglycine (DMOG) and Collagen I (Col I) into PCL core/shell nanofibers. Their study showed that DMOG/Col I blend nanofibers had a rapid drug release (53.3 ± 2.7% in 12 h) compared to DMOG/Col I core/shell nanofibers (17 ± 2.1% in 12 h) [331].
6.2.3. Drug-Loaded Coaxial Polymer Nanofibers
He et al. developed PCL-based core/shell nanofibers incorporating metronidazole drug and zein for tissue regeneration. Pristine zein nanofibers exhibited a higher water contact angle (146° ± 0.8°) compared to metronidazole-loaded PCL/zein nanofibers (139° ± 1.4°) and pristine PCL nanofibers (126° ± 1.2°). Variations in the core-to-shell flow rate ratio impacted drug release rates: MND-PCL/zein nanofibers with a 1.4:3 ratio released 22.3% of the drug in 2 h, while PCL/zein nanofibers with ratios of 0.7:3 and 1:3 released 16.5% and 12.2%, respectively [332]. Najafi-Taher et al. incorporated ascorbic acid (ACA) into PVA-chitosan (CS) core/shell nanofibers for transdermal delivery. Alternately, they added ACA into PVA/CS blend to prepare composite nanofibers. The nanofibers were crosslinked with glutaraldehyde vapors, resulting in a higher burst release (33% in 4 h) compared to coaxial nanofibers (27% in 4 h), and the cumulative release of crosslinked coaxial nanofibers (74% in 30 h) was greater than that of blend nanofibers (63% in 30 h) [333]. Zupančič et al. developed monolithic PVA/poly (methyl methacrylate) (PMMA) and PVA/PMMA blend core/shell nanofibers loaded with ciprofloxacin hydrochloride (CIP) for skin wound dressing. The study revealed that drug release could be controlled by changing the rate of core flow for PVA in PVA/PMMA nanofibers and the amount of PMMA in PVA-PMMA blend/CIP nanofibers [334]. Zhu et al. fabricated core/shell nanofibers containing PVA, asiaticoside, alginate and chitosan for burn wound dressing. These nanofibers achieved a wound healing ratio above 99%, compared to 99.2% for Centella triterpenes cream. The cumulative drug release for the cream and coaxial nanofibers was 82% within 24 h [335].
6.2.4. Hybrid Coaxial Nanofibers
Li et al. reported on regenerated silk fibroin (RSF) nanosphere-based core/shell nanofibers for wound healing, where curcumin (CUR) was used in the core and RSF-doxorubicin hydrochloride (DOX) in the shell. Water annealing at 60 °C resulted in higher water contact angles for the dual-drug-loaded RSF nanofibers than those treated at 45 °C or untreated. Accordingly, the drug release rate was related to the nano-sphere ratio [336]. Ranjbar-Mohammadi et al. investigated gum tragacanth (GT) and tetracycline hydrochloride (TCH) loaded into PLGA core/shell nanofibers for wound dressing. The wettability study revealed that GT-TCH/PLGA nanofibers had a lower water contact angle (92°) compared to PLGA 50:50 nanofibers (42°) and pristine PLGA nanofibers (135°). The drug release study showed that PLGA/GT core/shell nanofibers (20% in 2 h) and PLGA nanofibers (25% in 2 h) provided sustained drug release compared to PLGA/GT (50:50) blend nanofibers (48% in 2 h) [337].
Coaxial electrospun fibers minimize burst release, as the polymer sheath degrades the release rate at a chosen rate. To further avoid burst drug release, tri-axial nanofibers can be used. The incorporation of the additional layer fine-tunes the drug release profile.
6.3. Tri-Axial Nanofibers
Tri-axial nanofibers, developed via the tri-axial electrospinning method, consist of a core, a middle layer, and an outer sheath. Despite their limited exploration compared to other electrospun nanofibers, their unique properties make them promising for drug delivery applications.
Yang et al. fabricated hollow nanofibers with Lecithin-diclofenac sodium (PL-DS) as the core, Methacrylic acid-Methylmethacrylate (MAA-MMA) blend as the middle layer, and ethanol as the sheath. The ethanol sheath protects the middle layer from environmental fluctuations. Drug release studies showed a sustained release of 15% in 3 h for the nanofibers, whereas the DS particles exhibited a burst release of 75% in 3 h. This difference is due to the shell dissolving at pH 1 and the PL-DS dissolving at pH 7 [338].
Khalf et al. investigated tri-axial nanofibers with mineral oil, cellulose acetate (CA), and polycarbonate (PC). These nanofibers demonstrated a break strength of 5 N and successfully supported the proliferation of human umbilical vein endothelial cells (HUVECs-2), indicating their potential for tissue regeneration [106].
Liu et al. prepared tri-axial nanofibers with a gelatin core, a PCL middle layer, and a gelatin sheath. Each layer played a specific role: the sheath facilitated cell adhesion and proliferation, the middle layer provided mechanical strength, and the core contained drugs or growth factors for sustained release [339].
Han et al. developed tri-axial nanofibers loaded with nisin using polyvinylpyrrolidone (PVP) as the core, PCL as the middle layer, and Nylon 6 as the sheath. The tri-axial nanofibers exhibited extended antimicrobial activity, with bacterial resistance lasting up to 6 days compared to 1 day for the nisin-loaded PCL and 2 days for PVP/PCL coaxial nanofibers. This extended resistance is attributed to the slower drug release from the sheath and middle layers [340].
Khalf et al. also explored doxycycline-loaded PCL-Gelatin (GT)/Hydrophilic Gelatin (GT)/PCL-Hydrophilic Gelatin (GT) ternary scaffolds for drug release purposes. The release profile indicated that PCL/GT blend nanofibers released 95% of the drug in 24 h, while GT/PCL core/shell nanofibers released 50% in the same period. Tri-axial nanofibers released 85% of the drug in 24 h. The slower permeability of tri-axial fibers (3.5 µm/h) compared to coaxial (6 µm/h) and blend fibers (12 µm/h) affected drug release [341].
While tri-axial nanofibers offer improved drug release control over uni-axial and coaxial nanofibers, challenges such as solvent evaporation post-spinning and polymer selection remain critical in their fabrication.
7. Application of Nanofiber Dressings for Various Wounds
Studies have demonstrated that nanofiber dressings are suitable for burns, diabetic ulcers, and surgical wounds. Burn wounds are often complex and prone to infections due to the loss of the skin’s protective barrier. Nanofiber layers can support a semi-permeable barrier that maintains moisture in the wound, which is essential for healing. Additionally, antimicrobial and anti-inflammatory agents are easily incorporated into the nanofiber matrices, reducing the risk of infections. By mimicking the structure and composition of skin tissues, nanofibers support and enhance cell adhesion, proliferation, migration, and spreading, leading to tissue formation and healing [337,338,339,340,341].
Another example of the application of nanofiber dressings is the treatment of diabetic ulcers. These chronic wounds are characterized by slow healing and a high susceptibility to infection. To address these challenges, nanofiber dressings can be utilized, which support oxygen exchange, drug release, and antimicrobial activity, favoring the healing process [342]. Electrospun fiber enhances hemostasis, reducing scarring, and supporting anti-inflammatory properties at surgical sites [343].
8. Clinical Trials
The clinical translation of nanofibers (NFs), especially in tissue engineering, represents one of the most pressing therapeutic needs today. In vivo testing of tissue-engineered scaffolds is considered the gold standard in preclinical studies before advancing to human clinical trials. These in vivo assessments are crucial for evaluating cellular responses, potential cellular rejection, and the formation of new tissue within a living organism [342]. Ultimately, the design and adaptation of these matrices must align with specific therapeutic goals—whether that involves modulating the wound microenvironment, providing an optimal cellular scaffold, minimizing scarring, or serving as a delivery system for cells or biologically active substances [343].
Polymer carbohydrates have gained importance in clinical wound dressing applications. Among these, chitosan (CS), recognized for its potent antibacterial properties, has been highlighted in clinical trials for treating chronic periodontitis and promoting wound healing, with or without the inclusion of silver nanoparticles (AgNPs). Another system is the alginate-carboxymethyl cellulose–ionic-silver dressing, which was applied in 36 patients with ulcers. This dressing supported enhanced wound healing in clinical settings [344,345].
Hyaluronic acid, known for its beneficial biological properties, is another commercially successful polymer-based material. Products like Hyalofill-R and Hyalofill-F cater to different wound healing needs—deep exuding wounds and acute or chronic exuding wounds, respectively. Incorporating AgNPs into these dressings enhanced the antimicrobial properties and reduced inflammatory responses [346].
Several carbohydrate polymer-based wound dressings incorporating AgNPs have been successfully marketed, offering a range of solutions for wound management. Notable examples include Aquacel Ag, which contains carboxymethylcellulose combined with silver ions (Ag+); ALGICELL Ag, an alginate wound dressing with Ag+; and DynaGinate, composed of calcium alginate. Other products, such as Biatain Alginate Ag, ACTICOAT, and ALGISITE, all of which contain alginate or calcium-alginate, are further testament to the growing importance and efficacy of polymer-based carbohydrate wound dressings in clinical practice [346].
Alginate wound dressings have demonstrated significant advantages in clinical trials compared to traditional materials such as cotton and viscose fibers [347,348,349,350,351,352]. These dressings resulted in fewer fibrotic lesions and improved aesthetic outcomes. The inherent properties of alginate, such as its ability to maintain a moist wound environment and its biocompatibility, may also make it an ideal candidate for surgical sutures. In such applications, quick wound closure, effective healing, and minimal scar formation are crucial therapeutic objectives [353].
Chaturvedi et al. explored the use of doxycycline-loaded polycaprolactone (PCL) NFs for treating chronic periodontitis [354]. The study revealed that these drug-coated NFs followed first-order release kinetics over 11 days, leading to significant improvements in clinical parameters such as probing depth, plaque index, and gingival index compared to the control group [355,356]. This approach was further validated in a similar study using metronidazole-loaded PCL fibers, resulting in better clinical outcomes than standard treatments [356].
Moreover, the development of a 3D electrospun NF scaffold for tissue restoration has been successfully patented, underscoring the potential of electrospinning technology in biomedical applications [357]. This process is reliable, consistent, scalable, and cost-effective, making it an attractive option for the mass production of advanced medical devices and materials [358].
Poly(diallyldimethylammonium chloride) (PDDA) is a linear cationic polyelectrolyte distinguished by its biocompatibility, biodegradability, and nontoxic nature. Its permanent quaternary ammonium groups confer intrinsic antimicrobial properties, making PDDA valuable for diverse biomedical applications [26].
In groundbreaking research conducted by Chizari et al., the wound healing capabilities of PDDA and PDDA/honey nanofibers were thoroughly investigated [26]. The study incorporated glutaraldehyde (GA) as a crosslinking agent to refine the release behavior of active compounds and reduce the nanofibers’ solubility. The findings revealed that nanofibers containing honey exhibited outstanding antibacterial efficacy, achieving a 99.9% reduction in bacterial colonies of both S. aureus and E. coli. Additionally, the release of therapeutic compounds from these nanofibers was sustained for up to 125 h, indicating a well-controlled release profile [26].
The study further assessed the potential of these nanofibers as wound dressings for diabetic wound healing. Results demonstrated that honey-containing nanofiber dressings significantly enhanced wound healing. This efficacy is attributed to the nanofibers’ synergistic anti-inflammatory, antioxidant, and antibacterial properties. Notably, applying these dressings promoted the proliferation of fibroblast cells, the synthesis of collagen fibers, and the formation of connective fibrils within the wounds, thereby substantially improving the overall healing process [26].
9. Drawbacks, Limitations, and Critical Properties
The distinction between scaffold and wound dressing is often overlooked in the literature. Scaffolds are engineered structures that integrate directly with specific tissues, such as skin, to participate in active healing. These materials provide structural support, are typically biodegradable, and can deliver bioactive molecules, such as growth factors or antimicrobial agents, directly to the wound site, promoting tissue regeneration and remodeling [359,360,361,362,363].
In contrast, wound dressings serve primarily as non-integrative, removable barriers that maintain homeostasis, protect the wound from external contaminants, and create an environment conducive to healing [364,365]. Another frequently misunderstood distinction concerns biocompatibility and cytocompatibility. While cytocompatibility refers specifically to a material’s compatibility with cultured cells—typically assessed using assays like MTT, XTT, LDH, AlamarBlue, or sulforhodamine B on fibroblast or keratinocyte lines—biocompatibility is a broader concept encompassing hemocompatibility, inflammatory response, and long-term in vivo performance [366]. Labeling a material as “biocompatible” without comprehensive cytocompatibility and in vivo validation can lead to premature conclusions about its safety.
Biodegradability is another critical differentiator. Scaffolds are generally designed to degrade in situ over time, synchronizing with tissue healing, while wound dressings may or may not be degradable depending on the intended application [367]. Misinterpretation of the porosity in electrospun nanofibers is also common. Although individual nanofibers may be nonporous, the collective mat exhibits inter-fiber porosity, forming a 3D network that allows gas exchange, fluid drainage, nutrient transport, and cell migration—factors critical for effective wound repair [367,368,369]. Furthermore, the high surface-area-to-volume ratio of electrospun mats enables therapeutic agents’ incorporation and sustained release, including antimicrobials, anti-inflammatory compounds, and growth factors [369].
Despite these advantages, several critical limitations hinder clinical and industrial translation. From a surface-engineering perspective, a lack of characterization poses a significant challenge, especially regarding wettability and topographical roughness. These properties influence cell adhesion, proliferation, and differentiation, and optimal biomimetic surfaces require a delicate balance between hydrophilicity and hydrophobicity to replicate ECM features [369,370,371,372,373]. From an industrial standpoint, electrospinning is inherently low-throughput and faces significant scale-up challenges. Maintaining uniform fiber morphology, mechanical strength, and drug distribution during mass production is difficult.
Additionally, using polymers with high purity, flammable and toxic solvents, and the need for sterile environments raise production costs, especially in healthcare systems. These issues limit the feasibility and cost-effectiveness of commercial-scale production. Biosafety is another key concern. While many in vitro and short-term in vivo studies suggest good compatibility, long-term biocompatibility and biodegradability remain insufficiently studied. Potential risks include chronic immune reactions, fibrosis, foreign body responses, or accumulation of undegradable residues like metal nanoparticles and toxic crosslinkers (e.g., glutaraldehyde). Degradation products of synthetic polymers may also impart toxicity, necessitating extended preclinical trials, long-term animal studies, and post-market surveillance for clinical assurance.
Additionally, multifunctional dressings containing drugs, nanoparticles, or growth factors must encompass complex regulatory pathways. These require extensive documentation of batch reproducibility, risk–benefit profiles, and safety evaluations, which can delay clinical translation and increase development costs.
10. Conclusions
This review analyzes recent advancements in wound dressing materials, focusing on nanofiber-based dressings. Nanofiber dressings fabricated through electrospinning exhibit properties that enhance wound healing compared to traditional materials. Electrospinning has emerged as a potential method for nanofiber production due to its simplicity, cost-effectiveness, and versatility.
These electrospun nanofiber mats are characterized by their exceptional attributes, including enhanced hemostasis, superior exudate absorption, and optimal gas permeability, all of which contribute to more effective wound management. The high surface area of nanofibers facilitates better interaction with the wound environment, promoting efficient cell migration and proliferation. Additionally, the porous nature of these mats supports cellular respiration and nutrient exchange, further accelerating the healing process.
The ability of nanofiber dressings to address the specific needs of different types of wounds, from acute to chronic, demonstrates their potential for personalized wound care. By tailoring the properties of these nanofibers, such as incorporating antimicrobial agents or growth factors, it is possible to develop dressings that protect the wound and actively contribute to tissue regeneration and repair.
Overall, utilizing electrospinning to fabricate advanced nanofiber dressings represents a significant leap forward in wound care technology. The continued innovation in this field promises to enhance the efficacy of wound dressings, offering new solutions that are precisely engineered to meet patients’ diverse and evolving needs.
11. Future Perspective
This review highlights the research carried out on wound dressing. The development from primary wound care to sophisticated, multifunctional dressings represents a significant achievement. Outstanding results are linked to the integration of nanofiber technology and electrospinning methods. While substantial progress has been made, the urgent need for wound dressings that can significantly enhance healing outcomes while addressing complications remains necessary.
Current wound care challenges include the need for materials that provide protection against infections and promote rapid tissue regeneration without the need for antibiotics, which increase bacterial resistance. The future of wound care lies in developing advanced materials that address these needs.
Electrospinning has emerged as an outstanding method to develop advanced wound dressings, enabling nanofibrous materials with high surface area, porosity, and functional versatility. These nanofiber mats exhibit exceptional capabilities, including improved hemostasis, exudate absorption, gas permeability, and cellular respiration. These characteristics enhance cell migration and proliferation for effective wound healing.
To address wound management needs, researchers are exploring advanced electrospinning techniques to develop complex, multi-layered dressings. For example, dual-functional mats have an outer layer embedded with antibacterial nanoparticles to prevent infections. In contrast, an inner layer delivers growth factors to guide cell response and tissue regeneration. Integrating a middle layer can mitigate chronic inflammation, enhancing the effectiveness of the dressings.
Cutting-edge electrospinning techniques, such as coaxial and tri-axial electrospinning, are at the forefront of this innovation. Coaxial electrospinning allows for the production of core–shell nanofibers with distinct functional layers. In contrast, tri-axial electrospinning facilitates the creation of trilayered structures, each layer tailored for specific therapeutic roles. These advancements in nanofiber technology pave the way for the development of wound dressings with unprecedented functionality and efficacy.
Future efforts should focus on optimizing these technologies and materials to meet the evolving demands of wound care. Researchers can create next-generation wound care solutions that significantly improve patient outcomes by developing advanced, biologically inspired dressings that address infection control, tissue regeneration, and inflammation. The continued research on these materials will advance wound healing practices, enhancing the quality of patient care.
It is a challenge to obtain wound dressings similar to scaffolds’ properties. Scaffolds intended for wound dressings must be designed with mechanical properties that support and promote the transport of biomolecules and cells for regenerative medicine. They must also be wettable and hydrophilic to support the adhesion and proliferation of mammalian cells, possess antimicrobial properties, be porous to facilitate the removal of exudates and gas exchange, and exhibit biocompatibility, among other requirements.
Desired mechanical properties in electrospun fibers are typically achieved using synthetic and semisynthetic polymers. In contrast, scaffold properties and biocompatibility are achieved by incorporating polysaccharides (such as glycosaminoglycans) and proteins into the electrospun fibers. Then, the main challenge lies in controlling the surface properties of the fibers, such as wettability, roughness, free space between the fibers, and chemical composition, in addition to the electrospinning parameters.
Author Contributions
Conceptualization, G.C.F. and M.P.G.; methodology, G.C.F. and M.P.G.; software, G.C.F. and M.P.G.; validation, G.C.F. and M.P.G. and A.F.M.; formal analysis, G.C.F., M.P.G. and A.F.M.; investigation, G.C.F., M.P.G. and A.F.M.; resources, G.C.F., M.P.G. and A.F.M.; data curation, G.C.F., M.P.G. and A.F.M.; writing—original draft preparation, G.C.F., S.A.D. and M.S.; writing—review and editing, G.C.F., M.P.G., A.F.M. and R.K.G.; visualization, G.C.F., M.P.G. and A.F.M.; supervision, G.C.F., M.P.G. and A.F.M.; project administration, G.C.F., M.P.G. and A.F.M. All authors have read and agreed to the published version of the manuscript.
Funding
This research received no external funding.
Data Availability Statement
All data generated or analyzed during this study are included in this published article.
Conflicts of Interest
Authors Ghazaleh Chizari Fard, Seyed Ahmad Dehdast, Mohammad Shabani were employed by the company “Pajoohesh BAMA” Knowledge Enterprise Co. The remaining authors declare that the research was conducted in the absence of any commercial or financial relationships that could be construed as a potential conflict of interest.
References
- Azimi, B.; Maleki, H.; Zavagna, L.; De la Ossa, J.G.; Linari, S.; Lazzeri, A.; Danti, S. Bio-Based Electrospun Fibers for Wound Healing. J. Funct. Biomater. 2020, 11, 67. [Google Scholar] [CrossRef]
- Syed, S.A.; Mahmood, A.; Shah, M.R.; Yasinzai, M.; Noreen, S.; Khan, S.; Rauf, A. Synthesis of orotic acid derivatives and their effects on stem cell proliferation. Open Chem. 2020, 18, 620–627. [Google Scholar] [CrossRef]
- Wei, M.; Wan, Y.; Zhang, X.; Li, Y.; Wang, Y.; Xu, H. Stimulus-Responsive MOF–Hydrogel Composites for Tissue Engineering, Drug Delivery, and Gene Delivery Applications. Open Chem. 2021, 19, 953–960. [Google Scholar] [CrossRef]
- Ng, K.W.; Lau, W.M. Skin Deep: The Basics of Human Skin Structure and Drug Penetration. In Percutaneous Penetration Enhancers Chemical Methods in Penetration Enhancement; Dragicevic, N., Maibach, H.I., Eds.; Springer: Berlin/Heidelberg, Germany, 2015; pp. 3–11. [Google Scholar]
- Veregue, F.R.; Plath, A.M.S.; Oliveira, D.M.; Pereira, A.G.B.; Muniz, E.C.; Fajardo, A.R. Enhancing Biological Properties with Straightforward Deposition of Durable Heparin/Chitosan Surface Coatings on Wettable Poly(ε-Caprolactone)/Tween-20 Electrospun Fibers. Surf. Interfaces 2024, 46, 104149. [Google Scholar] [CrossRef]
- Facchi, D.P.; Fajardo, A.R.; Pereira, A.G.B.; Ramos, A.P.; Muniz, E.C.; Rubira, A.F. Composite Filter with Antimicrobial and Anti-Adhesive Properties Based on Electrospun Poly(butylene adipate-co-terephthalate)/Poly(lactic acid)/Tween 20 Fibers Associated with Silver Nanoparticles. J. Membr. Sci. 2022, 650, 120426. [Google Scholar] [CrossRef]
- Rufato, K.B.; Nunes, F.R.; Silva, J.C.; Ribeiro, S.J.L.; Martins, V.C.A.; Facchi, D.P. Electrospinning of Poly(vinyl alcohol) and Poly(vinyl alcohol)/Tannin Solutions: A Critical Viewpoint about Crosslinking. Mater. Today Commun. 2023, 35, 106271. [Google Scholar] [CrossRef]
- Souza, P.R.; Fajardo, A.R.; Pereira, A.G.B.; Muniz, E.C.; Rubira, A.F. Polysaccharide-Based Materials Created by Physical Processes: From Preparation to Biomedical Applications. Pharmaceutics 2021, 13, 621. [Google Scholar] [CrossRef]
- Boulton, A.J.; Vileikyte, L.; Ragnarson-Tennvall, G.; Apelqvist, J. The Global Burden of Diabetic Foot Disease. Lancet 2005, 366, 1719–1724. [Google Scholar] [CrossRef]
- Pazyar, N.; Yaghoobi, R.; Bagherani, N.; Kazerouni, A. Skin Wound Healing and Phytomedicine: A Review. Skin Pharmacol. Physiol. 2014, 27, 303–310. [Google Scholar] [CrossRef]
- Krishnan, R.; Kretlow, J.D.; Kikani, B.; Nair, L.S.; Laurencin, C.T. Polysaccharide Nanofibrous Scaffolds as a Model for In Vitro Skin Tissue Regeneration. J. Mater. Sci. Mater. Med. 2012, 23, 1511–1519. [Google Scholar] [CrossRef]
- Queen, D.; Harding, K. A Dressing History. Int. Wound J. 2004, 1, 59–62. [Google Scholar] [CrossRef]
- Sibbald, R.G.; Williamson, D.; Orsted, H.L.; Keast, D. Cost-Effectiveness of Becaplermin for Nonhealing Neuropathic Diabetic Foot Ulcers. Ostomy Wound Manag. 2003, 49, 76–81. [Google Scholar]
- Game, F.L.; Hinchliffe, R.J.; Apelqvist, J.; Armstrong, D.G.; Bakker, K.; Hartemann, A.; Löndahl, M.; Price, P.E.; Jeffcoate, W.J. A Systematic Review of Interventions to Enhance the Healing of Chronic Ulcers of the Foot in Diabetes. Diabetes Metab. Res. Rev. 2012, 28, 119–141. [Google Scholar] [CrossRef] [PubMed]
- Stanley, B.J. Negative Pressure Wound Therapy. Vet. Clin. N. Am. Large Anim. Pract. 2017, 47, 1203–1215. [Google Scholar] [CrossRef] [PubMed]
- Carruthers, K.H.; Schwindt, C.A. Casting and Splinting Management for Hand Injuries in the In-Season Contact Sport Athlete. Sports Health 2017, 9, 364–370. [Google Scholar] [CrossRef] [PubMed]
- MacNeil, S. Progress and opportunities for tissue-engineered skin. Nature 2007, 445, 874. [Google Scholar] [CrossRef]
- Monavarian, M.; Sharifi, M.; Fatahi, Y.; Shokrgozar, M.A. Regenerative Scar-Free Skin Wound Healing. Tissue Eng. Part B Rev. 2019, 25, 294–311. [Google Scholar] [CrossRef]
- Liu, M.; Zeng, X.; Ma, C.; Yi, H.; Ali, Z.; Mou, X.; Li, S.; Deng, Y. Electrospun Nanofibers for Wound Healing. Mater. Sci. Eng. C 2017, 76, 1413–1423. [Google Scholar] [CrossRef]
- Su, Y.; Chen, Q.; Liu, X.; Xiong, X.; Ren, J.; Xu, X.; Wu, Q.; He, C. Nanofiber Dressings Topically Delivering Molecularly Engineered Human Cathelicidin Peptides for the Treatment of Biofilms in Chronic Wounds. Mol. Pharm. 2019, 16, 2011–2022. [Google Scholar] [CrossRef]
- Kai, D.; Liow, S.S.; Loh, X.J. Biodegradable polymers for electrospinning: Towards biomedical applications. Mater. Sci. Eng. C 2014, 45, 659. [Google Scholar] [CrossRef]
- Meng, Z.X.; Li, Y.; Shi, J.; Liu, L.; Li, L. Fabrication and Characterization of Three-Dimensional Nanofiber Membrane of PCL–MWCNTs by Electrospinning. Mater. Sci. Eng. C 2010, 30, 1014–1018. [Google Scholar] [CrossRef]
- Flores-Rojas, G.G.; Gómez-Lazaro, B.; López-Saucedo, F.; Vera-Graziano, R.; Bucio, E.; Mendizábal, E. Electrospun Scaffolds for Tissue Engineering: A Review. Macromol 2023, 3, 524–553. [Google Scholar]
- Vilchez, A.; Garcia-Perez, P.; Villaverde, G.; Simal-Gandara, J.; Eugenio, A.; Prieto, M.A. Applications of Electrospun Nanofibers with Antioxidant Properties: A Review. Nanomaterials 2020, 10, 175. [Google Scholar] [CrossRef] [PubMed]
- Teo, W.E.; Ramakrishna, S. A review on electrospinning design and nanofibre assemblies. Nanotechnology 2006, 17, 89. [Google Scholar] [CrossRef] [PubMed]
- Gashti, M.P.; Dehdast, S.A.; Berenjian, A.; Shabani, M.; Zarinabadi, E.; Fard, G.C. PDDA/Honey Antibacterial Nanofiber Composites for Diabetic Wound-Healing: Preparation, Characterization, and In Vivo Studies. Gels 2023, 9, 173. [Google Scholar] [CrossRef] [PubMed]
- Avishai, E.; Yeghiazaryan, K.; Golubnitschaja, O. Impaired wound healing: Facts and hypotheses for multi-professional considerations. in predictive, preventive and personalised medicine. EPMA J. 2017, 8, 23. [Google Scholar] [CrossRef]
- Boateng, J.; Catanzano, O. Advanced therapeutic dressings for effective wound healing—A review. J. Pharm. Sci. 2015, 104, 3653. [Google Scholar] [CrossRef]
- Ladhani, H.A.; Yowler, C.J.; Claridge, J.A. Burn wound colonization, infection, and sepsis. Surg. Infect. 2021, 22, 44. [Google Scholar] [CrossRef]
- Scalise, A.; Bianchi, A.; Tartaglione, C.; Bolletta, A.; Pierangeli, M.; Di Benedetto, G. Microenvironment and Microbiology of Skin Wounds: The Role of Bacterial Biofilms and Related Factors. Semin. Vasc. Surg. 2015, 28, 151–159. [Google Scholar] [CrossRef]
- Rowan, M.P.; Cancio, L.C.; Elster, E.A.; Burmeister, D.M.; Rose, L.F.; Natesan, S.; Chan, R.K.; Christy, R.J.; Chung, K.K. Burn Wound Healing and Treatment: Review and Advancements. Crit. Care 2015, 19, 243. [Google Scholar] [CrossRef]
- Holl, J.; Kowalewski, C.; Zimek, Z.; Al-Ahmad, A.; Binger, T.; Rennert, R.; Kalbitz, M.; Slotta-Huspenina, J.; Erber, M.; Schreml, S.; et al. Chronic Diabetic Wounds and Their Treatment with Skin Substitutes. Cells 2021, 10, 655. [Google Scholar] [CrossRef]
- Wang, Y.; Beekman, J.; Hew, J.; Jackson, S.; Moradi, R.; Shi, H.; Khoo, A.; Mackay, M.; Nikkhah, M. Burn Injury: Challenges and Advances in Burn Wound Healing, Infection, Pain and Scarring. Adv. Drug Deliv. Rev. 2018, 123, 3–17. [Google Scholar] [CrossRef] [PubMed]
- Gardner, S.E.; Abbott, L.I.; Fiala, C.A.; Rakel, B.A. Factors associated with high pain intensity during wound care procedures: A model. Wound Repair. Regen. 2017, 25, 558. [Google Scholar] [CrossRef]
- Pham, T.L.; Bazan, H.E.P. Docosanoid signaling modulates corneal nerve regeneration: Effect on tear secretion, wound healing, and neuropathic pain. J. Lipid Res. 2021, 62, 100033. [Google Scholar] [CrossRef]
- Lindholm, C.; Searle, R. Wound management for the 21st century: Combining effectiveness and efficiency. Int. Wound J. 2016, 13, 5. [Google Scholar] [CrossRef]
- Fogh, K.; Andersen, M.B.; Bischoff-Mikkelsen, M.; Hoffmann, J.H.; Karlsmark, T.; Jemec, G.B.E. Clinically Relevant Pain Relief with an Ibuprofen-Releasing Foam Dressing: Results from a Randomized, Controlled, Double-Blind Clinical Trial in Exuding, Painful Venous Leg Ulcers. Wound Repair Regen. 2012, 20, 815–821. [Google Scholar] [CrossRef] [PubMed]
- Arapoglou, V.; Katsenis, K.; Syrigos, K.; Goutos, I.; Athanasiou, V.; Maltezos, E.; Papadopoulos, O. Analgesic Efficacy of an Ibuprofen-Releasing Foam Dressing Compared with Local Best Practice for Painful Exuding Wounds. J. Wound Care 2011, 20, 319–324. [Google Scholar] [CrossRef] [PubMed]
- Fang, H.; Xu, J.; Ma, H.; Liu, J.; Xing, E.; Cheng, Y.Y.; Wang, H.; Nie, Y.; Pan, B.; Song, K. Functional materials of 3D bioprinting for wound dressings and skin tissue engineering applications: A review. Int. J. Bioprint 2023, 9, 757. [Google Scholar] [CrossRef]
- Bielefeld, K.A.; Amini-Nik, S.; Alman, B.A. Cutaneous wound healing: Recruiting developmental pathways for regeneration. Cell. Mol. Life Sci. 2013, 70, 2059. [Google Scholar] [CrossRef]
- Zhang, H.; Lou, S.; Williams, G.R.; Branford-White, C.; Nie, H.; Quan, J.; Zhu, L.M. A systematic study of captopril-loaded polyester fiber mats prepared by electrospinning. Int. J. Pharm. 2012, 439, 100. [Google Scholar] [CrossRef]
- Eming, S.A.; Krieg, T.; Davidson, J.M. Inflammation in wound repair: Molecular and cellular mechanisms. J. Investig. Dermatol. 2007, 127, 514. [Google Scholar] [CrossRef]
- Merrell, J.G.; McLaughlin, S.W.; Tie, L.; Laurencin, C.T.; Chen, A.F.; Nair, L.S. Curcumin-loaded poly(ε-caprolactone) nanofibres: Diabetic wound dressing with anti-oxidant and anti-inflammatory properties. Clin. Exp. Pharmacol. Physiol. 2009, 36, 1149. [Google Scholar] [CrossRef] [PubMed]
- Ramasastry, S.S. Acute wounds. Clin. Plast. Surg. 2005, 35, 195. [Google Scholar] [CrossRef] [PubMed]
- Kiwanuka, E.; Junker, J.; Eriksson, E. Harnessing growth factors to influence wound healing. Clin. Plast. Surg. 2012, 39, 239. [Google Scholar] [CrossRef] [PubMed]
- Sorg, H.; Krueger, C.; Vollmar, B. Intravital insights in skin wound healing using the mouse dorsal skin fold chamber. J. Anat. 2007, 211, 810. [Google Scholar] [CrossRef]
- Pierce, G.F.; Mustoe, T.A.; Altrock, B.W.; Deuel, T.F.; Thomason, A. Role of plateletderived growth factor in wound healing. J. Cell. Biochem. 1991, 45, 319. [Google Scholar] [CrossRef] [PubMed]
- Gibran, N.S.; Boyce, S.; Greenhalgh, D.G. Cutaneous wound healing. J. Burn. Care Res. 2007, 28, 577. [Google Scholar] [CrossRef]
- Xie, Z.; Paras, C.B.; Weng, H.; Punnakitikashem, P.; Su, L.C.; Vu, K.; Tang, L.; Yang, J.; Nguyen, K.T. Dual growth factor releasing multi-functional nanofibers for wound healing. Acta Biomater. 2013, 9, 9351. [Google Scholar] [CrossRef]
- Singh, S.; Young, A.; McNaught, C.E. The physiology of wound healing. Surgery 2017, 35, 473. [Google Scholar] [CrossRef]
- Robson, M.C.; Steed, D.L.; Franz, M.G. Wound healing: Biologic features and approaches to maximize healing trajectories. Curr. Probl. Surg. 2001, 38, A1. [Google Scholar] [CrossRef]
- Martins, V.L.; Caley, M.; O’Toole, E.A. Matrix metalloproteinases and epidermal wound repair. Cell Tissue Res. 2013, 351, 255. [Google Scholar] [CrossRef]
- Caley, M.P.; Martins, V.L.C.; O’Toole, E.A. Metalloproteinases and wound healing. Adv. Wound Care. 2015, 4, 225. [Google Scholar] [CrossRef] [PubMed]
- Swift, M.E.; Burns, A.L.; Gray, K.L.; DiPietro, L.A. Age-related alterations in the inflammatory response to dermal injury. J. Investig. Dermatol. 2001, 117, 1027. [Google Scholar] [CrossRef] [PubMed]
- Godbout, J.P.; Glaser, R. Stress-induced immune dysregulation: Implications for wound healing, infectious disease and cancer. J. Neuroimmune Pharmacol. 2006, 1, 421. [Google Scholar] [CrossRef] [PubMed]
- Boyapati, L.; Wang, H.L. The role of stress in periodontal disease and wound healing. Periodontology 2007, 2000, 195. [Google Scholar] [CrossRef]
- Vileikyte, L. Stress and wound healing. Clin. Dermatol. 2007, 25, 49. [Google Scholar] [CrossRef]
- Glaser, R.; Kiecolt-Glaser, J.K. Stress-induced immune dysfunction: Implications for health. Nat. Rev. Immunol. 2005, 5, 243. [Google Scholar] [CrossRef]
- Anaya, D.A.; Dellinger, E.P. The obese surgical patient: A susceptible host for infection. Surg. Infect. 2006, 7, 473. [Google Scholar] [CrossRef]
- Greco, J.A.; Castaldo, E.T.; Nanney, L.B.; Wendel, J.J.; Summitt, J.B.; Kelly, K.J.; Braun, S.A.; Hagan, K.F.; Shack, R.B. The effect of weight loss surgery and body mass index on wound complications after abdominal contouring operations. Ann. Plast. Surg. 2008, 61, 235. [Google Scholar] [CrossRef]
- Guest, J.F.; Ayoub, N.; McIlwraith, T.; Uchegbu, I.; Gerrish, A.; Weidlich, D.; Vowden, K.; Vowden, P. Health economic burden that wounds impose on the National Health Service in the UK. BMJ Open 2015, 5, e009283. [Google Scholar] [CrossRef]
- Wilson, J.A.; Clark, J.J. Obesity: Impediment to wound healing. Crit. Care Nurs. Q. 2003, 26, 119. [Google Scholar] [CrossRef] [PubMed]
- Silverstein, P. Smoking and wound healing. Am. J. Med. 1992, 93, S22. [Google Scholar] [CrossRef] [PubMed]
- Sørensen, L.T.; Jorgensen, L.N.; Zillmer, R.; Vange, J.; Hemmingsen, U.; Gottrup, F. Transdermal nicotine patch enhances type I collagen synthesis in abstinent smokers. Wound Repair. Regen. 2006, 14, 247. [Google Scholar] [CrossRef]
- Chan, L.K.W.; Withey, S.; Butler, P.E.M. Smoking and wound healing problems in reduction mammaplasty: Is the introduction of urine nicotine testing justified? Ann. Plast. Surg. 2006, 56, 111. [Google Scholar] [CrossRef]
- Ahn, C.; Mulligan, P.; “Sal” Salcido, R. Smoking-the bane of wound healing. Adv. Ski. Wound Care 2008, 21, 227. [Google Scholar] [CrossRef] [PubMed]
- Jensen, J.A.; Goodson, W.H.; Hopf, H.W.; Hunt, T.K. Cigarette smoking decreases tissue oxygen. Arch. Surg. 1991, 126, 1131. [Google Scholar] [CrossRef] [PubMed]
- Gupta, B.; Agarwal, R.; Alam, M. Textile-based smart wound dressings. Indian J. Fibre Text. Res. 2010, 35, 174. [Google Scholar]
- Rezvani Ghomi, E.; Khalili, S.; Nouri Khorasani, S.; Esmaeely Neisiany, R.; Ramakrishna, S. Wound dressings: Current advances and future directions. J. Appl. Polym. Sci. 2019, 136, 47738. [Google Scholar] [CrossRef]
- Uppal, R.; Ramaswamy, G.N.; Arnold, C.; Goodband, R.; Wang, Y. Hyaluronic acid nanofiber wound dressing-production, characterization, and in vivo behavior. J. Biomed. Mater. Res.—Part B Appl. Biomater. 2011, 97B, 20. [Google Scholar] [CrossRef]
- Maspes, A.; Pizzetti, F.; Rossetti, A.; Makvandi, P.; Sitia, G.; Rossi, F. Electrospun Nanofiber Membranes of PLGA and Collagen for Wound Healing Applications. Gels 2021, 7, 6. [Google Scholar] [CrossRef]
- He, C.L.; Huang, Z.M.; Han, X.J.; Liu, L.; Zhang, H.S.; Chen, L.S. Coaxial electrospun poly (L-lactic acid) ultrafine fibers for sustained drug delivery. J. Macromol. Sci. Part B Phys. 2006, 45B, 515. [Google Scholar] [CrossRef]
- Kabay, G.; Meydan, A.E.; Can, G.K.; Demirci, C.; Mutlu, M. Controlled release of a hydrophilic drug from electrospun amyloid-like protein blend nanofibers. Mater. Sci. Eng. C 2017, 81, 271. [Google Scholar] [CrossRef] [PubMed]
- Van Der Schueren, L.; De Meyer, T.; Steyaert, I.; Ceylan, Ö.; Hemelsoet, K.; Van Speybroeck, V.; De Clerck, K. Polycaprolactone and polycaprolactone/chitosan nanofibres functionalised with the pH-sensitive dye Nitrazine Yellow. Carbohydr. Polym. 2013, 91, 284. [Google Scholar] [CrossRef] [PubMed]
- Tamayol, A.; Najafabadi, A.H.; Mostafalu, P.; Yetisen, A.K.; Commotto, M.; Aldhahri, M.; Abdel-Wahab, M.S.; Najafabadi, Z.I.; Latifi, S.; Akbari, M.; et al. Biodegradable elastic nanofibrous platforms with integrated flexible heaters for on-demand drug delivery. Sci. Rep. 2017, 7, 9220. [Google Scholar] [CrossRef] [PubMed]
- Stocco, T.D.; Bassous, N.J.; Zhao, S.; Granato, A.E.C.; Webster, T.J.; Lobo, A.O. Nanofibrous scaffolds for biomedical applications. Nanoscale 2018, 10, 12228. [Google Scholar] [CrossRef] [PubMed]
- Kandasubramanian, B.; Govindaraj, P. Peeling model for cell adhesion on electrospun polymer nanofibres. J. Adhes. Sci. Technol. 2014, 28, 171. [Google Scholar] [CrossRef]
- Tahalyani, J.; Rahangdale, K.K.; Aepuru, R.; Kandasubramanian, B.; Datar, S. Dielectric investigation of a conducting fibrous nonwoven porous mat fabricated by a one-step facile electrospinning process. RSC Adv. 2016, 6, 36588. [Google Scholar] [CrossRef]
- Aruchamy, K.; Mahto, A.; Nataraj, S.K. Electrospun nanofibers, nanocomposites and characterization of art: Insight on establishing fibers as product. Nano-Struct. Nano-Objects 2018, 16, 45. [Google Scholar] [CrossRef]
- Wang, J.; Windbergs, M. Functional electrospun fibers for the treatment of human skin wounds. Eur. J. Pharm. Biopharm. 2017, 119, 283. [Google Scholar] [CrossRef]
- Agarwal, S.; Wendorff, J.H.; Greiner, A. Progress in the field of electrospinning for tissue engineering applications. Adv. Mater. 2009, 21, 3343. [Google Scholar] [CrossRef]
- Simon, S.; Balasubramanian, K. Facile immobilization of camphor soot on electrospun hydrophobic membrane for oil-water separation. Mater. Focus 2018, 7, 295. [Google Scholar] [CrossRef]
- Simon, S.; Malik, A.; Kandasubramanian, B. Hierarchical electrospun super-hydrophobic nanocomposites of fluoroelastomer. Mater. Focus 2018, 7, 194. [Google Scholar] [CrossRef]
- Yadav, R.; Balasubramanian, K. Metallization of electrospun PAN nanofibers via electroless gold plating. RSC Adv. 2015, 5, 24990. [Google Scholar] [CrossRef]
- Magisetty, R.; Kumar, P.; Gore, P.M.; Ganivada, M.; Shukla, A.; Kandasubramanian, B.; Shunmugam, R. Electronic properties of Poly(1,6-heptadiynes) electrospun fibrous non-woven mat. Mater. Chem. Phys. 2019, 223, 343. [Google Scholar] [CrossRef]
- Braghirolli, D.I.; Steffens, D.; Pranke, P. Electrospinning for regenerative medicine: A review of the main topics. Drug Discov. Today 2014, 19, 743. [Google Scholar] [CrossRef] [PubMed]
- Bhalara, P.D.; Balasubramanian, K.; Banerjee, B.S. Spider-web textured electrospun composite of graphene for sorption of Hg(II) ions. Mater. Focus 2015, 4, 154. [Google Scholar] [CrossRef]
- Gore, P.M.; Khurana, L.; Siddique, S.; Panicker, A.; Kandasubramanian, B. Ion-imprinted electrospun nanofibers of chitosan/1-butyl-3-methylimidazolium tetrafluoroborate for the dynamic expulsion of thorium (IV) ions from mimicked effluents. Environ. Sci. Pollut. Res. 2018, 25, 3320. [Google Scholar] [CrossRef]
- Kim, J.H.; Jang, J.; Jeong, Y.H.; Ko, T.J.; Cho, D.W. Fabrication of a nanofibrous mat with a human skin pattern. Langmuir 2015, 31, 424. [Google Scholar] [CrossRef]
- Geng, X.; Kwon, O.; Jang, J. Electrospinning of chitosan dissolved in concentrated acetic acid solution. Biomaterials 2005, 26, 5427. [Google Scholar] [CrossRef]
- Guerra, M.; Garrudo, F.F.; Faustino, C.; Rosa, M.E.; Ribeiro, M.H.L. Exploring Functionalized Magnetic Hydrogel Polyvinyl Alcohol and Chitosan Electrospun Nanofibers. Gels 2023, 9, 968. [Google Scholar] [CrossRef]
- Rieger, K.A.; Thyagarajan, R.; Hoen, M.E.; Yeung, H.F.; Ford, D.M.; Schiffman, J.D. Transport of microorganisms into cellulose nanofiber mats. RSC Adv. 2016, 6, 24438. [Google Scholar] [CrossRef]
- Bastianini, M.; Scatto, M.; Sisani, M.; Scopece, P.; Patelli, A.; Petracci, A. Innovative composites based on organic-modified zirconium phosphate and PEOT/PBT copolymer. J. Compos. Sci. 2018, 2, 31. [Google Scholar] [CrossRef]
- Balasubramanian, K.; Sharma, S.; Badwe, S.; Banerjee, B. Tailored non-woven electrospun mesh of poly-ethyleneoxide-keratin for radioactive metal ion sorption. J. Green. Sci. Technol. 2015, 2, 10. [Google Scholar] [CrossRef]
- Gore, P.; Khraisheh, M.; Kandasubramanian, B. Nanofibers of resorcinol–formaldehyde for effective adsorption of As (III) ions from mimicked effluents. Environ. Sci. Pollut. Res. 2018, 25, 11729. [Google Scholar] [CrossRef]
- Zhang, J.; Qiu, K.; Sun, B.; Fang, J.; Zhang, K.; Ei-Hamshary, H.; Al-Deyab, S.S.; Mo, X. The aligned core-sheath nanofibers with electrical conductivity for neural tissue engineering. J. Mater. Chem. B 2014, 2, 7945. [Google Scholar] [CrossRef]
- Chew, S.Y.; Mi, R.; Hoke, A.; Leong, K.W. The effect of the alignment of electrospun fibrous scaffolds on Schwann cell maturation. Biomaterials 2008, 29, 653. [Google Scholar] [CrossRef] [PubMed]
- Wang, B.; Cai, Q.; Zhang, S.; Yang, X.; Deng, X. The effect of poly (L-lactic acid) nanofiber orientation on osteogenic responses of human osteoblast-like MG63 cells. J. Mech. Behav. Biomed. Mater. 2011, 4, 600. [Google Scholar] [CrossRef] [PubMed]
- Moghe, A.K.; Gupta, B.S. Co-axial electrospinning for nanofiber structures: Preparation and applications. Polym. Rev. 2008, 48, 353. [Google Scholar] [CrossRef]
- Lee, S.J.; Yoo, J.J.; Lim, G.J.; Atala, A.; Stitzel, J. In vitro evaluation of electrospun nanofiber scaffolds for vascular graft application. J. Biomed. Mater. Res.—Part A 2007, 83, 999. [Google Scholar] [CrossRef]
- Moroni, L.; Schotel, R.; Sohier, J.; de Wijn, J.R.; van Blitterswijk, C.A. Polymer hollow fiber three-dimensional matrices with controllable cavity and shell thickness. Biomaterials 2006, 27, 5918. [Google Scholar] [CrossRef]
- Ou, K.L.; Chen, C.S.; Lin, L.H.; Lu, J.C.; Shu, Y.C.; Tseng, W.C.; Yang, J.C.; Lee, S.Y.; Chen, C.C. Membranes of epitaxial-like packed, super aligned electrospun micron hollow poly(l-lactic acid) (PLLA) fibers. Eur. Polym. J. 2011, 47, 882. [Google Scholar] [CrossRef]
- Dror, Y.; Salalha, W.; Avrahami, R.; Zussman, E.; Yarin, A.L.; Dersch, R.; Greiner, A.; Wendorff, J.H. One-step production of polymeric microtubes by co-electrospinning. Small 2007, 3, 1064. [Google Scholar] [CrossRef]
- Srivastava, Y.; Rhodes, C.; Marquez, M.; Thorsen, T. Electrospinning hollow and core/sheath nanofibers using hydrodynamic fluid focusing. Microfluid. Nanofluid. 2008, 5, 455. [Google Scholar] [CrossRef]
- Ambekar, R.S.; Kandasubramanian, B. Advancements in nanofibers for wound dressing: A review. Eur. Polym. J. 2019, 117, 304. [Google Scholar] [CrossRef]
- Khalf, A.; Singarapu, K.; Madihally, S.V. Influence of solvent characteristics in triaxial electrospun fiber formation. React. Funct. Polym. 2015, 90, 36. [Google Scholar] [CrossRef]
- Wu, D.; Huang, X.; Lai, X.; Sun, D.; Lin, L. High throughput tip-less electrospinning via a circular cylindrical electrode. J. Nanosci. Nanotechnol. 2010, 10, 4221. [Google Scholar] [CrossRef] [PubMed]
- Gashti, M.P.; Dehghan, N. Gel diffusion-inspired biomimetic calcium iodate/gelatin composite particles: Structural characterization and antibacterial activity. J. Solid State Chem. 2020, 285, 121262. [Google Scholar] [CrossRef]
- Zhang, Y.; Lim, C.T.; Ramakrishna, S.; Huang, Z.-M. Recent development of polymer nanofibers for biomedical and biotechnological applications. J. Mater. Sci. Mater. Med. 2005, 16, 933. [Google Scholar] [CrossRef]
- Butenko, S.; Nagalla, R.R.; Guerrero-Juarez, C.F.; Palomba, F.; David, L.M.; Nguyen, R.Q.; Gay, D.; Almet, A.A.; Digman, M.A.; Nie, Q.; et al. Hydrogel crosslinking modulates macrophages, fibroblasts, and their communication, during wound healing. Nat. Commun. 2024, 15, 6820. [Google Scholar] [CrossRef]
- Parvinzadeh Gashti, M.; Alimohammadi, F.; Hulliger, J.; Burgener, M.; Oulevey-Aboulfad, H.; Bowlin, G.L. Microscopic methods to study the structure of scaffolds in bone tissue engineering: A brief review. In Current Microscopy Contributions to Advances in Science and Technology; Formatex Research Centre: Norristown, PA, USA, 2012. [Google Scholar]
- Zhao, D.; Li, Y.; Han, L.; Zhu, W.; Wang, X.; Liu, J.; Li, S.; Duan, Y.; Zhang, H. A Rapid Albumin-Binding 5-Fluorouracil Prodrug with a Prolonged Circulation Time and Enhanced Antitumor Activity. Biomater. Sci. 2017, 5, 500–510. [Google Scholar] [CrossRef]
- Pilehvar-Soltanahmadi, Y.; Dadashpour, M.; Mohajeri, A.; Fattahi, A.; Sheervalilou, R.; Zarghami, N. An overview on application of natural substances incorporated with electrospun nanofibrous scaffolds to development of innovative wound dressings. Mini-Rev. Med. Chem. 2018, 18, 414. [Google Scholar] [CrossRef]
- Zahedi, P.; Rezaeian, I.; Ranaei-Siadat, S.-O.; Jafari, S.-H.; Supaphol, P. A review on wound dressings with an emphasis on electrospun nanofibrous polymeric. Bandages. Polym. Adv. Technol. 2009, 21, 77. [Google Scholar] [CrossRef]
- Mozaffari, A.; Gashti, M.P.; Alimohammadi, F.; Pousti, M. The Impact of Helium and Nitrogen Plasmas on Electrospun Gelatin Nanofiber Scaffolds for Skin Tissue Engineering Applications. J. Funct. Biomater. 2024, 15, 326. [Google Scholar] [CrossRef] [PubMed]
- Rogina, A. Electrospinning process: Versatile preparation method for biodegradable and natural polymers and biocomposite systems applied in tissue engineering and drug delivery. Appl. Surf. Sci. 2014, 296, 221. [Google Scholar] [CrossRef]
- Gunn, J.; Zhang, M. Polyblend nanofibers for biomedical applications: Perspectives and challenges. Trends Biotechnol. 2010, 28, 189. [Google Scholar] [CrossRef] [PubMed]
- Mulholland, E.J.; Ali, A.; Robson, T.; Dunne, N.J.; McCarthy, H.O. Delivery of RALA/siFKBPL nanoparticles via electrospun bilayer nanofibres: An innovative angiogenic therapy for wound repair. J. Control. Release 2019, 316, 53. [Google Scholar] [CrossRef]
- Jalili, M.; Mozaffari, A.; Gashti, M.P.; Parsania, M. Electrospinning Nanofibers Gelatin scaffolds: Nanoanalysis of properties and optimizing the process for tissue engineering functional. J. Nanoanalysis. 2019, 6, 289. [Google Scholar]
- Rieger, K.A.; Birch, N.P.; Schiffman, J.D. Designing electrospun nanofiber mats to promote wound healing—A review. J. Mater. Chem. B 2013, 1, 4531. [Google Scholar] [CrossRef]
- Smith, J.; Lee, K.; Martinez, A. Silver Nanoparticles Incorporated in Collagen-Based Hydrogels for Antimicrobial Applications. Gels 2022, 8, 45. [Google Scholar]
- Kandhasamy, S.; Perumal, S.; Madhan, B.; Umamaheswari, N.; Banday, J.A.; Perumal, P.T.; Santhanakrishnan, V.P. Synthesis and Fabrication of Collagen-Coated Ostholamide Electrospun Nanofiber Scaffold for Wound Healing. ACS Appl. Mater. Interfaces 2017, 9, 8556. [Google Scholar] [CrossRef]
- Cremar, L.; Gutierrez, J.; Martinez, J.; Materon, L.; Gilkerson, R.; Xu, F.; Lozano, K. Development of antimicrobial chitosan based nanofiber dressings for wound healing applications. Nanomed. J. 2018, 5, 6. [Google Scholar]
- Ahmadian, S.; Ghorbani, M.; Mahmoodzadeh, F. Silver sulfadiazine-loaded electrospun ethyl cellulose/polylactic acid/collagen nanofibrous mats with antibacterial properties for wound healing. Int. J. Biol. Macromol. 2020, 162, 1555. [Google Scholar] [CrossRef] [PubMed]
- Khan, M.Q.; Kharaghani, D.; Shahzad, A.; Saito, Y.; Yamamoto, T.; Ogasawara, H.; Kim, I.S. Fabrication of antibacterial electrospun cellulose acetate/silver-sulfadiazine nanofibers composites for wound dressings applications. Polym. Test. 2019, 74, 39. [Google Scholar] [CrossRef]
- Lin, J.; Li, C.; Zhao, Y.; Hu, J.; Zhang, L.M. Co-electrospun Nanofibrous Membranes of Collagen and Zein for Wound Healing. ACS Appl. Mater. Interfaces 2012, 4, 1050. [Google Scholar] [CrossRef]
- Ghorbani, M.; Nezhad-Mokhtari, P.; Ramazani, S. Aloe vera-loaded nanofibrous scaffold based on Zein/Polycaprolactone/Collagen for wound healing. Int. J. Biol. Macromol. 2020, 153, 921. [Google Scholar] [CrossRef]
- Yuan, M.; Dai, F.; Li, D.; Fan, Y.; Xiang, W.; Tao, F.; Cheng, Y.; Deng, H. Lysozyme/collagen multilayers layer-by-layer deposited nanofibers with enhanced biocompatibility and antibacterial activity. Mater. Sci. Eng. C 2020, 112, 110868. [Google Scholar] [CrossRef]
- Liu, S.-J.; Kau, Y.-C.; Chou, C.-Y.; Chen, J.-K.; Wu, R.-C.; Yeh, W.-L. Electrospun PLGA/collagen nanofibrous membrane as early-stage wound dressing. J. Memb. Sci. 2010, 355, 53. [Google Scholar] [CrossRef]
- Rath, G.; Hussain, T.; Chauhan, G.; Garg, T.; Goyal, A.K. Collagen nanofiber containing silver nanoparticles for improved wound-healing applications. J. Drug Target. 2016, 24, 520. [Google Scholar] [CrossRef]
- Yang, D.; Li, Y.; Nie, J. Preparation of gelatin/PVA nanofibers and their potential application in controlled release of drugs. Carbohydr. Polym. 2007, 69, 538. [Google Scholar] [CrossRef]
- Djagny, K.B.; Wang, Z.; Xu, S. Gelatin: A valuable protein for food and pharmaceutical industries: Review. Crit. Rev. Food Sci. Nutr. 2001, 41, 481. [Google Scholar] [CrossRef] [PubMed]
- Ulubayram, K.; Aksu, E.; Gurhan, S.I.D.; Serbetci, K.; Hasirci, N. Cytotoxicity evaluation of gelatin sponges prepared with different cross-linking agents. J. Biomater. Sci. Polym. Ed. 2002, 13, 1203. [Google Scholar] [CrossRef]
- Kuijpers, A.J.; Engbers, G.H.M.; Krijgsveld, J.; Zaat, S.A.J.; Dankert, J.; Feijen, J. Cross-linking and characterisation of gelatin matrices for biomedical applications. J. Biomater. Sci. Polym. Ed. 2000, 11, 225. [Google Scholar] [CrossRef] [PubMed]
- Deitzel, J.; Kleinmeyer, J.; Harris, D.; Tan, N.B. The effect of processing variables on the morphology of electrospun nanofibers and textiles. Polymer 2001, 42, 261. [Google Scholar] [CrossRef]
- Zhang, C.; Yuan, X.; Wu, L.; Han, Y.; Sheng, J. Study on morphology of electrospun poly(vinyl alcohol) mats. Eur. Polym. J. 2005, 41, 423. [Google Scholar] [CrossRef]
- Songchotikunpan, P.; Tattiyakul, J.; Supaphol, P. Extraction and electrospinning of gelatin from fish skin. Int. J. Biol. Macromol. 2008, 42, 247. [Google Scholar] [CrossRef] [PubMed]
- Zhang, Y.Z.; Venugopal, J.; Huang, Z.M.; Lim, C.T.; Ramakrishna, S. Crosslinking of the electrospun gelatin nanofibers. Polymer 2006, 47, 2911. [Google Scholar] [CrossRef]
- Li, M.; Mondrinos, M.J.; Gandhi, M.R.; Ko, F.K.; Weiss, A.S.; Lelkes, P.I. Electrospun protein fibers as matrices for tissue engineering. Biomaterials 2005, 26, 5999. [Google Scholar] [CrossRef]
- Dubský, M.; Kubinová, Š.; Širc, J.; Voska, L.; Zajíček, R.; Zajícová, A.; Lesný, P.; Jirkovská, A.; Michálek, J.; Munzarová, M.; et al. Nanofibers prepared by needleless electrospinning technology as scaffolds for wound healing. J. Mater. Sci. Mater. Med. 2012, 23, 931. [Google Scholar] [CrossRef]
- Adeli-Sardou, M.; Yaghoobi, M.M.; Torkzadeh-Mahani, M.; Dodel, M. Controlled release of lawsone from polycaprolactone/gelatin electrospun nano fibers for skin tissue regeneration. Int. J. Biol. Macromol. 2019, 124, 478. [Google Scholar] [CrossRef]
- Yang, L.; Cai, T.; Ding, D.; Cai, T.; Jiang, C.; Li, H.; Yang, Q.; Chen, L. Biodegradation of 2-hydroxyl-1,4 naphthoquinone (lawsone) by Pseudomonas taiwanensis LH-3 isolated from activated sludge. Sci. Rep. 2017, 7, 6795. [Google Scholar] [CrossRef]
- Lu, W.; Ma, M.; Xu, H.; Zhang, B.; Cao, X.; Guo, Y. Gelatin nanofibers prepared by spiral-electrospinning and cross-linked by vapor and liquid-phase glutaraldehyde. Mater. Lett. 2015, 140, 1–4. [Google Scholar] [CrossRef]
- Jung, S.M.; Yoon, G.H.; Lee, H.C.; Shin, H.S.; Biomater, J. Chitosan nanoparticle/PCL nanofiber composite for wound dressing and drug delivery. Sci. Polym. Ed. 2015, 26, 252. [Google Scholar] [CrossRef] [PubMed]
- Cai, Z.X.; Mo, X.M.; Zhang, K.H.; Fan, L.P.; Yin, A.L.; He, C.L.; Wang, H.S. Fabrication of Chitosan/Silk Fibroin Composite Nanofibers for Wound-dressing Applications. Int. J. Mol. Sci. 2010, 11, 3529. [Google Scholar] [CrossRef] [PubMed]
- Huang, R.; Li, W.; Lv, X.; Lei, Z.; Bian, Y.; Deng, H.; Wang, H.; Li, J.; Li, X. Biomimetic LBL structured nanofibrous matrices assembled by chitosan/collagen for promoting wound healing. Biomaterials 2015, 53, 58. [Google Scholar] [CrossRef] [PubMed]
- Sarhan, W.A.; Azzazy, H.M.; El-Sherbiny, I.M. Honey/Chitosan Nanofiber Wound Dressing Enriched with Allium sativum and Cleome droserifolia: Enhanced Antimicrobial and Wound Healing Activity. ACS Appl. Mater. Interfaces 2016, 8, 6379. [Google Scholar] [CrossRef] [PubMed]
- Chen, S.; Cui, S.; Hu, J.; Zhou, Y.; Liu, Y. Pectinate nanofiber mat with high absorbency and antibacterial activity: A potential superior wound dressing to alginate and chitosan nanofiber mats. Carbohydr. Polym. 2017, 174, 591. [Google Scholar] [CrossRef] [PubMed]
- Abdelgawad, A.M.; Hudson, S.M.; Rojas, O.J. Antimicrobial wound dressing nanofiber mats from multicomponent (chitosan/silver-NPs/polyvinyl alcohol) systems. Carbohydr. Polym. 2014, 100, 166. [Google Scholar] [CrossRef]
- Charernsriwilaiwat, N.; Opanasopit, P.; Rojanarata, T.; Ngawhirunpat, T. Lysozyme-loaded, electrospun chitosan-based nanofiber mats for wound healing. Int. J. Pharm. 2012, 427, 379. [Google Scholar] [CrossRef]
- Ahmed, R.; Tariq, M.; Ali, I.; Asghar, R.; Khanam, P.N.; Augustine, R.; Hasan, A. Novel electrospun chitosan/polyvinyl alcohol/zinc oxide nanofibrous mats with antibacterial and antioxidant properties for diabetic wound healing. Int. J. Biol. Macromol. 2018, 120, 385. [Google Scholar] [CrossRef]
- Khan, G.; Yadav, S.K.; Patel, R.R.; Kumar, N.; Bansal, M.; Mishra, B. Tinidazole functionalized homogeneous electrospun chitosan/poly (ε-caprolactone) hybrid nanofiber membrane: Development, optimization and its clinical implications. Int. J. Biol. Macromol. 2017, 103, 1311. [Google Scholar] [CrossRef]
- Khan, G.; Patel, R.R.; Yadav, S.K.; Kumar, N.; Chaurasia, S.; Ajmal, G.; Mishra, P.K.; Mishra, B. Development, optimization and evaluation of tinidazole functionalized electrospun poly(ε-caprolactone) nanofiber membranes for the treatment of periodontitis. RSC Adv. 2016, 6, 100214. [Google Scholar] [CrossRef]
- Naseri, N.; Algan, C.; Jacobs, V.; John, M.; Oksman, K.; Mathew, A.P. Electrospun chitosan-based nanocomposite mats reinforced with chitin nanocrystals for wound dressing. Carbohydr. Polym. 2014, 109, 7. [Google Scholar] [CrossRef] [PubMed]
- Laurens, N.; Koolwijk, P.; De Maat, M.P.M. Fibrin structure and wound healing. J. Thromb. Haemost. 2006, 4, 932. [Google Scholar] [CrossRef] [PubMed]
- Gary, E.W.; Marcus, E.C.; David, G.S.; Gary, L.B. Electrospinning of nanofiber fibrinogen structures. Nano Lett. 2003, 3, 213. [Google Scholar]
- Gugutkov, D.; Gustavsson, J.; Ginebra, M.P.; Altankov, G. Fibrinogen nanofibers for guiding endothelial cell behavior. Biomater. Sci. 2013, 1, 1065. [Google Scholar] [CrossRef]
- Yuan, T.T.; Foushee, A.M.D.; Johnson, M.C.; Jockheck-Clark, A.R.; Stahl, J.M. Development of electrospun chitosan-polyethylene oxide/fibrinogen biocomposite for potential wound healing applications. Nanoscale Res. Lett. 2018, 13, 88. [Google Scholar] [CrossRef]
- Pankov, R.; Yamada, K.M. Fibronectin at a glance. J. Cell Sci. 2002, 115, 3861. [Google Scholar] [CrossRef] [PubMed]
- Lenselink, E.A. Role of fibronectin in normal wound healing. Int. Wound J. 2015, 12, 313. [Google Scholar] [CrossRef] [PubMed]
- Faralli, J.A.; Schwinn, M.K.; Gonzalez, J.M.; Filla, M.S.; Peters, D.M.; Peters, D.M. Functional properties of fibronectin in the trabecular meshwork. Exp. Eye Res. 2009, 88, 689. [Google Scholar] [CrossRef] [PubMed]
- Hamed, S.; Ullmann, Y.; Egozi, D.; Daod, E.; Hellou, E.; Ashkar, M.; Gilhar, A.; Teot, L. Fibronectin potentiates topical erythropoietin-induced wound repair in diabetic mice. J. Investig. Dermatol. 2011, 131, 1365. [Google Scholar] [CrossRef]
- To, W.S.; Midwood, K.S. Plasma and cellular fibronectin: Distinct and independent functions during tissue repair. Fibrogenesis Tissue Repair. 2011, 4, 21. [Google Scholar] [CrossRef] [PubMed]
- Gugutkov, D.; González-García, C.; Hernández, J.C.R.; Altankov, G.; SalmerónSánchez, M. Biological activity of the substrate-induced fibronectin network: Insight into the third dimension through electrospun fibers. Langmuir 2009, 25, 10893. [Google Scholar] [CrossRef] [PubMed]
- Ji, Y.; Ghosh, K.; Li, B.; Sokolov, J.C.; Clark, R.A.F.; Rafailovich, M.H. Dual-syringe reactive electrospinning of cross-linked hyaluronic acid hydrogel Nanofibers for tissue engineering applications. Macromol. Biosci. 2006, 6, 811. [Google Scholar] [CrossRef] [PubMed]
- Zhu, Y.; Leong, M.F.; Ong, W.F.; Chan-Park, M.B.; Chian, K.S. Esophageal epithelium regeneration on fibronectin grafted poly(l-lactide-co-caprolactone) (PLLC) nanofiber scaffold. Biomaterials 2007, 28, 861. [Google Scholar] [CrossRef] [PubMed]
- Mohseni, M.; Shamloo, A.; Aghababaei, Z.; Vossoughi, M.; Moravvej, H. Antimicrobial wound dressing containing silver sulfadiazine with high biocompatibility: In vitro study. Artif. Organs 2016, 40, 765. [Google Scholar] [CrossRef]
- Chantre, C.O.; Campbell, P.H.; Golecki, H.M.; Buganza, A.T.; Capulli, A.K.; Deravi, L.F.; Dauth, S.; Sheehy, S.P.; Paten, J.A.; Gledhill, K.; et al. Production-scale fibronectin nanofibers promote wound closure and tissue repair in a dermal mouse model. Biomaterials 2018, 166, 96. [Google Scholar] [CrossRef] [PubMed]
- Kogan, G.; Šoltés, L.; Stern, R.; Gemeiner, P. Hyaluronic acid: A natural biopolymer with a broad range of biomedical and industrial applications. Biotechnol. Lett. 2006, 29, 17. [Google Scholar] [CrossRef]
- Burdick, J.A.; Prestwich, G.D. Hyaluronic acid hydrogels for biomedical applications. Adv. Mater. 2011, 23, H41. [Google Scholar] [CrossRef]
- Campo, G.M.; Avenoso, A.; Campo, S.; D’Ascola, A.; Nastasi, G.; Calatroni, A. Molecular size hyaluronan differently modulates toll-like receptor-4 in LPS-induced inflammation in mouse chondrocytes. Biochimie 2010, 92, 204. [Google Scholar] [CrossRef]
- Laurent, T.C. The Chemistry, Biology, and Medical Applications of Hyaluronan and its Derivatives; Portland Press: London, UK, 1998. [Google Scholar]
- Hašová, M.; Crhák, T.; Šafránková, B.; Dvořáková, J.; Muthný, T.; Velebný, V.; Kubala, L. Hyaluronan minimizes effects of UV irradiation on human keratinocytes. Arch. Dermatol. Res. 2011, 303, 277. [Google Scholar] [CrossRef]
- Foschi, D.; Castoldi, L.; Radaelli, E.; Abelli, P.; Calderini, G.; Rastrelli, A.; Mariscotti, C.; Marazzi, M.; Trabucchi, E. Hyaluronic acid prevents oxygen free-radical damage to granulation tissue: A study in rats. Int. J. Tissue React. 1990, 12, 333. [Google Scholar]
- Fraser, J.R.; Laurent, T.C.; Laurent, U.B. Hyaluronan: Its nature, distribution, functions and turnover. J. Intern. Med. 1997, 242, 27. [Google Scholar] [CrossRef] [PubMed]
- Lai, H.-J.; Kuan, C.-H.; Wu, H.-C.; Tsai, J.-C.; Chen, T.-M.; Hsieh, D.-J.; Wang, T.-W. Tailored design of electrospun composite nanofibers with staged release of multiple angiogenic growth factors for chronic wound healing. Acta Biomater. 2014, 10, 4156. [Google Scholar] [CrossRef] [PubMed]
- Kabir, S.M.F.; Sikdar, P.P.; Haque, B.; Bhuiyan, M.A.R.; Ali, A.; Islam, M.N. Cellulose-based hydrogel materials: Chemistry, properties and their prospective applications. Prog. Biomater. 2018, 7, 153. [Google Scholar] [CrossRef] [PubMed]
- Portela, R.; Leal, C.R.; Almeida, P.L.; Sobral, R.G. Bacterial cellulose: A versatile biopolymer for wound dressing applications. Microb. Biotechnol. 2019, 12, 586. [Google Scholar] [CrossRef] [PubMed]
- Bacakova, L.; Pajorova, J.; Bacakova, M.; Skogberg, A.; Kallio, P.; Kolarova, K.; Svorcik, V. Versatile application of Nanocellulose: From industry to skin tissue engineering and wound healing. Nanomaterials 2019, 9, 164. [Google Scholar] [CrossRef]
- Rahman, M.M.; Netravali, A.N. Aligned bacterial cellulose arrays as “green” nanofibers for composite materials. ACS Macro Lett. 2016, 5, 1070. [Google Scholar] [CrossRef] [PubMed]
- Wiegand, C.; Moritz, S.; Hessler, N.; Kralisch, D.; Wesarg, F.; Müller, F.A.; Fischer, D.; Hipler, U.-C. Antimicrobial functionalization of bacterial nanocellulose by loading with polihexanide and povidone-iodine. J. Mater. Sci. Mater. Med. 2015, 26, 245. [Google Scholar] [CrossRef]
- Khalid, A.; Ullah, H.; Ul-Islam, M.; Khan, R.; Khan, S.; Ahmad, F.; Khan, T. Wahid, Bacterial cellulose–TiO 2 nanocomposites promote healing and tissue regeneration in burn mice model. RSC Adv. 2017, 7, 47662. [Google Scholar] [CrossRef]
- Liu, X.; Lin, T.; Gao, Y.; Xu, Z.; Huang, C.; Yao, G.; Jiang, L.; Tang, Y.; Wang, X. Antimicrobial electrospun nanofibers of cellulose acetate and polyester urethane composite for wound dressing. J. Biomed. Mater. Res. Part B Appl. Biomater. 2012, 100B, 1556. [Google Scholar] [CrossRef]
- Motta, G.J.; Milne, C.T.; Corbett, L.Q. Impact of antimicrobial gauze on bacterial colonies in wounds that require packing. Ostomy Wound Manag. 2004, 50, 48. [Google Scholar]
- Santos, A.E.D.; Santos, F.V.D.; Freitas, K.M.; Pimenta, L.P.; de Oliveira Andrade, L.; Marinho, T.A.; de Avelar, G.F.; da Silva, A.B.; Ferreira, R.V. Cellulose acetate nanofibers loaded with crude annatto extract: Preparation, characterization, and in vivo evaluation for potential wound healing applications. Mater. Sci. Eng. C 2021, 118, 111322. [Google Scholar] [CrossRef] [PubMed]
- Son, W.K.; Youk, J.H.; Park, W.H. Antimicrobial cellulose acetate nanofibers containing silver nanoparticles. Carbohydr. Polym. 2006, 65, 430. [Google Scholar] [CrossRef]
- Son, W.K.; Youk, J.H.; Lee, T.S.; Park, W.H. Preparation of Antimicrobial Ultrafine Cellulose Acetate Fibers with Silver Nanoparticles. Macromol. Rapid Commun. 2004, 25, 1632. [Google Scholar] [CrossRef]
- Ullah, A.; Ullah, S.; Khan, M.Q.; Hashmi, M.; Nam, P.D.; Kato, Y.; Tamada, Y.; Kim, I.S. Manuka honey incorporated cellulose acetate nanofibrous mats: Fabrication and in vitro evaluation as a potential wound dressing. Int. J. Biol. Macromol. 2020, 155, 479. [Google Scholar] [CrossRef]
- Khoshnevisan, K.; Maleki, H.; Samadian, H.; Doostan, M.; Khorramizadeh, M.R. Antibacterial and antioxidant assessment of cellulose acetate/polycaprolactone nanofibrous mats impregnated with propolis. Int. J. Biol. Macromol. 2019, 140, 1260. [Google Scholar] [CrossRef]
- Barbu, A.; Neamtu, B.; Zăhan, M.; Iancu, G.M.; Bacila, C.; Mireșan, V. Current Trends in Advanced Alginate-Based Wound Dressings for Chronic Wounds. J. Pers. Med. 2021, 11, 890. [Google Scholar] [CrossRef] [PubMed]
- Lee, K.Y.; Mooney, D.J. Alginate: Properties and biomedical applications. Prog. Polym. Sci. 2012, 37, 106. [Google Scholar] [CrossRef] [PubMed]
- Augst, A.D.; Kong, H.J.; Mooney, D.J. Alginate hydrogels as biomaterials. Macromol. Biosci. 2006, 6, 623. [Google Scholar] [CrossRef]
- Sudarsan, S.; Franklin, D.S.; Guhanathan, S. Imbibed salts and pH-responsive behaviours of sodiumalginat based eco-friendly biopolymeric hydrogels-Asolventless approach. Macromol. Indian J. 2015, 11, 24. [Google Scholar]
- Sood, A.; Granick, M.S.; Tomaselli, N.L. Wound dressings and comparative effectiveness data. Adv. Wound Care 2014, 3, 511. [Google Scholar] [CrossRef] [PubMed]
- Aderibigbe, B.A.; Buyana, B. Alginate in Wound Dressings. Pharmaceutics 2018, 10, 42. [Google Scholar] [CrossRef] [PubMed]
- Kamel, S.; Dacrory, S.; Hesemann, P.; Bettache, N.; Ali, L.M.A.; Postel, L.; Akl, E.M.; El-Sakhawy, M. Wound Dressings Based on Sodium Alginate–Polyvinyl Alcohol–Moringa oleifera Extracts. Pharmaceutics 2023, 15, 1270. [Google Scholar] [CrossRef] [PubMed]
- Tang, Y.; Lan, X.; Liang, C.; Zhong, Z.; Xie, R.; Zhou, Y.; Miao, X.; Wang, H.; Wang, W. Honey loaded alginate/PVA nanofibrous membrane as potential bioactive wound dressing. Carbohydr. Polym. 2019, 219, 113. [Google Scholar] [CrossRef]
- Tarun, K.; Gobi, N. Calcium Alginate/PVA Blended Nano Fibre Matrix for Wound Dressing. Indian J. Fiber Text. Res. 2012, 37, 127. [Google Scholar]
- Bakhsheshi-Rad, H.R.; Hadisi, Z.; Ismail, A.F.; Aziz, M.; Akbari, M.; Berto, F.; Chen, X.B. In vitro and in vivo evaluation of chitosan-alginate/gentamicin wound dressing nanofibrous with high antibacterial performance. Polym. Test. 2020, 82, 106298. [Google Scholar] [CrossRef]
- Parham, S.; Kharazi, A.Z.; Bakhsheshi-Rad, H.R.; Kharaziha, M.; Ismail, A.F.; Sharif, S.; Razzaghi, M.; RamaKrishna, S.; Berto, F. Antimicrobial Synthetic and Natural Polymeric Nanofibers as Wound Dressing: A Review. Adv. Eng. Mater. 2022, 24, 2101460. [Google Scholar] [CrossRef]
- Kalantari, K.; Afifi, A.M.; Jahangirian, H.; Webster, T.J. Biomedical applications of chitosan electrospun nanofibers as a green polymer—Review. Carbohyd. Polym. 2019, 207, 588. [Google Scholar] [CrossRef]
- Bakhsheshi-Rad, H.R.; Ismail, A.F.; Aziz, M.; Hadisi, Z.; Omidi, M.; Chen, X. Antibacterial activity and corrosion resistance of Ta2O5 thin film and electrospun PCL/MgO-Ag nanofiber coatings on biodegradable Mg alloy implants. Ceram. Int. 2019, 45, 11883. [Google Scholar] [CrossRef]
- Bakhsheshi-Rad, H.R.; Akbari, M.; Ismail, A.F.; Aziz, M.; Hadisi, Z.; Pagan, E.; Daroonparvar, M.; Chen, X. Coating biodegradable magnesium alloys with electrospun poly-L-lactic acid-åkermanite-doxycycline nanofibers for enhanced biocompatibility, antibacterial activity, and corrosion resistance. Surf. Coat. Technol. 2019, 377, 124898. [Google Scholar] [CrossRef]
- Bakhsheshi-Rad, H.R.; Chen, X.; Ismail, A.F.; Aziz, M.; Abdolahi, E.; Mahmoodiyan, F. Improved antibacterial properties of an Mg-Zn-Ca alloy coated with chitosan nanofibers incorporating silver sulfadiazine multiwall carbon nanotubes for bone implants. Polym. Adv. Technol. 2019, 30, 1333. [Google Scholar] [CrossRef]
- Zhang, L.C.; Chen, L.Y.; Wang, L. Surface Modification of Titanium and Titanium Alloys: Technologies, Developments, and Future Interests. Adv. Eng. Mater. 2020, 22, 1901258. [Google Scholar] [CrossRef]
- Bakhsheshi-Rad, H.R.; Ismail, A.F.; Aziz, M.; Akbari, M.; Hadisi, Z.; Daroonparvar, M.; Chen, X.B. Antibacterial activity and in vivo wound healing evaluation of polycaprolactone-gelatin methacryloyl-cephalexin electrospun nanofibrous. Mater. Lett. 2019, 256, 126618. [Google Scholar] [CrossRef]
- Coşkun, G.; Karaca, E.; Ozyurtlu, M.; Özbek, S.; Yermezler, A.; Çavuşoğlu, İ. Histological evaluation of wound healing performance of electrospun poly (vinyl alcohol)/sodium alginate as wound dressing in vivo. Biomed. Mater. Eng. 2014, 24, 1527. [Google Scholar] [CrossRef] [PubMed]
- Fu, R.; Li, C.; Yu, C.; Xie, H.; Shi, S.; Li, Z.; Wang, Q.; Lu, L. A novel electrospun membrane based on moxifloxacin hydrochloride/poly (vinyl alcohol)/sodium alginate for antibacterial wound dressings in practical application. Drug Deliv. 2016, 23, 818. [Google Scholar] [CrossRef] [PubMed]
- Hong, Y.; Zhu, X.; Wang, P.; Fu, H.; Deng, C.; Cui, L.; Wang, Q.; Fan, X. Tyrosinase-Mediated Construction of a Silk Fibroin/Elastin Nanofiber Bioscaffold. Appl. Biochem. Biotechnol. 2016, 178, 1363. [Google Scholar] [CrossRef]
- Schneider, A.; Wang, X.Y.; Kaplan, D.L.; Garlick, J.A.; Egles, C. Biofunctionalized electrospun silk mats as a topical bioactive dressing for accelerated wound healing. Acta Biomater. 2009, 5, 2570. [Google Scholar] [CrossRef] [PubMed]
- Calamak, S.; Aksoy, E.A.; Ertas, N.; Erdogdu, C.; Sagıroglu, M.; Ulubayram, K. Ag/silk fibroin nanofibers: Effect of fibroin morphology on Ag+ release and antibacterial activity. Eur. Polym. J. 2015, 67, 99. [Google Scholar] [CrossRef]
- Wang, S.D.; Ma, Q.; Wang, K.; Chen, H.W. Improving Antibacterial Activity and Biocompatibility of Bioinspired Electrospinning Silk Fibroin Nanofibers Modified by Graphene Oxide. ACS Omega 2018, 3, 406. [Google Scholar] [CrossRef]
- Song, D.W.; Kim, S.H.; Kim, H.H.; Lee, K.H.; Ki, C.S.; Park, Y.H. Multi-biofunction of antimicrobial peptide-immobilized silk fibroin nanofiber membrane: Implications for wound healing. Acta Biomater. 2016, 39, 146. [Google Scholar] [CrossRef]
- Lin, L.; Liao, X.; Cui, H. Cold plasma treated thyme essential oil/silk fibroin nanofibers against Salmonella Typhimurium in poultry meat. Food Packag. Shelf Life 2019, 21, 100337. [Google Scholar] [CrossRef]
- Jeong, L.; Kim, M.H.; Jung, J.Y.; Min, B.M.; Park, W.H. Effect of silk fibroin nanofibers containing silver sulfadiazine on wound healing. Int. J. Nanomed. 2014, 9, 5277. [Google Scholar] [CrossRef] [PubMed][Green Version]
- Hadisi, Z.; Bakhsheshi-Rad, H.R.; Walsh, T.; Dehghan, M.M.; Farzad-Mohajeri, S.; Gholami, H.; Diyanoush, A.; Pagan, E.; Akbari, M. In vitro and in vivo evaluation of silk fibroin-hardystonite-gentamicin nanofibrous scaffold for tissue engineering applications. Polym. Test. 2020, 91, 106698. [Google Scholar] [CrossRef]
- Shahverdi, S.; Hajimiri, M.; Esfandiari, M.A.; Larijani, B.; Atyabi, F.; Rajabiani, A.; Dehpour, A.R.; Gharehaghaji, A.K.; Dinarvand, R. Fabrication and structure analysis of poly(lactide-co-glycolic acid)/silk fibroin hybrid scaffold for wound dressing applications. Int. J. Pharm. 2014, 473, 345. [Google Scholar] [CrossRef] [PubMed]
- Çalamak, S.; Erdoğdu, C.; Özalp, M.; Ulubayram, K. Silk fibroin based antibacterial bionanotextiles as wound dressing materials. Mater. Sci. Eng. C 2014, 43, 11. [Google Scholar] [CrossRef] [PubMed]
- Chong, C.; Wang, Y.; Fathi, A.; Parungao, R.; Maitz, P.K.; Li, Z. Skin wound repair: Results of a pre-clinical study to evaluate electropsun collagen–elastin–PCL scaffolds as dermal substitutes. Burns 2019, 45, 1639. [Google Scholar] [CrossRef]
- Vázquez, J.J.; Martínez, E.S. Collagen and elastin scaffold by electrospinning for skin tissue engineering applications. J. Mater. Res. 2019, 34, 2819. [Google Scholar] [CrossRef]
- Buttafoco, L.; Kolkman, N.G.; Engbers-Buijtenhuijs, P.; Poot, A.A.; Dijkstra, P.J.; Vermes, I.; Feijen, J. Electrospinning of collagen and elastin for tissue engineering applications. Biomaterials 2006, 27, 724. [Google Scholar] [CrossRef]
- Rnjak-Kovacina, J.; Wise, S.G.; Li, Z.; Maitz, P.K.; Young, C.J.; Wang, Y.; Weiss, A.S. Electrospun synthetic human elastin:collagen composite scaffolds for dermal tissue engineering. Acta Biomater. 2012, 8, 3714. [Google Scholar] [CrossRef]
- Cao, G.; Wang, C.; Fan, Y.; Li, X. Biomimetic SIS-based biocomposites with improved biodegradability, antibacterial activity and angiogenesis for abdominal wall repair. Mater. Sci. Eng. C 2020, 109, 110538. [Google Scholar] [CrossRef]
- Kim, J.H.; Lee, H.; Jatoi, A.W.; Im, S.S.; Lee, J.S.; Kim, I.S. Juniperus chinensis extracts loaded PVA nanofiber: Enhanced antibacterial activity. Mater. Lett. 2016, 181, 367. [Google Scholar] [CrossRef]
- Kang, Y.O.; Yoon, I.S.; Lee, S.Y.; Kim, D.D.; Lee, S.J.; Park, W.H.; Hudson, S.M. Chitosan-coated poly(vinyl alcohol) nanofibers for wound dressings. J. Biomed. Mater. Res. Part B 2010, 92, 568. [Google Scholar] [CrossRef]
- Nguyen, T.H.; Kim, Y.H.; Song, H.Y.; Lee, B.T. Nano Ag loaded PVA nano-fibrous mats for skin applications. J. Biomed. Mater. Res. Part B Appl. Biomater. 2011, 96, 225. [Google Scholar] [CrossRef] [PubMed]
- Jannesari, M.; Varshosaz, J.; Morshed, M.; Zamani, M. Composite poly(vinyl alcohol)/poly(vinyl acetate) electrospun nanofibrous mats as a novel wound dressing matrix for controlled release of drugs. Int. J. Nanomed. 2011, 6, 993. [Google Scholar]
- Taepaiboon, P.; Rungsardthong, U.; Supaphol, P. Drug-loaded electrospun mats of poly(vinyl alcohol) fibres and their release characteristics of four model drugs. Nanotechnology 2006, 17, 2317. [Google Scholar] [CrossRef]
- He, T.; Wang, J.N.; Huang, P.L.; Zeng, B.Z.; Li, H.H.; Cao, Q.Y.; Zhang, S.Y.; Luo, Z.; Deng, D.B.; Zhang, H.W.; et al. Electrospinning polyvinylidene fluoride fibrous membranes containing anti-bacterial drugs used as wound dressing. Colloids Surf. B 2015, 130, 278. [Google Scholar] [CrossRef] [PubMed]
- Khoshnevisan, K.; Maleki, H.; Samadian, H.; Shahsavari, S.; Sarrafzadeh, M.H.; Larijani, B.; Dorkoosh, F.A.; Haghpanah, V.; Khorramizadeh, M.R. Cellulose acetate electrospun nanofibers for drug delivery systems: Applications and recent advances. Carbohydr. Polym. 2018, 198, 131. [Google Scholar] [CrossRef] [PubMed]
- Lan, X.; Liu, Y.; Wang, Y.; Tian, F.; Miao, X.; Wang, H.; Tang, Y. Coaxial electrospun PVA/PCL nanofibers with dual release of tea polyphenols and ε-poly (L-lysine) as antioxidant and antibacterial wound dressing materials. Int. J. Pharm. 2021, 601, 120525. [Google Scholar] [CrossRef]
- Hu, X.; Wang, X.; Li, S.; Zhou, W.; Song, W. Antibacterial Electrospun Polyvinyl Alcohol Nanofibers Encapsulating Berberine-Hydroxypropyl-β-cyclodextrin inclusion complex. J. Drug Deliv. Sci. Technol. 2021, 64, 102649. [Google Scholar] [CrossRef]
- O’ Mahony, J.; O’ Donoghue, M.; Morgan, J.G.; Hill, C. Rotavirus survival and stability in foods as determined by an optimised plaque assay procedure. Int. J. Food Microbiol. 2000, 61, 177. [Google Scholar] [CrossRef]
- Moghbel, A.; Agheli, H.; Kalantari, E.; Naji, M. Design and formulation of tragacanth dressing bandage for burn healing with no dermal toxicity. Toxicol. Lett. 2008, 180, S154. [Google Scholar] [CrossRef]
- Ranjbar-Mohammadi, M.; Bahrami, S.H.; Joghataei, M.T. Fabrication of novel nanofiber scaffolds from gum tragacanth/poly(vinyl alcohol) for wound dressing application: In vitro evaluation and antibacterial properties. Mater. Sci. Eng. C 2013, 33, 4935. [Google Scholar] [CrossRef] [PubMed]
- Siahi, M.R.; Barzegar-Jalali, M.; Monajjemzadeh, F.; Ghaffari, F.; Azarmi, S. Design and evaluation of 1- and 3-layer matrices of verapamil hydrochloride for sustaining its release. AAPS Pharm. Sci. Tech. 2005, 6, E626. [Google Scholar]
- Rouse, J.G.; Van Dyke, M.E. A review of keratin-based biomaterials for biomedical applications. Materials 2010, 3, 999. [Google Scholar] [CrossRef]
- Park, M.; Shin, H.K.; Panthi, G.; Kim, H.J.; Lee, H.Y.; Kim, D.H.; Kim, H.J. Novel Preparation and Characterization of Human Hair-Based Nanofibers Using Electrospinning Process. Int. J. Biol. Macromol. 2015, 76, 45–50. [Google Scholar] [CrossRef]
- Gökmeşe, F.; Uslu, İ.; Aytimur, A. Preparation and characterization of PVA/PVP nanofibers as promising materials for wound dressing. Polym. Plast. Technol. Eng. 2013, 52, 1259. [Google Scholar] [CrossRef]
- McDonnell, G.; Russelll, D. Antiseptics and disinfectants: Activity, action, and resistance. Am. Soc. Microbiol. 1999, 12, 147. [Google Scholar] [CrossRef]
- Aytimur, A.; Uslu, İ. Promising materials for wound dressing: PVA/PAA/PVP electrospun nanofibers. Polym. Plast. Technol. Eng. 2014, 53, 655. [Google Scholar] [CrossRef]
- Aytimur, A.; Koçyiğit, S.; Uslu, İ. Synthesis and characterization of poly(vinyl alcohol)/poly(vinyl pyrrolidone)-iodine nanofibers with poloxamer 188 and chitosan. Polym. Plast. Technol. Eng. 2013, 52, 661. [Google Scholar] [CrossRef]
- Lee, R.C.; River, L.P.; Pan, F.S.; Ji, L.; Wollmann, R.L. Surfactantinduced sealing of electropermeabilized skeletal muscle membranes in vivo. Proc. Natl. Acad. Sci. USA 1992, 89, 4524. [Google Scholar] [CrossRef] [PubMed]
- Abdelaal, M.Y.; Makki, M.S.I.; Sobahi, T.R.A. Modification and characterization of polyacrylic acid for metal ion recovery. Am. J. Polym. Sci. 2012, 2, 73. [Google Scholar] [CrossRef]
- Pinto, M.C.C.; Gomes, F.W.; Melo, C.K.; Melo, P.A.; Castro, M.; Pinto, J.C. Production of poly(acrylic acid) particles dispersed in organic media. Macromol. Symp. 2012, 319, 15. [Google Scholar] [CrossRef]
- Mocanu, A.; Doroftei, F.; Popescu, A.; Butnaru, M.; Nistor, M.T.; Vasile, C. Optimization of Polyvinyl Alcohol-Based Electrospun Fibers with Polyethylene Oxide and Gelatin for Biomedical Applications. Fibers 2023, 11, 85. [Google Scholar] [CrossRef]
- Ko, Y.M.; Choi, D.Y.; Jung, S.C.; Kim, B.H. Electrospinning of Poly(vinyl alcohol) Nanofibers Containing Silver Nanoparticles for Use as a Wound Dressing. J. Nanosci. Nanotechnol. 2015, 15, 192–198. [Google Scholar]
- Quirós, J.; Boltes, K.; Rosal, R. Bioactive Applications for Electrospun Fibers. Polym. Rev. 2016, 56, 631. [Google Scholar] [CrossRef]
- Mochane, M.J.; Motsoeneng, T.S.; Sadiku, E.R.; Mokhena, T.C.; Sefadi, J.S. Morphology and Properties of Electrospun PCL and Its Composites for Medical Applications: A Mini Review. Appl. Sci. 2019, 9, 2205. [Google Scholar] [CrossRef]
- Miguel, P.S.; Ribeiro, M.P.; Coutinho, P.; Correia, I.J. Electrospun polycaprolactone/aloe vera_chitosan nanofibrous asymmetric membranes aimed for wound healing applications. Polymers 2017, 9, 183. [Google Scholar] [CrossRef]
- Lee, K.H.; Kim, H.Y.; Khil, M.S.; Ra, Y.M.; Lee, D.R. Characterization of Nanostructured Poly(ε-caprolactone) Nonwoven Mats via Electrospinning. Polymer 2003, 44, 1208. [Google Scholar] [CrossRef]
- Moghe, A.K.; Hufenus, R.; Hudson, S.M.; Gupta, B.S. Effect of the addition of a fugitive salt on electrospinnability of poly (ɛ-caprolactone). Polymer 2009, 50, 3311. [Google Scholar] [CrossRef]
- Prabhakaran, M.P.; Venugopal, J.; Chan, C.K.; Ramakrishna, S. Surface modified electrospun nanofibrous scaffolds for nerve tissue engineering. Nanotechnology 2008, 19, 1725. [Google Scholar] [CrossRef]
- Mohamed, R.M.; Yusoh, K. A Review on the Recent Research of Polycaprolactone (PCL). Adv. Mater. Res. 2016, 1134, 249. [Google Scholar]
- Li, Z.; Tan, B.H. Towards the development of polycaprolactone based amphiphilic block copolymers: Molecular design, self-assembly and biomedical applications. Mater. Sci. Eng. C 2014, 45, 620. [Google Scholar] [CrossRef]
- Jin, G.; Prabhakaran, M.P.; Kai, D.; Annamalai, S.K.; Arunachalam, K.D.; Ramakrishna, S. Tissue engineered plant extracts as nanofibrous wound dressing. Biomaterials 2013, 34, 724. [Google Scholar] [CrossRef] [PubMed]
- Garcia-Orue, I.; Gainza, G.; Garcia-Garcia, P.; Gutierrez, F.B.; Aguirre, J.J.; Hernandez, R.M.; Delgado, A.; Igartua, M. Composite nanofibrous membranes of PLGA/Aloe vera containing lipid nanoparticles for wound dressing applications. Int. J. Pharm. 2019, 556, 320. [Google Scholar] [CrossRef] [PubMed]
- Said, S.S.; El-Halfawy, O.M.; El-Gowelli, H.M.; Aloufy, A.K.; Boraei, N.A.; El-Khordagui, L.K. Bioburden-responsive antimicrobial PLGA ultrafine fibers for wound healing. Eur. J. Pharm. Biopharm. 2012, 80, 85. [Google Scholar] [CrossRef] [PubMed]
- Said, S.S.; Aloufy, A.K.; El-Halfawy, O.M.; Boraei, N.A.; ElKhordagui, L.K. Antimicrobial PLGA ultrafine fibers: Interaction with wound bacteria. Eur. J. Pharm. Biopharm. 2011, 79, 108. [Google Scholar] [CrossRef]
- Haider, A.; Kwak, S.; Gupta, K.C.; Kang, I.K. Preparation and Characterization of Electrospun Polyvinyl Alcohol Nanofibers Containing Silver Nanoparticles for Antibacterial Wound Dressing. J. Nanomater. 2015, 2015, 1. [Google Scholar]
- Khalil, K.A.; Fouad, H.; Elsarnagawy, T.; Almajhdi, F.N. Preparation and Characterization of Electrospun PLGA/silver Composite Nanofibers for Biomedical Applications. Int. J. Electrochem. Sci. 2013, 8, 3483. [Google Scholar] [CrossRef]
- Yang, S.; Han, X.; Jia, Y.; Zhang, H.; Tang, T. Hydroxypropyltrimethyl Ammonium Chloride Chitosan Functionalized-PLGA Electrospun Fibrous Membranes as Antibacterial Wound Dressing: In Vitro and In Vivo Evaluation. Polymers 2017, 9, 697. [Google Scholar] [CrossRef]
- Soscia, D.A.; Raof, N.A.; Xie, Y.; Cady, N.C.; Gadre, A.P. Antibiotic-Loaded PLGA Nanofibers for Wound Healing Applications. Adv. Eng. Mater. 2010, 12, B83. [Google Scholar] [CrossRef]
- Ali, S.H.; Mahammed, M.A.; Yasin, S.A. Characterization of Electrospinning Chitosan Nanofibers Used for Wound Dressing. Polymers 2024, 16, 1984. [Google Scholar] [CrossRef]
- Ko, E.K.; Jeong, S.I.; Rim, N.G.; Lee, Y.M.; Shin, H.; Lee, B.K. In Vitro Osteogenic Differentiation of Human Mesenchymal Stem Cells and In Vivo Bone Formation in Composite Nanofiber Meshes. Tissue Eng. Part A 2008, 14, 2105. [Google Scholar] [CrossRef] [PubMed]
- Rajabifar, N.; Rostami, A.; Afshar, S.; Mosallanezhad, P.; Zarrintaj, P.; Shahrousvand, M.; Nazockdast, H. Wound Dressing with Electrospun Core-Shell Nanofibers: From Material Selection to Synthesis. Polymers 2024, 16, 2526. [Google Scholar] [CrossRef]
- Spasova, M.; Manolova, N.; Paneva, D.; Mincheva, R.; Dubois, P.; Rashkov, I.; Maximova, V.; Danchev, D. Polylactide Stereocomplex-Based Electrospun Materials Possessing Surface with Antibacterial and Hemostatic Properties. Biomacromolecules 2010, 11, 151. [Google Scholar] [CrossRef] [PubMed]
- Nguyen, T.T.; Ghosh, C.; Hwang, S.G.; Tran, L.D.; Park, J.S. Characteristics of curcumin-loaded poly (lactic acid) nanofibers for wound healing. J. Mater. Sci. 2013, 48, 7125. [Google Scholar] [CrossRef]
- Fang, Y.; Zhu, X.; Wang, N.; Zhang, X.; Yang, D.; Nie, J.; Ma, G. Biodegradable core-shell electrospun nanofibers based on PLA and γ-PGA for wound healing. Eur. Polym. J. 2019, 116, 30. [Google Scholar] [CrossRef]
- Hajikhani, M.; Emam-Djomeh, Z.; Askari, G. Fabrication and characterization of mucoadhesive bioplastic patch via coaxial polylactic acid (PLA) based electrospun nanofibers with antimicrobial and wound healing application. Int. J. Biol. Macromol. 2021, 172, 143. [Google Scholar] [CrossRef] [PubMed]
- Karami, Z.; Rezaeian, I.; Zahedi, P.; Abdollahi, M. Preparation and performance evaluations of electrospun poly(ε-caprolactone), poly(lactic acid), and their hybrid (50/50) nanofibrous mats containing thymol as an herbal drug for effective wound healing. J. Appl. Polym. Sci. 2013, 129, 756. [Google Scholar] [CrossRef]
- Avci, H.; Gergeroglu, H. Synergistic effects of plant extracts and polymers on structural and antibacterial properties for wound healing. Polym. Bull. 2019, 76, 3709. [Google Scholar] [CrossRef]
- Malafatti, J.O.; Bernardo, M.P.; Moreira, F.K.; Ciol, H.; Inada, N.M.; Mattoso, L.H.; Paris, E.C. Electrospun poly(lactic acid) nanofibers loaded with silver sulfadiazine/[Mg–Al]-layered double hydroxide as an antimicrobial wound dressing. Polym. Adv. Technol. 2020, 31, 1377. [Google Scholar] [CrossRef]
- Zhao, R.; Li, X.; Sun, B.; Tong, Y.; Jiang, Z.; Wang, C. Nitrofurazone-loaded electrospun PLLA/sericin-based dual-layer fiber mats for wound dressing applications. RSC Adv. 2015, 5, 16940. [Google Scholar] [CrossRef]
- Feng, K.; Sun, H.; Bradley, M.A.; Dupler, E.J.; Giannobile, W.V.; Ma, P.X. Novel antibacterial nanofibrous PLLA scaffolds. J. Control. Release 2010, 146, 363. [Google Scholar] [CrossRef] [PubMed]
- Zeng, J.; Yang, L.; Liang, Q.; Zhang, X.; Guan, H.; Xu, X.; Chen, X.; Jing, X. Influence of the drug compatibility with polymer solution on the release kinetics of electrospun fiber formulation. J. Control. Release 2005, 105, 43. [Google Scholar] [CrossRef] [PubMed]
- Chen, J.; Zhou, B.; Li, Q.; Ouyang, J.; Kong, J.; Zhong, W.; Xing, M.M. PLLA-PEG-TCH-labeled bioactive molecule nanofibers for tissue engineering. Int. J. Nanomed. 2011, 6, 2533. [Google Scholar][Green Version]
- Parwe, S.P.; Chaudhari, P.N.; Mohite, K.K.; Selukar, B.S.; Nande, S.S.; Garnaik, B. Synthesis of ciprofloxacin-conjugated poly (L-lactic acid) polymer for nanofiber fabrication and antibacterial evaluation. Int. J. Nanomed. 2014, 9, 1463. [Google Scholar]
- Pagnotta, G.; Graziani, G.; Baldini, N.; Maso, A.; Focarete, M.L.; Berni, M.; Biscarini, F.; Bianchi, M.; Gualandi, C. Nanodecoration of electrospun polymeric fibers with nanostructured silver coatings by ionized jet deposition for antibacterial tissues. Mater. Sci. Eng. C 2020, 113, 110998. [Google Scholar] [CrossRef] [PubMed]
- Pencheva, V.; Margaritova, E.; Borinarova, M.; Slavkova, M.; Momekova, D.; Petrov, P.D. A novel approach for fabricating nanocomposite materials by embedding stabilized core-shell micelles into polysaccharide cryogel matrix. Carbohydr. Polym. 2018, 183, 165. [Google Scholar] [CrossRef] [PubMed]
- Kuang, G.; Zhang, Z.; Liu, S.; Zhou, D.; Lu, X.; Jing, X.; Huang, Y. Biphasic Drug Release from Electrospun Polyblend Nanofibers for Optimized Local Cancer Treatment. Biomater. Sci. 2018, 6, 324–332. [Google Scholar] [CrossRef] [PubMed]
- Asim, S.; Wasim, M.; Sabir, A.; Shafiq, M.; Andlib, H.; Khuram, S.; Ahmad, A.; Jamil, T. The Effect of Nanocrystalline Cellulose/Gum Arabic Conjugates in Crosslinked Membrane for Antibacterial, Chlorine Resistance and Boron Removal Performance. J. Hazard. Mater. 2018, 343, 68–80. [Google Scholar] [CrossRef] [PubMed]
- Tan, J.; Mcclung, W.G.; Brash, J.L. Nonfouling biomaterials based on polyethylene oxide-containing amphiphilic triblock copolymers as surface modifying additives: Protein adsorption on peo-copolymer/polyurethane blends. J. Biomed. Mater. Res. Part A 2008, 85A, 873. [Google Scholar] [CrossRef]
- Yoo, H.J.; Kim, H.D. Properties of crosslinked blends of pellethene and multiblock polyurethane containing poly(ethylene oxide) for biomaterials. J. Appl. Polym. Sci. 2004, 91, 2348. [Google Scholar] [CrossRef]
- Celebioglu, A.; Uyar, T. Cyclodextrin short-nanofibers using sacrificial electrospun polymeric matrix for voc removal. J. Incl. Phenom. Macrocycl. Chem. 2018, 90, 135. [Google Scholar] [CrossRef]
- Gong, T.; Liu, T.; Zhang, L.; Ye, W.; Guo, X.; Wang, L.; Zhou, S. Design of Redox-Sensitive Drug-Loaded Nanofibers for Bone Reconstruction. ACS Biomater. Sci. Eng. 2018, 4, 240–249. [Google Scholar] [CrossRef] [PubMed]
- Zhao, P.; Soin, N.; Prashanthi, K.; Chen, J.; Dong, S.; Zhou, E.; Zhu, Z.; Narasimulu, A.A.; Montemagno, C.D.; Yu, L.; et al. Emulsion Electrospinning of Polytetrafluoroethylene (PTFE) Nanofibrous Membranes for High-Performance Triboelectric Nanogenerators. ACS Appl. Mater. Interfaces 2018, 10, 5880–5891. [Google Scholar] [CrossRef] [PubMed]
- Song, Z.; Chiang, S.W.; Chu, X.; Du, H.; Li, J.; Gan, L.; Zhang, X.; Kang, F. Effects of Solvent on Structures and Properties of Electrospun Poly(ethylene oxide) Nanofibers. J. Appl. Polym. Sci. 2018, 135, 45787. [Google Scholar] [CrossRef]
- Yoshioka, T.; Kawahara, Y.; Schaper, A.K. Cyclic or permanent? Structure control of the contraction behavior of regenerated bombyx mori silk nanofibers. Macromolecules 2011, 44, 7713. [Google Scholar] [CrossRef]
- Augustine, R.; Dominic, E.A.; Reju, I.; Kaimal, B.; Kalarikkal, N.; Thomas, S. Electrospun poly(ε-caprolactone)-based skin substitutes: In vivo evaluation of wound healing and the mechanism of cell proliferation. J. Biomed. Mater. Res.-Part B Appl. Biomater. 2015, 103, 1445. [Google Scholar] [CrossRef]
- Ishii, D.; Ying, T.H.; Mahara, A.; Murakami, S.; Yamaoka, T.; Lee, W.K.; Iwata, T. In vivo tissue response and degradation behavior of PLLA and stereocomplexed PLA nanofibers. Biomacromolecules 2009, 10, 237. [Google Scholar] [CrossRef]
- Yeo, I.S.; Oh, J.E.; Jeong, L.; Lee, T.S.; Lee, S.J.; Park, W.H.; Min, B.M. Collagen-based biomimetic nanofibrous scaffolds: Preparation and characterization of collagen/silk fibroin bicomponent nanofibrous structures. Biomacromolecules 2008, 9, 1106. [Google Scholar] [CrossRef]
- Datta, S.; Rameshbabu, A.P.; Bankoti, K.; Maity, P.P.; Das, D.; Pal, S.; Roy, S.; Sen, R.; Dhara, S. Oleoyl-chitosan-based nanofiber mats impregnated with amniotic membrane derived stem cells for accelerated full-thickness excisional wound healing. ACS Biomater. Sci. Eng. 2017, 3, 1738. [Google Scholar] [CrossRef]
- Dongargaonkar, A.A.; Bowlin, G.L.; Yang, H. Electrospun blends of gelatin and gelatin-dendrimer conjugates as a wound-dressing and drug-delivery platform. Biomacromolecules 2013, 14, 4038. [Google Scholar] [CrossRef]
- Pakravan, M.; Heuzey, M.C.; Ajji, A. A fundamental study of chitosan/PEO electrospinning. Polymer 2011, 52, 4813. [Google Scholar] [CrossRef]
- Zhang, K.; Bai, X.; Yuan, Z.; Cao, X.; Jiao, X.; Li, Y.; Qin, Y.; Wen, Y.; Zhang, X. Layered nanofiber sponge with an improved capacity for promoting blood coagulation and wound healing. Biomaterials 2019, 204, 70. [Google Scholar] [CrossRef]
- Zhou, Y.; Yang, D.; Chen, X.; Xu, Q.; Lu, F.; Nie, J. Electrospun water-soluble carboxyethyl chitosan/poly(vinyl alcohol) nanofibrous membrane as potential wound dressing for skin regeneration. Biomacromolecules 2008, 9, 349. [Google Scholar] [CrossRef]
- Ignatova, M.; Manolova, N.; Markova, N.; Rashkov, I. Electrospun non-woven nanofibrous hybrid mats based on chitosan and PLA for wound-dressing applications. Macromol. Biosci. 2009, 9, 102. [Google Scholar] [CrossRef]
- Asran, A.S.; Razghandi, K.; Aggarwal, N.; Michler, G.H.; Groth, T. Nanofibers from blends of polyvinyl alcohol and polyhydroxy butyrate as potential scaffold material for tissue engineering of skin. Biomacromolecules 2010, 11, 3413. [Google Scholar] [CrossRef]
- Aytimur, A.; Koçyiʇit, S.; Uslu, I.; Gökmeşe, F. Preparation and characterization of polyvinyl alcohol based copolymers as wound dressing fibers. Int. J. Polym. Mater. Polym. Biomater. 2015, 64, 111. [Google Scholar] [CrossRef]
- Park, K.E.; Kang, H.K.; Lee, S.J.; Min, B.-M.; Park, W.H. Biomimetic nanofibrous scaffolds: Preparation and characterization of PGA/Chitin blend nanofibers. Biomacromolecules 2006, 7, 635. [Google Scholar] [CrossRef]
- Fan, L.; Wang, H.; Zhang, K.; Cai, Z.; He, C.; Sheng, X.; Mo, X. Vitamin C-reinforcing silk fibroin nanofibrous matrices for skin care application. RSC Adv. 2012, 2, 4110. [Google Scholar] [CrossRef]
- Selvaraj, S.; Fathima, N.N. Fenugreek incorporated silk fibroin nanofibers—A potential antioxidant scaffold for enhanced wound healing. ACS Appl. Mater. Interfaces 2017, 9, 5916. [Google Scholar] [CrossRef]
- Li, H.; Wang, M.; Williams, G.R.; Wu, J.; Sun, X.; Lv, Y.; Zhu, L.M. Electrospun gelatin nanofibers loaded with vitamins A and e as antibacterial wound dressing materials. RSC Adv. 2016, 6, 50267. [Google Scholar] [CrossRef]
- Chhabra, H.; Deshpande, R.; Kanitkar, M.; Jaiswal, A.; Kale, V.P.; Bellare, J.R. A nano zinc oxide doped electrospun scaffold improves wound healing in a rodent model. RSC Adv. 2016, 6, 1428. [Google Scholar] [CrossRef]
- Xi, Y.; Dong, H.; Sun, K.; Liu, H.; Liu, R.; Qin, Y.; Hu, Z.; Zhao, Y.; Nie, F.; Wang, S. Scabinspired cytophilic membrane of anisotropic nanofibers for rapid wound healing. ACS Appl. Mater. Interfaces 2013, 5, 4821. [Google Scholar] [CrossRef] [PubMed]
- Sadri, M.; Arab-Sorkhi, S.; Vatani, H.; Bagheri-Pebdeni, A. New wound dressing polymeric nanofiber containing green tea extract prepared by electrospinning method. Fibers Polym. 2015, 16, 1742. [Google Scholar] [CrossRef]
- Annur, D.; Wang, Z.K.; Der Liao, J.; Kuo, C. Plasma-synthesized silver nanoparticles on electrospun chitosan nanofiber surfaces for antibacterial applications. Biomacromolecules 2015, 16, 3248. [Google Scholar] [CrossRef] [PubMed]
- Charernsriwilaiwat, N.; Rojanarata, T.; Ngawhirunpat, T.; Sukma, M.; Opanasopit, P. Electrospun chitosan-based nanofiber mats loaded with Garcinia mangostana extracts. Int. J. Pharm. 2013, 452, 333. [Google Scholar] [CrossRef]
- Shoba, E.; Lakra, R.; Kiran, M.S.; Korrapati, P.S. Design and development of papainurea loaded PVA nanofibers for wound debridement. RSC Adv. 2014, 4, 60209. [Google Scholar] [CrossRef]
- Kataria, K.; Gupta, A.; Rath, G.; Mathur, R.B.; Dhakate, S.R. In vivo wound healing performance of drug loaded electrospun composite nanofibers transdermal patch. Int. J. Pharm. 2014, 469, 102. [Google Scholar] [CrossRef]
- Lu, B.; Li, T.; Zhao, H.; Li, X.; Gao, C.; Zhang, S.; Xie, E. Graphene-based composite materials beneficial to wound healing. Nanoscale 2012, 4, 2978. [Google Scholar] [CrossRef]
- Shalumon, K.T.; Anulekha, K.H.; Nair, S.V.; Nair, S.V.; Chennazhi, K.P.; Jayakumar, R. Sodium alginate/poly(vinyl alcohol)/nano ZnO composite nanofibers for antibacterial wound dressings. Int. J. Biol. Macromol. 2011, 49, 247. [Google Scholar] [CrossRef]
- Pal, P.; Das, B.; Dadhich, P.; Achar, A.; Dhara, S. Carbon nanodot impregnated fluorescent nanofibers for: In vivo monitoring and accelerating full-thickness wound healing. J. Mater. Chem. B. 2017, 5, 6645. [Google Scholar] [CrossRef]
- Augustine, R.; Nethi, S.K.; Kalarikkal, N.; Thomas, S.; Patra, C.R. Electrospun polycaprolactone (PCL) scaffolds embedded with europium hydroxide nanorods (EHNs) with enhanced vascularization and cell proliferation for tissue engineering applications. J. Mater. Chem. B 2017, 5, 4660. [Google Scholar] [CrossRef]
- Augustine, R.; Dominic, E.A.; Reju, I.; Kaimal, B.; Kalarikkal, N.; Thomas, S. Electrospun polycaprolactone membranes incorporated with ZnO nanoparticles as skin substitutes with enhanced fibroblast proliferation and wound healing. RSC Adv. 2014, 4, 24777. [Google Scholar] [CrossRef]
- Loiola, L.M.D.; Tornello, P.R.C.; Abraham, G.A.; Felisberti, M.I. Amphiphilic electrospun scaffolds of PLLA-PEO-PPO block copolymers: Preparation, characterization and drug-release behaviour. RSC Adv. 2017, 7, 161. [Google Scholar] [CrossRef]
- Wang, Y.; Li, P.; Xiang, P.; Lu, J.; Yuan, J.; Shen, J. Electrospun polyurethane/keratin/AgNP biocomposite mats for biocompatible and antibacterial wound dressings. J. Mater. Chem. B 2016, 4, 635. [Google Scholar] [CrossRef] [PubMed]
- Ahmed, J.; Matharu, R.K.; Shams, T.; Illangakoon, U.E.; Edirisinghe, M. A comparison of electric-field-driven and pressure-driven fiber generation methods for drug delivery. Macromol. Mater. Eng. 2018, 303, 1700577. [Google Scholar] [CrossRef]
- Mohammadi, M.R.; Rabbani, S.; Bahrami, S.H.; Joghataei, M.T.; Moayer, F. Antibacterial performance and in vivo diabetic wound healing of curcumin loaded gum tragacanth/poly(ε-caprolactone) electrospun nanofibers. Mater. Sci. Eng. C 2016, 69, 1183. [Google Scholar] [CrossRef]
- Peh, P.; Lim, N.S.J.; Blocki, A.; Chee, S.M.L.; Park, H.C.; Liao, S.; Chan, C.; Raghunath, M. Simultaneous delivery of highly diverse bioactive compounds from blend electrospun fibers for skin wound healing. Bioconjug. Chem. 2015, 26, 1348. [Google Scholar] [CrossRef]
- Mira, A.; Mateo, C.R.; Mallavia, R.; Falco, A. Poly(methyl vinyl ether-alt-maleic acid) and ethyl monoester as building polymers for drug-loadable electrospun nanofibers. Sci. Rep. 2017, 7, 17205. [Google Scholar] [CrossRef]
- Zhao, P.; Jiang, H.; Pan, H.; Zhu, K.; Chen, W. Biodegradable fibrous scaffolds composed of gelatin coated poly(caprolactone) prepared by coaxial electrospinning. J. Biomed. Mater. Res.—Part A 2007, 83, 372. [Google Scholar]
- Padmavathy, V.; Vasudevan, P.; Dhingra, S.C. Thermal and spectroscopic studies on sorption of nickel(II) ion on protonated baker’s yeast. Chemosphere 2003, 52, 1807. [Google Scholar] [CrossRef]
- Nguyen, T.T.T.; Chung, O.H.; Park, J.S. Coaxial electrospun poly(lactic acid)/chitosan (core/shell) composite nanofibers and their antibacterial activity. Carbohydr. Polym. 2011, 86, 1799. [Google Scholar] [CrossRef]
- Pakravan, M.; Heuzey, M.C.; Ajji, A. Core-shell structured PEO-chitosan nanofibers by coaxial electrospinning. Biomacromolecules 2012, 13, 412. [Google Scholar] [CrossRef]
- Zhang, J.F.; Yang, D.Z.; Xu, F.; Zhang, Z.P.; Yin, R.X.; Nie, J. Electrospun core-shell structure nanofibers from homogeneous solution of poly(ethylene oxide)/chitosan. Macromolecules 2009, 42, 5278. [Google Scholar] [CrossRef]
- Rubert, M.; Dehli, J.; Li, Y.F.; Taskin, M.B.; Xu, R.; Besenbacher, F.; Chen, M. Electrospun PCL/PEO coaxial fibers for basic fibroblast growth factor delivery. J. Mater. Chem. B 2014, 2, 8538. [Google Scholar] [CrossRef] [PubMed]
- Zhang, Y.Z.; Wang, X.; Feng, Y.; Li, J.; Lim, C.T.; Ramakrishna, S. Coaxial electrospinning of (fluorescein isothiocyanate-conjugated bovine serum albumin)-encapsulated poly(ε-caprolactone) nanofibers for sustained release. Biomacromolecules 2006, 7, 1049. [Google Scholar] [CrossRef]
- Jiang, H.; Hu, Y.; Li, Y.; Zhao, P.; Zhu, K.; Chen, W. A facile technique to prepare biodegradable coaxial electrospun nanofibers for controlled release of bioactive agents. J. Control. Release 2005, 108, 237. [Google Scholar] [CrossRef]
- Gao, W.; Sun, L.; Fu, X.; Lin, Z.; Xie, W.; Zhang, W.; Zhao, F.; Chen, X. Enhanced diabetic wound healing by electrospun core-sheath fibers loaded with dimethyloxalylglycine. J. Mater. Chem. B 2018, 6, 277. [Google Scholar] [CrossRef]
- He, M.; Jiang, H.; Wang, R.; Xie, Y.; Zhao, C. Fabrication of metronidazole loaded poly (ε-caprolactone)/zein core/shell nanofiber membranes via coaxial electrospinning for guided tissue regeneration. J. Colloid Interface Sci. 2017, 490, 270. [Google Scholar] [CrossRef]
- Najafi-Taher, R.; Derakhshan, M.A.; Faridi-Majidi, R.; Amani, A. Preparation of an ascorbic acid/PVA-chitosan electrospun mat: A core/shell transdermal delivery system. RSC Adv. 2015, 5, 50462. [Google Scholar] [CrossRef]
- Zupančič, Š.; Sinha-Ray, S.; Sinha-Ray, S.; Kristl, J.; Yarin, A.L. Controlled release of ciprofloxacin from core-shell nanofibers with monolithic or blended core. Mol. Pharm. 2016, 13, 1393. [Google Scholar] [CrossRef] [PubMed]
- Zhu, L.; Liu, X.; Du, L.; Jin, Y. Preparation of asiaticoside-loaded coaxially electrospinning nanofibers and their effect on deep partial-thickness burn injury. Biomed. Pharmacother. 2016, 83, 33. [Google Scholar] [CrossRef]
- Li, H.; Zhu, J.; Chen, S.; Jia, L.; Ma, Y. Fabrication of aqueous-based dual drug loaded silk fibroin electrospun nanofibers embedded with curcumin-loaded RSF nanospheres for drugs controlled release. RSC Adv. 2017, 7, 56550. [Google Scholar] [CrossRef]
- Ranjbar-Mohammadi, M.; Zamani, M.; Prabhakaran, M.P.; Bahrami, S.H.; Ramakrishna, S. Electrospinning of PLGA/gum tragacanth nanofibers containing tetracycline hydrochloride for periodontal regeneration. Mater. Sci. Eng. C 2016, 58, 521. [Google Scholar] [CrossRef] [PubMed]
- Yang, C.; Yu, D.G.; Pan, D.; Liu, X.K.; Wang, X.; Bligh, S.W.A.; Williams, G.R. Electrospun pH-sensitive core-shell polymer nanocomposites fabricated using a triaxial process. Acta Biomater. 2016, 35, 77. [Google Scholar] [CrossRef] [PubMed]
- Liu, W.; Ni, C.; Chase, D.B.; Rabolt, J.F. Preparation of multilayer biodegradable nanofibers by triaxial electrospinning. ACS Macro Lett. 2013, 2, 466. [Google Scholar] [CrossRef]
- Han, D.; Sherman, S.; Filocamo, S.; Steckl, A.J. Long-term antimicrobial effect of nisin released from electrospun triaxial fiber membranes. Acta Biomater. 2017, 53, 242. [Google Scholar] [CrossRef]
- Khalf, A.; Madihally, S.V. Modeling the permeability of multiaxial electrospun poly (ε-caprolactone)-gelatin hybrid fibers for controlled doxycycline release. Mater. Sci. Eng. C 2017, 76, 161. [Google Scholar] [CrossRef]
- Sofi, H.S.; Ashraf, R.; Khan, A.H.; Beigh, M.A.; Majeed, S.; Sheikh, F.A. Reconstructing nanofibers from natural polymers using surface functionalization approaches for applications in tissue engineering, drug delivery and biosensing devices. Mater. Sci. Eng. C 2019, 94, 1102. [Google Scholar] [CrossRef]
- Gould, L.J. Topical Collagen-Based Biomaterials for Chronic Wounds: Rationale and Clinical Application. Adv. Wound Care 2016, 5, 19. [Google Scholar] [CrossRef] [PubMed]
- Rahimi, M.; Noruzi, E.B.; Sheykhsaran, E.; Ebadi, B.; Kariminezhad, Z.; Molaparast, M.; Mehrabani, M.G.; Mehramouz, B.; Yousefi, M.; Ahmadi, R.; et al. Carbohydrate polymer-based silver nanocomposites: Recent progress in the antimicrobial wound dressings. Carbohydr. Polym. 2020, 231, 115696. [Google Scholar] [CrossRef]
- Opasanon, S.; Muangman, P.; Namviriyachote, N. Clinical effectiveness of alginate silver dressing in outpatient management of partial-thickness burns. Int. Wound J. 2010, 7, 467. [Google Scholar] [CrossRef] [PubMed]
- Kumar, S.S.; Rajendran, N.K.; Houreld, N.N.; Abrahamse, H. Recent advances on silver nanoparticle and biopolymer-based biomaterials for wound healing applications. Int. J. Biol. Macromol. 2018, 115, 165. [Google Scholar] [CrossRef] [PubMed]
- Miguel, S.P.; Figueira, D.R.; Simões, D.; Ribeiro, M.P.; Coutinho, P.; Ferreira, P.; Correia, I.J. Electrospun polymeric nanofibres as wound dressings: A review. Colloids Surf. B 2018, 169, 60. [Google Scholar] [CrossRef] [PubMed]
- Rodríguez-Tobías, H.; Morales, G.; Grande, D. Comprehensive review on electrospinning techniques as versatile approaches toward antimicrobial biopolymeric composite fibers. Mater. Sci. Eng. C 2019, 101, 306. [Google Scholar] [CrossRef] [PubMed]
- Ignatova, M.; Rashkov, I.; Manolova, N. Drug-loaded electrospun materials in wound-dressing applications and in local cancer treatment. Expert. Opin. Drug Deliv. 2013, 10, 469. [Google Scholar] [CrossRef] [PubMed]
- Alamgir, A.N.M. Therapeutic Use of Medicinal Plants and Their Extracts: Volume 1. Progress in Drug Research; Springer: Cham, Switzerland, 2017; Volume 73. [Google Scholar]
- Kazi, G.A.; Yamamoto, O. Effectiveness of the sodium alginate as surgical sealant materials. Wound Med. 2019, 24, 18. [Google Scholar] [CrossRef]
- Zhou, Q.; Kang, H.; Bielec, M.; Wu, X.; Cheng, Q.; Wei, W.; Dai, H. Influence of different divalent ions cross-linking sodium alginate-polyacrylamide hydrogels on antibacterial properties and wound healing. Carbohydr. Polym. 2018, 197, 292. [Google Scholar] [CrossRef]
- Kara, M.; Kondiah, P.P.; Marimuthu, T.; Choonara, Y.E. Advances in carbohydrate-based polymers for the design of suture materials: A review. Carbohydr. Polym. 2021, 261, 117860. [Google Scholar] [CrossRef]
- Chaturvedi, T.P.; Srivastava, R.; Srivastava, A.K.; Gupta, V.; Verma, P.K. Doxycycline Poly E-Caprolactone Nanofibers in Patients with Chronic Periodontitis—A Clinical Evaluation. J. Clin. Diagn. Res. 2013, 7, 2339. [Google Scholar] [CrossRef]
- Chaturvedi, T.P.; Srivastava, R.; Srivastava, A.K.; Gupta, V.; Verma, P.K. Evaluation of metronidazole nanofibers in patients with chronic periodontitis: A clinical study. Int. J. Pharm. Investig. 2012, 2, 213. [Google Scholar] [CrossRef]
- Thakkar, S.; Misra, M. Electrospun polymeric nanofibers: New horizons in drug delivery. Eur. J. Pharm. Sci. 2017, 107, 148. [Google Scholar] [CrossRef] [PubMed]
- MacEwan, M.R. Biomedical Patches with Spatially Arranged Fibers. U.S. Patent US10682444B2, 12 May 2020. [Google Scholar]
- Kamsani, N.H.; Haris, M.S.; Pandey, M.; Taher, M.; Rullah, K. Biomedical application of responsive ‘smart’ electrospun nanofibers in drug delivery system: A minireview. Arab. J. Chem. 2021, 14, 103199. [Google Scholar] [CrossRef]
- Purewal, S.S.; Kaur, A.; Bangar, S.P.; Singh, P.; Singh, H. Protein-Based Films and Coatings: An Innovative Approach. Coatings 2024, 14, 32. [Google Scholar] [CrossRef]
- Narayanan, K.B.; Bhaskar, R.; Sudhakar, K.; Nam, D.H.; Han, S.S. Polydopamine-Functionalized Bacterial Cellulose as Hydrogel Scaffolds for Skin Tissue Engineering. Gels 2023, 9, 656. [Google Scholar] [CrossRef]
- Noralian, Z.; Gashti, M.P.; Moghaddam, M.R.; Tayyeb, H.; Erfanian, I. Ultrasonically developed silver/iota-carrageenan/cotton bionanocomposite as an efficient material for biomedical applications. Int. J. Biol. Macromol. 2021, 180, 439–457. [Google Scholar] [CrossRef] [PubMed]
- Gashti, M.P.; Stir, M.; Hulliger, J. Growth of strontium hydrogen phosphate/gelatin composites: A biomimetic approach. New J. Chem. 2016, 40, 5495–5500. [Google Scholar] [CrossRef]
- Mozaffari, A.; Gashti, M.P. Air plasma functionalization of electrospun nanofibers for skin tissue engineering. Biomedicines 2022, 10, 617. [Google Scholar] [CrossRef] [PubMed]
- Nguyen, H.M.; Le, T.T.N.; Nguyen, A.T.; Le, H.N.T.; Pham, T.T. Biomedical materials for wound dressing: Recent advances and applications. RSC Adv. 2023, 13, 5509–5528. [Google Scholar] [CrossRef]
- Silva, A.B.; Rufato, K.B.; de Oliveira, A.C.; Souza, P.R.; da Silva, E.P.; Muniz, E.C.; Vilsinki, B.H.; Martins, A.F. Composite materials based on chitosan/gold nanoparticles: From synthesis to biomedical applications. Int. J. Biol. Macromol. 2020, 161, 977–998. [Google Scholar] [CrossRef]
- Tamer, T.M.; Sabet, M.M.; Omer, A.M.; Abbas, E.; Eid, A.I.; Mohy-Eldin, M.S.; Hassan, M.A. Hemostatic and antibacterial PVA/Kaolin composite sponges loaded with penicillin–streptomycin for wound dressing applications. Sci. Rep. 2021, 11, 3428. [Google Scholar] [CrossRef] [PubMed]
- Zhou, N.; Zan, X.; Wang, Z.; Wu, H.; Yin, D.; Liao, C.; Wan, Y. Galactosylated chitosan–polycaprolactone nanoparticles for hepatocyte-targeted delivery of curcumin. Carbohydr. Polym. 2013, 94, 420–429. [Google Scholar] [CrossRef] [PubMed]
- de Carvalho, L.S.F.; Nogueira, A.C.C.; Bonilha, I.; Luchiari, B.; Benchimol, A.; Couri, C.E.B.; Borges, J.L.; Barreto, J.; Sposito, A.C. Glucose-Lowering and the Risk of Cardiovascular Events with Antidiabetic Therapies: A Systematic Review and Additive-Effects Network Meta-Analysis. Front. Cardiovasc. Med. 2022, 9, 876795. [Google Scholar] [CrossRef] [PubMed] [PubMed Central]
- Zubia-Aranburu, J.; Buruaga, L.; Martin-Inaraja, M.; Rodriguez, C.; Santos, S.; Silván, U.; Eguizabal, C.; Zabala, A. Towards tailored surface topography on electrospun wound dressings for exudate absorption. Surf. Innov. 2024, 12, 252–264. [Google Scholar] [CrossRef]
- Martins, J.G.; Camargo, S.E.A.; Popat, K.C.; Kipper, M.J.; Martins, A.F. Pectin-chitosan membrane scaffold imparts controlled stem cell adhesion and proliferation. Carbohydr. Polym. 2018, 197, 47–56. [Google Scholar] [CrossRef] [PubMed]
- Martins, A.F.; Vlcek, J.; Wigmosta, T.; Hedayati, M.; Reynolds, M.M.; Popat, K.C.; Kipper, M.J. Chitosan/iota-carrageenan and chitosan/pectin polyelectrolyte multilayer scaffolds with antiadhesive and bactericidal properties. Appl. Surf. Sci. 2019, 502, 144282. [Google Scholar] [CrossRef]
- Plath, A.M.S.; Facchi, S.P.; Souza, P.R.; Sabino, R.M.; Corradini, E.; Muniz, E.C.; Popat, K.C.; Kipper, M.J.; Martins, A.F. Zein supports scaffolding capacity toward mammalian cells and bactericidal and antiadhesive properties on poly(ε-caprolactone)/zein electrospun fibers. Mater. Today Chem. 2021, 20, 100465. [Google Scholar] [CrossRef]
- Gashti, M.P.; Farch, S.; Gashti, M.P.; Pousti, M.; Pakdel, E.; Martins, A.F.; Siam, K. Plasma-assisted hydroxyapatite/chitosan bionanocomposite films with improved thermal stability, biomineralization and optical absorption properties. ChemNanoMat 2025, 11, e202400577. [Google Scholar] [CrossRef]
Disclaimer/Publisher’s Note: The statements, opinions and data contained in all publications are solely those of the individual author(s) and contributor(s) and not of MDPI and/or the editor(s). MDPI and/or the editor(s) disclaim responsibility for any injury to people or property resulting from any ideas, methods, instructions or products referred to in the content. |
© 2025 by the authors. Licensee MDPI, Basel, Switzerland. This article is an open access article distributed under the terms and conditions of the Creative Commons Attribution (CC BY) license (https://creativecommons.org/licenses/by/4.0/).